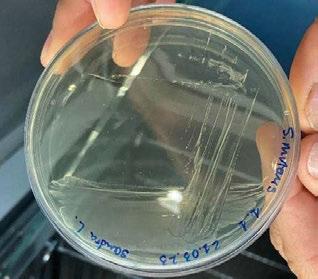
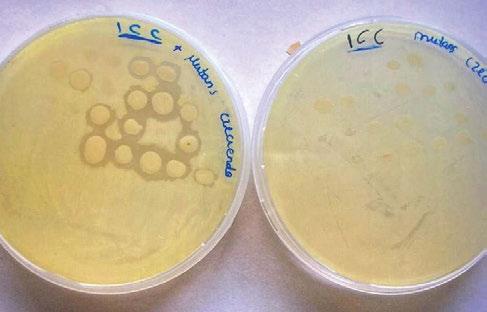

Núm. 366 Mayo 2024 | 6,50€ gacetadental.com

Hipoplasia mandibular
Tratamiento interceptivo precoz
Recursos Humanos Claves para reducir el absentismo laboral en la consulta
Odontopediatría Manifestaciones clínicas de los pacientes asmáticos
Scanbodies
Cómo influyen en la calidad final de las restauraciones
Núm. 366 Mayo 2024 | 6,50€ gacetadental.com

Hipoplasia mandibular
Tratamiento interceptivo precoz
Recursos Humanos Claves para reducir el absentismo laboral en la consulta
Odontopediatría Manifestaciones clínicas de los pacientes asmáticos
Scanbodies
Cómo influyen en la calidad final de las restauraciones









DESCUBRE LA GAMA COMPLETA DE BLANQUEAMIENTOS DE NORMON DENTAL















CLÍNICA



Productos sanitarios*




35% de Peróxido de hidrógeno.









Norblanc Office Automix 37,5% de Peróxido de hidrógeno.



DOMICILIARIO

Cosméticos**






Norblanc Home 16% de peróxido de carbamida (36 jeringas).



Norblanc Home 16% de peróxido de carbamida (4 jeringas).


Material destinado exclusivamente a profesionales sanitarios. * Este producto sanitario puede tener contraindicaciones y/o efectos adversos. Lea detenidamente las instrucciones de uso antes de su utilización. De conformidad con la legislación vigente de productos sanitarios. ** El primer uso estará restringido a odontólogos o tendrá lugar bajo su supervisión directa, siempre que se garantice un grado de seguridad equivalente. Posteriormente se entregará al paciente junto con las instrucciones de uso para que complete el ciclo en casa. Venta exclusiva a odontólogos. No utilizar en menores de 18 años.

Norblanc Home 10% de peróxido de carbamida (4 jeringas).

VA-02-PF-NORBLA-MD-03.2023-1.3








Desde el laboratorio Ávila Mañas
todos nuestros
la mejor calidad
Sabemos que la calidad, seriedad y garantía tienen precio Avila Mañas. Advanced Aesthetics & Fundation | C/ Ramón Calabuig 57, 28053-Madrid. Spain Tel.: +34 91 478 21 83 | Fax: +34 91 477 77 16 labavila@avilam.com | www.avilam.com ESTRUCTURA CAD-CAM FRESADA ESTRUCTURA FRESADA CAD-CAM CON CERÁMICA PERSONALIZADA CIRCONIO CERÁMICA PERSONALIZADA CIRCONIO CERÁMICA SOBRE IMPLANTES CARILLAS PERSONALIZADAS CORONAS E-MAX CAD-CAM FRESADAS CORONAS INDIVIDUALES E-MAX CAD-CAM
S.L.
esfuerzos van dirigidos a garantizar
y no el precio más bajo.
Núm. 366 Mayo 2024 | 6,50€ gacetadental.com

La lucha sin fin
Carta abierta
Hipoplasia mandibular
Tratamiento interceptivo precoz
Recursos Humanos
Claves para reducir el absentismo laboral en la consulta
Hace unos días disfrutaba de un agradable «tardeo-terraceo» con un dentista y gran parte de nuestra conversación giró, como no podía ser de otra manera, en torno a la profesión y el sector. ¿Y las especialidades para cuándo? Ese podría ser uno de los principales titulares del encuentro. Recordaba a mi compañero de charla mi aterrizaje un tanto forzoso en Gaceta Dental, y cómo desde ese septiembre de 2010 empecé a oír hablar de las «especialidades oficiales odontológicas», la «denuncia» de su inexistencia en España y la demanda a gritos del sector por crearlas a la mayor brevedad posible. De esto han pasado casi catorce años y, aunque ha habido momentos en que parecía que podían ver la luz, aún nuestra Odontología, nuestros profesionales y nuestros pacientes siguen sin ellas. Me consta que han sido muchos los intentos y muchos los esfuerzos de las instituciones y organizaciones del sector por conseguirlas, como hemos ido puntualmente informando en GD. En julio de 2022, el Consejo de Ministros, tras una década «aparcado», aprobaba el RD de Especialidades en Ciencias de la Salud, un texto que desde el principio
generó desconfianza por estar más enfocado a los médicos dejando al margen otras profesiones sanitarias.
Las organizaciones del sector, lógicamente, no tiran la toalla en su lucha por conseguir esta reivindicación. En este número, verás que el Consejo de Dentistas, la Universidad española y las sociedades científicas AEDE, SEPA, SECIB, SEOP, SEDO y SEPES han enviado a las administraciones autonómicas un documento que analiza cómo llevar a cabo técnica y económicamente el proyecto de creación de las especialidades odontológicas.
Odontopediatría
Manifestaciones clínicas de los pacientes asmáticos
La petición plantea un formato de escuela tipo MIR y analiza las normas de acceso, el número de profesionales, los recursos asistenciales disponibles y el presupuesto para su puesta en marcha. Por el momento, ya han recibido varios apoyos autonómicos y el siguiente paso será tocar la puerta del Ministerio de Educación. Esperemos que este nuevo intento sea el definitivo y que, por fin, los dentistas españoles equiparen sus derechos a los de sus colegas europeos, un derecho cuyo alcance afecta a todos. Los pacientes, también.
Scanbodies
Gema Bonache
Directora de Gaceta Dental
Cómo influyen en la calidad final de las restauraciones
La lucha sin fin CARTA ABIERTA
Gaceta Dental · N o 366 | Mayo 2024
Índice de anunciantes
4 ÍNDICE DE ANUNCIANTES. Gaceta Dental 366
ACTEON 105 AGUILERA DENTAL 89 ÁVILA MAÑAS Int. Portada BAMBACH 47 BEGO 37 BIOINNNOVACIÓN DENTAL 25 BTI 9 BUKORENT 99 CEU - UNIVERSIDAD CARDENAL HERRERA 125 CLÍNIQUES UV 139 CLUB DE SOCIOS 121 EXPADENT 51 FLUOCARIL 91 GC 81 GECKO 109 HEXA3DENTAL 145 I2 IMPLANTOLOGÍA 65 INSTITUTO IDEOD 113 IPG DENTAL 61 IVOCLAR Int. Contraportada KIYOMI DENTAL 157 KURARAY NORITAKE 17 MANUEL ROMÁN ACADEMY 87 MASTER DENTAL 133 NORMON Solap a Portada NSK Desp l. Contraportada ORTHODEPOT 137 ORTOPLUS 5 y 163 OSSTEM 71 OSTEÓGENOS 161 PECKET 149 RENFERT 21 RUMAR 11 SDI 93 SEPES 151 SMART IMPLANT SOLUTIONS 129 STERICYCLE 141 TICARE 7 ULTRADENT 131 UNIV. COMPLUTENSE DE MADRID - UCM 169 VITA 152-153-154 y Contraportada VÍTTREA 159 VOCO 147 WOLF - DISEÑO & REFORMAS 143 ENCARTE SUELTO SEPES Gaceta Dental · N o 366 | Mayo 2024

Férula de Descarga
Digital de Nylon
Escanea el código QR para descargar el catálogo completo
La primera Férula de Descarga para tratar a pacientes con bruxismo y problemas de la ATM utilizando la tecnología más avanzada en impresión 3D.













Tecnología CAD/CAM para una óptima precisión y adaptación de la férula
Dr. Eduardo Vázquez


Fabricada en Poliamida 12 con certificado en biocompatibilidad Clase IIa

Ligera, cómoda y con una alta resistencia al desgaste y a las fuerzas de la boca
(+34) 952 212 174info@ortoplus.es
Curso Intensivo de Férulas de Descarga
ortoplus.es Reserva tu plaza
Málaga 8 de junio 2024
Ciencia y clínica
–Hipoplasia mandibular. Tratamiento interceptivo precoz. A propósito de un caso, por el Dr. Luis Fernando Morales. [18]
–Rehabilitación 100% digital: desde la planificación a la carga. A propósito de un caso, por el Dr. Carlos León Pérez. [30]
–Pacientes asmáticos en Odontopediatría (y II), por María Flórez Mora y cols. [42]
–Magnificación en Odontología restauradora. «Solo podemos tratar lo que podemos ver», por el Dr. Jesús Ostos. (Informe). [56]
SUMARIO
Carta abierta
3
Protagonistas
Dres. Francisco Sánchez y Ricardo López
Presidente y secretario, respectivamente, de la Sociedad de Odontología Digital Andaluza (SODA).


«La lucha sin fin», por Gema Bonache, directora de Gaceta Dental.

96 18
62
Digital al día
Carga inmediata con prótesis prefabricada y protocolos Di2gitalArch®. Caso bimaxilar con implantes yuxtaóseos y convencionales, por el Dr. Luis Cuadrado de Vicente.
6 Gaceta Dental · N o 366 | Mayo 2024 SUMARIO







Cómo reducir el absentismo laboral en las clínicas dentales. Estrategias para maximizar el potencial profesional y alcanzar un éxito sostenible, por Sofía Solano Mendoza.
la última


Y además...
Qué leer. Últimas tendencias: 10 títulos imprescindibles para el profesional dental 12
Informe. La solución de restauración SmART. Una serie de casos, por el Dr. Khaled Aly Nour 72
Higiene. Streptococcus dentisani. Actualización sobre nuevas investigaciones, por Paula Albalat Comeche 82
Salud mental en la clínica dental: psicología de pacientes y dentistas.
Rincón digital
Scanbodies: la impresión digital llega a la Implantología, por el Dr. Giuliano Fragola.
GDentalk
Noticias 8 Gaceta Dental · N o 366 | Mayo 2024 SUMARIO
RR.HH
en la clínica
A
102 110 118 126 136
Productos 164 Agenda 167 Calendario de congresos 178
Clínica Kreo


SOLUCIONES MÍNIMAMENTE INVASIVAS
IMPLANTES CORTOS
(HASTA 4,5 MM)


Plataformas: Estrecha y 3.0

DESCÚBRELOS

REPLANTÉATE LOS TRATAMIENTOS DE LAS ATROFIAS ÓSEAS
POR 3 RAZONES:
1. Menor traumatismo: sin reconstrucciones complejas.
2. Más éxito sin complicaciones postoperatorias.
3. Mayor aceptación por parte del paciente: sin demoras en la rehabilitación y aumentos de costes.

BTI Biotechnology Institute Tel: (+34) 945 140 024 | bti-biotechnologyinstitute.es
Ciencia y experiencia
7,5mm. 6,5mm. 5,5mm. 4,5mm.
EDITA
Peldaño
DIRECTORA
Gema Bonache gbonache@gacetadental.com
PUBLICIDAD
Ana Santamaría
Directora de ventas ana@gacetadental.com
Marta Pérez marta@gacetadental.com
Manuela Bino i mbinotti@gacetadental.com
JEFE DE PRODUCCIÓN
Miguel Fariñas
OFICINAS Y REDACCIÓN
Avda. Manzanares, 196 28026 Madrid 91 476 80 00
HEAD OF DESIGN
Juan Luis Cachadiña
COPYWRITER
Sandra Rodríguez srodriguez@gacetadental.com
DISEÑO Y MAQUETACIÓN
Débora Martín Cristina Corchuelo
IMPRIME mccgraphics
Txirrita-Maleo Biribil, 11 20100 Errenteria, Gipuzkoa
REDACTORA
Patricia Merino pmerino@gacetadental.com
TIENDA GD
Francisco Soriano paco@gacetadental.com
Jorge Cacuango jorge@gacetadental.com
¡SÍGUENOS EN LAS REDES!









SUSCRIPCIONES Y DISTRIBUCIÓN
Remedios García Laura López suscripciones@peldano.com 902 35 40 45
DEPÓSITO LEGAL M.35.236-1989 ISSN 1135-2949
CONSEJO DE INNOVACIÓN Y EXCELENCIA
CIENCIA Y CLÍNICA: Dr. José Aranguren, Dra. Estefanía Laguna, Dr. Juan López-Quiles, Dra. Estefanía Moreno, Dr. Jesús Peláez Rico, Dr. Luis Segura-Mori · FORMACIÓN Y CONOCIMIENTO: Dr.Juan Carlos Vara, Dra. María José Muñoz, Dr. Simón Pardiñas · TECNOLOGÍA E INNOVACIÓN: Dr. Luis Cuadrado de Vicente, Dra. Irene García
INTERNACIONAL: Dr. Joao Caramés, Dr. Cristian Abad
Presidente: Ignacio Rojas · Global Manager: Julios Ros ·Director Financiero y de Talento: Daniel R. Villarraso
Director de Marca y Estrategia: Eneko Rojas · Director de Estrategia de Contenidos: Adrián Beloki
Directora de Estrategia Digital Comercial: María Rojas · Directora de Marketing: Miriam Egea
Business Unit Manager: María Muñoz · Chief Digital O icer: Pau Colás

Los artículos científicos y clínicos que se publican en Gaceta Dental son supervisados por un grupo de expertos en las distintas ramas de la Odontología. Gaceta Dental no se identifica necesariamente con las opiniones expresadas libremente en sus páginas por los colaboradores.
Publicación autorizada por el Ministerio de Sanidad como soporte válido. Ref: S.V 89057 R. Premio aeepp a la mejor revista de 2008 | 1er Accesit al Mejor Editor, años 2004 y 2007 | Premio «Pro-Odontología» de la Sociedad Catalana de Odontología y Estomatología (scoe) 2009 | Premio «Fomento de la Salud» del Consejo General, 2005 | Premio del Colegio de Protésicos de la Comunidad de Madrid a la Trayectoria Profesional 2009 | Insignia de oro Colegial del COEM 2013. AVISO LEGAL Y TRATAMIENTO DE DATOS
La opinión de los artículos publicados no es compartida necesariamente por la revista, y la responsabilidad de los mismos recae, exclusivamente, sobre sus autores. Cualquier forma de reproducción, distribución, comunicación pública o transformación de esta obra solo puede ser realizada con la autorización de sus titulares, salvo excepción prevista por la ley, y en el caso de hacer referencia a dicha fuente, deberá a tal fin ser mencionada GACETA DENTAL editada por Peldaño, en reconocimiento de los derechos regulados en la Ley de Propiedad Intelectual vigente, que como editor de la presente publicación impresa le asisten. Los archivos no deben modificarse de ninguna manera. Diríjase a CEDRO (Centro Español de Derechos Reprográficos) si necesita fotocopiar o escanear algún fragmento de esta obra (www.conlicencia.com / 917 021 970 / 932 720 445). De conformidad con lo dispuesto en el Reglamento (UE) 2016/679 del Parlamento Europeo y del Consejo, de 27 de abril de 2016, relativo a la protección de las personas físicas en lo que respecta al tratamiento de datos personales y a la libre circulación de estos datos y por el que se deroga la Directiva 95/46/CE, y de conformidad con la legislación nacional aplicable en materia de protección de datos, le recordamos que sus datos están incorporados en la base de datos de PELDAÑO MEDIA GROUP, S. L., como Responsable de Tratamiento de los mismos, y que serán tratados en observancia de las obligaciones y medidas de seguridad requeridas, con la finalidad de gestionar los envíos en formato papel y/o digital de la revista, de información sobre novedades y productos relacionados con el sector, así como poder trasladarle, a través nuestro o de otras entidades, publicidad y ofertas que pudieran ser de su interés, de conformidad con el consentimiento prestado al solicitar su suscripción expresa y voluntaria a la misma, cuya renovación podrá ser requerida por Ediciones Peldaño en cumplimiento del citado Reglamento. Le informamos que podrá revocar dicho consentimiento, en cualquier momento y en ejercicio legítimo de los derechos de acceso, rectificación, cancelación, oposición, portabilidad y olvido, dirigiéndose a PELDAÑO MEDIA GROUP, S. L., Avda. Manzanares, 196. 28026 Madrid, o al correo electrónico distribucion@peldano.com.
Gaceta Dental · N o 366 | Mayo 2024 10 STAFF
Hipoplasia mandibular Tratamiento interceptivo precoz Recursos Humanos Claves para reducir el absentismo Odontopediatría Manifestaciones clínicas de los pacientes asmáticos Scanbodies Cómo influyen en la calidad SUSCRIPCIÓN 1 AÑO SUSCRIPCIÓN 2 AÑOS 50€ 87€ 124€ España Europa Resto 87€ 152€ 194€ España Europa Resto
GACETADENTAL.COM ACCEDE A LOS DATOS DE SUSCRIPCIÓN
Foto: Ramón Gómez Meda
19 años al servicio de distribuidores y servicios técnicos dentales
20 años al servicio de distribuidores y servicios técnicos dentales
Sistema de Obturación + Sistema de Inyección Eléctrico 3D GUTAPERCHA
CALIENTA, CORTA Y CONDENSA gutapercha en el conducto radicular durante los tratamientos de endodoncia.
SISTEMA DE INYECCIÓN 3D de gutapercha, velocidad de inyección constante sin residuos, mermas o limpiezas.

Descubre todas las novedades de
y mucho más...
¡Siempre en stock, entrega en 24 horas!
www.rumarcedeira.com | rumarcedeira@rumarcedeira.com
Teléfono: 91 849 01 04 | WhatsApp: 683 157 441


Pregúntanos por tu distribuidor o servicio técnico más cercano
IMPORTADOR MAYORISTA PARA LA PENÍNSULA IBÉRICA
ENDODONCIA
Qué leer

Últimas tendencias: 10 títulos imprescindibles para el profesional dental
Para que puedas estar al día en Odontología, desde la Tienda GD te presentamos una vista previa de los 10 títulos imprescindibles del sector. Estos títulos, de reciente publicación, nos ofrecen desde técnicas quirúrgicas de vanguardia hasta avances en Odontopediatría. ¡Hazte con ellos en nuestra web!
12
Gaceta Dental · N o 366 | Mayo 2024
Freepik/Artursafronovvvv.
QUÉ LEER. 10 títulos imprescindibles
Descubre nuestra selección exclusiva de libros especializados en Odontología y no te pierdas esta oportunidad única de estar al tanto de las últimas tendencias y desarrollos e n el sector
1. MANUAL DE ORTODONCIA CLÍNICA. TOMO 1

El Dr. Luis Fernando Morales nos presenta su último trabajo: «Manual de Ortodoncia Clínica. Tomo 1». En este volumen, el Dr. Morales ha logrado un equilibrio entre los principios de Ortodoncia fundamentales y las tecnologías de vanguardia, ofreciendo una obra que integra cuidadosamente las raíces clásicas con las innovaciones actuales que definen la ortodoncia contemporánea.
A lo largo de sus páginas, el autor se ha propuesto acercarse al profesional de una manera práctica y accesible, abordando los desafíos cotidianos que enfrenta en su práctica clínica y presentando soluciones simples y efectivas. El enfoque amigable y comprensible del libro evita la rigidez técnica típica de los tratados académicos, optando por una estructura de manual que facilita la comprensión y aplicación de los conceptos.
2. OCLUSIÓN Y PRÓTESIS SOBRE IMPLANTES

La compleja relación entre la oclusión y los implantes dentales se aborda de manera magistral en la obra del Dr. Maxi Cacciacane García, «Oclusión y Prótesis sobre Implantes».
En la publicación se destacan tres aspectos clave. El primero es el enfoque didáctico, diseñado para que tanto estudiantes como profesionales experimentados puedan comprender los conceptos con facilidad. El segundo punto es la integralidad teórica y práctica, ya que se equilibra la teoría con la práctica, ofreciendo una sólida base en los principios teóricos de la oclusión y los implantes, así como numerosos casos clínicos detallados.
El último aspecto a destacar es la inclusión de numerosos casos clínicos que proporcionan ejemplos concretos de cómo abordar diferentes situaciones, permitiendo a los lectores aprender de experiencias reales y obtener una visión completa de los procedimientos.
TU LIBRO DIGITAL ¡YA DISPONIBLE!
En la Tienda Gaceta Dental hemos ampliado nuestra oferta para brindarte una experiencia de lectura más versátil y accesible. Ahora tienes la opción de adquirir tus libros preferidos en formato digital o en formato impreso, gracias al nuevo botón de compra que hemos agregado en nuestra página web.
Esta opción no solo ofrece comodidad, sino también una alternativa más económica para quienes prefieren el formato digital. Además, destacamos que los libros digitales no solo pueden visualizarse a través de la aplicación web, sino que también puedes descargártelos en tus dispositivos móviles y tabletas, brindando así una experiencia de lectura óptima en cualquier plataforma.
13
10 títulos imprescindibles. QUÉ LEER Gaceta Dental · N o 366 | Mayo 2024
3. CASOS CLÍNICOS
EN ODONTOPEDIATRÍA

Concebida como una guía indispensable para los profesionales de la Odontología que se enfrentan a casos de Odontopediatría en su práctica diaria, esta obra, escrita por el equipo del Dr. Boj, marca un hito al abordar de manera exhaustiva y práctica los diferentes aspectos de esta especialidad. Lo más destacado de esta obra es su enfoque didáctico y fácil de leer. Dividida en secciones que abarcan los aspectos fundamentales de la Odontopediatría, cada apartado se enfoca en casos clínicos específicos, proporcionando orientación detallada sobre cómo abordar cada situación. A través de fotos reales y detalladas, los lectores pueden visualizar los casos y aprender los enfoques más efectivos para su manejo.
4. MEJORA DE LA ESTÉTICA Y LA FUNCIÓN EN ODONTOLOGÍA.
CASOS CLÍNICOS

En el campo de la Odontología moderna, la integración de la estética y de la funcionalidad es más crucial que nunca para garantizar el éxito de cualquier tratamiento de rehabilitación. Es por eso que la formación continua en esta área es de suma importancia. El libro «Mejora de la Estética y la Función en Odontología. Casos
Clínicos», escrito por el Dr. Juan Manuel Aragoneses, aborda este desafío de manera magistral. A través de una variedad de casos clínicos, la publicación explora la rehabilitación oral desde diversas especialidades odontológicas, ofreciendo una visión completa desde la planificación hasta la resolución de casos complejos. Con más de una veintena de autores contribuyendo a los diferentes capítulos, este libro ofrece una perspectiva variada e innovadora sobre la rehabilitación oral.
5. MEDICINA BUCAL CONTEMPORÁNEA

Han pasado doce años desde la primera publicación de «Esquemas de Medicina Bucal», y ahora los Dres. Chimenos Kustner y José López López nos presentan una nueva edición, renovada y ampliada. Su propósito: proporcionar a los lectores una visión clínica completa de los aspectos médicos más relevantes en el ámbito odontoestomatológico. Con abundantes tablas y fotos ilustrativas, esta obra reúne todas las patologías de la Medicina Bucal en un solo volumen, manteniendo su carácter práctico y utilitario como guía para el manejo de una amplia gama de condiciones orales. Con la participación de 24 autores especialistas en diversas disciplinas médicas, este libro ofrece una riqueza de conocimientos y experiencias que abarcan desde la detección y diagnóstico hasta el tratamiento de enfermedades bucales.
14
Dental · N o 366 | Mayo 2024 QUÉ LEER. 10 títulos imprescindibles
Gaceta
«En la Tienda Gaceta Dental hemos ampliado nuestra oferta para brindarte una experiencia de lectura más versátil y accesible»
6. PRINCIPIOS Y BIOMECÁNICA DEL TRATAMIENTO CON ALINEADORES

Explora la vanguardia de la Ortodoncia contemporánea con «Principios y Biomecánica del Tratamiento con Alineadores», una obra esencial que ofrece una comprensión profunda y actualizada de los alineadores transparentes. Este libro, redactado por reconocidos expertos en Ortodoncia como Ravindra Nanda, Tommaso Castroflorio, Francesco Garino y Kenji Ojima, brinda una visión detallada sobre cómo emplear eficazmente estos dispositivos para abordar una amplia gama de maloclusiones.
A lo largo de sus meticulosos capítulos, los autores exploran los aspectos fundamentales del tratamiento con alineadores, desde la planificación inicial hasta la retención y estabilidad posterior al tratamiento. Con un enfoque basado en la evidencia científica más reciente, este libro proporciona valiosos conocimientos sobre diagnóstico tridimensional, principios
biomecánicos, características de los materiales y consideraciones prácticas en la planificación del tratamiento.
7. ALVEOLO POSTEXTRACCIÓN,
¿CICATRIZACIÓN O REGENERACIÓN? TERAPÉUTICA Y USO DE PRGF–ENDORET®

El libro del Dr. Anitua representa un hito en la regeneración tisular mediante el innovador uso del PRGFEndoret en la cirugía oral. Este procedimiento, fruto de años de investigación, ha logrado de manera biológica regenerar los defectos dejados por los alveolos postextracción, abriendo nuevas puertas en el campo de la Odontología regenerativa.
El libro profundiza en las bases biológicas de la regeneración del alveolo postextracción, así como en los procedimientos de extracción dental y su manejo. Destaca especialmente el protocolo de uso del PRGF-Endoret en la extracción dental, detallando su secuencia y aplicación en diferentes contextos odontológicos.
8. ODONTOLOGÍA RESTAURADORA BIOMIMÉTICA
(2 VOL.)

El libro, escrito por Pascal Magne, representa un avance significativo en la ciencia de la reconstrucción dental estética, proporcionando una guía completa tanto para el
15
Gaceta Dental · N o 366 | Mayo 2024 10
LEER
títulos imprescindibles. QUÉ
¡CONSIGUE TU LIBRO EN LA TIENDA GD! QUÉ
ámbito clínico como académico. Desde los fundamentos hasta las técnicas más avanzadas, aborda todos los aspectos que un profesional podría necesitar, desde la preparación dental hasta los procedimientos de laboratorio y CAD/ CAM, la cementación adhesiva y el mantenimiento. Su singularidad radica en el principio subyacente de Pascal Magne: respetar la estructura natural del diente como guía principal en la restauración, fundamentado en la filosofía biomimética.
9. ODONTOPEDIATRÍA DE LA GESTANTE AL BEBÉ:
ENFOQUE TRANSDISCIPLINARIO EN EL ARTE DE CUIDAR

La Dra. Jenny Abanto y su equipo de colaboradores nos presentan una obra exhaustiva que aborda todos los aspectos relevantes de la Odontología para bebés, desde la prevención hasta la rehabilitación. Este libro es una verdadera joya para dentistas y odontopediatras, ya que ofrece una visión completa de los principales problemas de salud bucodental en la infancia, respaldada por la experiencia de especialistas de diversas áreas de la salud.
Con más de 1.250 imágenes detalladas distribuidas en más de 800 páginas, esta obra se convierte en una herramienta de consulta y formación imprescindible. La Dra. Abanto marca con este libro un hito al adoptar un enfoque multidisciplinario y transdisciplinario, con la colaboración de expertos en diversas áreas de la salud maternoinfantil, incluyendo pediatras,
logopedas, psicólogas, ginecólogos y fisioterapeutas.
10.
DIRECT. CARILLAS EN RESINAS COMPUESTAS

Si estás buscando aprovechar al máximo la versatilidad de las carillas de resinas compuestas, este libro, escrito por los Dres. Jorge Eustáquio y Rafael Calixto, es una lectura imprescindible. Se trata de la publicación más completa y actualizada en el tema, ofreciendo información valiosa respaldada por casos clínicos desarrollados por más de una veintena de especialistas.
Con su enfoque práctico, se presenta como una herramienta esencial tanto para estudiantes como para profesionales en la práctica clínica. Proporciona una guía detallada sobre el uso de las resinas compuestas para la rehabilitación estética de la sonrisa, abordando todos los aspectos clave de esta innovadora técnica. ●
16
LEER. 10 títulos
Gaceta Dental · N o 366 | Mayo 2024
imprescindibles





















CLEARFIL MAJESTY ™ ES-2
Linea Universal
IN JAPAN





















La Tecnología de Difusión de la Luz (LDT) de Kuraray Noritake Dental, aplicada a los rellenos del composite CLEARFIL MAJESTY™ ES-2 Universal, permiten alcanzar la integración estética con un solo color, tanto por las restauraciones como por las anteriores.


Color para restauraciones posteriores


Opciones de color para las restauraciones anteriores





Ninguna masa para bloquear la luz
La tecnología de los rellenos con elevado índice de difusión de la luz permite la integración óptica con los tejidos naturales circundantes, actuando sobre el control de translucidez y opacidad. Crea bonitas restauraciones con pocos colores y un procedimiento simplificado gracias a nuestra tecnología avanzada.
Kuraray Europe Spain S.L. Avda. del Tivoli, C.C. „Las Ventas“, Local 37 y 38 - 29631 Arroyo de la Miel (Benalmádena), Málaga
Teléfono: 0039 02 63471228 - 0034 634453983
Correo Electrónico: dental-iberia@kuraray.com Web: www.kuraraynoritake.eu/es





BORN
LA SIMPLIFICACIÓN INTELIGENTE
Comunicación
reservada
al personal sanitario.
PARA SABER MÁS, ESCANEE EL CÓDIGO QR:
A propósito de un caso
Ciencia y clínica Hipoplasia mandibular. Tratamiento interceptivo precoz
INTRODUCCIÓN
Después de las maloclusiones de Clase I, los síndromes de Clase II son los que presentan mayor prevalencia (1), generando en nuestras consultas más de la mitad de los tratamientos de ortodoncia (2).

DR. LUIS FERNANDO MORALES JIMÉNEZ
Director académico del Máster de Ortodoncia Clínica y Ortopedia Dentofacial de PgO UCAM. Sedes: Málaga y Almería.
La distoclusión dentaria suele acompañarse de la posición adelantada del maxilar y/o retrasada de la mandíbula con respecto a las estructuras de la base del cráneo. El diagnóstico y tratamiento en el momento oportuno, tanto de una protrusión o una hiperplasia maxilar como de un retrognatismo o una hipoplasia mandibular, no solo mejora el aspecto facial y el problema maloclusivo del paciente, sino que, además, en numerosas ocasiones, le evita someterse en la etapa adulta a una intervención de cirugía ortognática (la mayoría de las veces rechazada) o a un camuflaje ortodóncico que, en escasas ocasiones, cumple con sus expectativas estéticas.
Afortunadamente, y gracias a los Programas de Salud Bucodental
de las distintas CC. AA. de nuestro país, los niños acuden a una edad más temprana a las consultas de Odontología, siendo diagnosticados precozmente de su descoordinación ósea y de su maloclusión, pudiendo así acceder en tiempo y forma a un tratamiento interceptivo de ortopedia.
En este artículo se describe el caso de una niña de 9/2 años con síndrome de Clase II por hipoplasia mandibular que recibió tratamiento en dos fases: una primera, ortopédica, para estimular el crecimiento mandibular mediante aparatología funcional; y una segunda fase, ortodóncica, con la colocación de brackets de autoligado pasivo de la técnica USS (Universal Smile System) de prescripción variable para el desarrollo y coordinación de las arcadas dentarias.
MATERIAL Y MÉTODOS
El diagnóstico de la niña se conformó basándose en la exploración extra e intraoral (con la toma de las
18 Gaceta Dental · N o 366 | Mayo 2024 CIENCIA Y CLÍNICA. Caso clínico
«Después de las maloclusiones de Clase I, los síndromes de Clase II son los que presentan mayor prevalencia, generando en nuestras consultas más de la mitad de los tratamientos de ortodoncia»



fotografías pertinentes), así como en la recogida de registros iniciales (impresiones para modelos de estudio, ortopantomografía y telerradiografía lateral de cráneo). Se estableció una planificación y secuencia de tratamiento.
El diagnóstico reveló una Clase II ósea y dentaria, con hipoplasia mandibular, estando indicada la colocación de un aparato funcional por los motivos detallados más adelante.
El aparato funcional con el que se realizó el primer avance mandibular fue un Bionator (3-5), que consta de dos cuerpos de acrílico, superior e inferior, adaptados a las arcadas dentarias y unidos en un solo bloque mediante la mordida constructiva. En el sector anterior el acrílico se extiende hasta el 1/3 incisal por vestibular para evitar la disminución del resalte por la protrusión de los incisivos inferiores. El arco vestibular continúa hacia los sectores laterales configurando las asas buccinatorias, que al disponerse separadas 1-2 mm del tejido dentario y gingival restringen el componente de fuerza externa de los músculos buccinatorios.
El segundo avance mandibular se realizó con un Twin Block (6,7), que consta de dos bloques de acrílico, uno en la arcada superior y otro en la inferior, que se solapan entre sí cuando el paciente ocluye, mediante unos planos inclinados de resina que provocan el avance mandibular y transmiten fuerzas favorables a los planos inclinados oclusales que cubren a los dientes posteriores.
Los planos inclinados forman un ángulo de 70 º con el plano oclusal; con esta inclinación, aun en posición de reposo, la mandíbula se mantiene en posición adelantada,
19 Gaceta Dental · N o 366 | Mayo 2024 Caso clínico. CIENCIA Y CLÍNICA
Figuras 1-3.
«La ortopedia dentofacial como tratamiento interceptivo en el inicio y en el pico de máximo crecimiento puberal ha sido muy satisfactoria en la estimulación del avance y/o crecimiento mandibular»
que es el estímulo favorable para el crecimiento condilar y la remodelación de la fosa glenoidea.
Tras la terminación de la fase ortopédica, se continuó con la colocación de los brackets

mencionados anteriormente. La prescripción de estos fue de alto torque en los incisivos superiores y en los cuatro caninos, y de bajo en los incisivos inferiores. Tras 12 meses desde la colocación de los brackets y una vez conseguida la normalización de las relaciones oclusales, se colocaron unos retenedores fijos de canino a canino en ambas arcadas de acero trenzado de 6 hilos (.017” superior y .019” inferior) y un guarda de contención nocturna hasta la terminación del crecimiento puberal.
RESULTADOS
La niña de las figuras 1 a 3 presenta una leve asimetría facial con patrón braquifacial por tercio inferior disminuido y mentón desviado ligeramente hacia la derecha; los labios son competentes y en sonrisa apenas se exponen los incisivos. El perfil es excesivamente convexo,



 Figuras 4-8.
Figuras 4-8.
20 Gaceta Dental · N o 366 | Mayo 2024 CIENCIA Y CLÍNICA. Caso clínico

Bionic Hair
Durabilidad excepcional y comportamiento natural





El pincel para cerámica lay:art evo establece un nuevo estándar. La fibra biónica recién diseñada reúne todas las ventajas de los pinceles de pelo sintético y natural y destaca por su extraordinaria durabilidad. Gracias a la absorción óptima de la humedad y a la composición química especial de sus fibras se consiguen resultados de estratificación excellentes.
Descúbralo ahora www.renfert.com/evo


making work easy
lay:art evo
con escasa proyección del mentón, y con los ángulos de la convexidad (155 º) y mentolabial (70 º) disminuidos y el nasolabial (103 º) en norma.
La exploración intraoral (figuras 4 a 8) revela una Clase II molar y canina completa, líneas 1/2 dentarias superior 0,5 mm e inferior 1 mm ambas desviadas hacia la derecha, los incisivos superiores excesivamente protruidos y vestibulizados (seguramente debido a la interposición del labio inferior), resalte de 13 mm y sobremordida 2/3 de corona. La discrepancia oseodentaria
inferior es de -3,5 mm y la curva de Spee de 4 mm.
En la ortopantomografía se aprecia una dentición permanente a falta de la erupción de los 2os y 3 os molares, así como una asimetría ósea con rama y cóndilo mandibular izquierdo menos desarrollado (figura 9), causante de la asimetría facial descrita anteriormente.
El estudio cefalométrico (figura 10) revela una Clase II esquelética por hipoplasia mandibular, patrón braquifacial e incisivos superiores muy protruidos (14,9 mm) y



22 Gaceta Dental · N o 366 | Mayo 2024 CIENCIA Y CLÍNICA. Caso clínico
Figuras 9-11.
vestibulizados (52º), e inferiores lingualizados (16 º). El perfil es extremadamente convexo.
Según lo descrito, y por la edad de la niña y su excesivo resalte, el tratamiento ortopédico inicial consistió en realizar el estímulo del avance mandibular en dos fases.
Se aconsejó en la primera fase colocar un Bionator modificado con recubrimiento de acrílico en los incisivos inferiores para evitar su protrusión y la consiguiente disminución del resalte (figura 11).
Transcurridos 7 meses, se sustituyó por un Twin Block para un segundo y definitivo avance (figuras 12 a 16).
A fin de mejorar el patrón facial y


permitir la erupción de los molares inferiores (estos molares no deben poseer ganchos Adams ya que podrían dificultar su erupción) se fueron desbastando los bloques del acrílico superior progresivamente a razón de 1 mm al mes.
Este último aparato funcional se mantuvo en boca durante 8 meses, tras haber conseguido la mejoría esperada en cuanto al aspecto facial (figura 17) y las relaciones oclusales (figuras 18 a 22). La mordida abierta lateral producida es fácilmente solucionable en la siguiente fase de tratamiento.
Con el cementado de los brackets de la técnica Universal Smile System




23 Gaceta Dental · N o 366 | Mayo 2024 Caso clínico. CIENCIA Y CLÍNICA
Figuras 12-17.








(USS), como se aprecia en las figuras 23 a 25, comienza la segunda fase de tratamiento. Esta duró tan solo 12 meses debido a que gran parte de las relaciones oclusales habían mejorado durante la etapa anterior. Los resultados finales del tratamiento se observan en las figuras 26 a 30 , con la corrección de la clase molar y canina, el resalte y la sobremordida, el centrado de las líneas 1/2 y la curva de Spee. La mejoría en la macro, mini y microestética facial se aprecia en las figuras 31 a 33 , a pesar de la evidente desviación del mentón hacia
la derecha debida a la asimetría ósea detectada al inicio del tratamiento. En la figura 34 se muestran los cambios producidos por el tratamiento ortopédico-ortodóncico realizado, con la mejoría de casi todos los valores cefalométricos analizados, así como los ángulos de la convexidad (160 º), nasolabial (100 º) y mentolabial (118 º) más cercanos a la norma.
Las cinco áreas de las superposiciones se visualizan en la figura 35 . Se puede apreciar el crecimiento del mentón y la mejoría en las relaciones dentarias y el perfil.
24 Gaceta Dental · N o 366 | Mayo 2024 CIENCIA Y CLÍNICA. Caso clínico
Figuras 18-25.









Ya que el tratamiento se finalizó antes de la terminación del crecimiento puberal, se colocó a modo de retención un guarda para mantener las arcadas coordinadas hasta el cese de este.
DISCUSIÓN
El aspecto facial demandaba en esta paciente una estimulación
del crecimiento mandibular para conseguir mayor proyección del mentón, así como mejorar la coordinación de las arcadas, corroborado por los datos cefalométricos. Este se decidió realizarlo en dos fases por la magnitud del avance, prefiriendo en una primera etapa colocar un
26
Figuras 26-33.
N o 366 | Mayo 2024 CIENCIA Y CLÍNICA. Caso clínico
Gaceta
Dental ·

Bionator (con avance de 4 mm) por encontrarse en el estadio 4 de crecimiento puberal y por poseer mayor ventaja en cuanto al componente funcional que el Twin Block. En cambio, en la segunda etapa (avance de 5 mm), este último aparato posee mayor eficacia en el avance y/o crecimiento mandibular durante el estadio 5 o ligeramente sobrepasado (8, 9).
La segunda fase de tratamiento, con aparatología fija, se realizó con brackets de autoligado pasivo de la técnica USS (Universal Smile System). Se colocaron brackets con prescripción de alto torque en los caninos superiores (+11 º) e inferiores (+13 º) para ayudar al desarrollo transversal de las arcadas, así como para provocar un movimiento radículo-lingual de estos para mejorar la posición de sus raíces. Alto torque en los incisivos centrales (+22º) y laterales (+13 º) superiores para compensar el efecto de linguoversión

«La técnica de autoligado pasivo USS con prescripción variable ha sido muy conveniente en la biomecánica del caso, así como en la reducción del tiempo global de tratamiento»
que producen los elásticos intermaxilares de Clase II, así como bajo torque en los incisivos inferiores (-11 º) para minimizar la protrusión producida por estos mismos elásticos y por el anclaje recíproco debido al apiñamiento dentario (10-12).
CONSIGUE EL LIBRO DEL DR. LUIS F. MORALES 27 Gaceta Dental · N o 366 | Mayo 2024 Caso clínico. CIENCIA Y CLÍNICA
Figuras 34 y 35.
Los retenedores fijos (13, 14) FLAS y FLAI (férula lingual anterosuperior e anteroinferior, respectivamente) de alambre de acero trenzado de 6 hilos, cementados de canino a canino, aportan estabilidad a los sectores anteriores, y el splint o guarda como aparato de contención nocturna hasta la terminación del crecimiento puberal, aporta estabilidad a los resultados conseguidos.
CONCLUSIONES
1. La ortopedia dentofacial como tratamiento interceptivo en el inicio y,
BIBLIOGRAFÍA
1. AGUILAR MORENO NA, TABOADA ARANZA O Frecuencia de maloclusiones y su asociación con problemas de postura corporal en una población escolar del Estado de México. Bol. Med. Hosp. Infant. Mex. vol.70 no.5 México sep./ oct. 2013.
2. BRAVO A. Análisis de patrón facial y de su relación con la maloclusión. Tesis doctoral. Universidad de Valencia. 1986.
3. BIGLIAZZI R, FRANCHI L, PINHEIRO DE MAGALHÃES BERTOZ A, MCNAMARA JA, FALTIN JR K, BERTOZ F. Morphometric analysis of long-term dentoskeletal effects induced by treatment with Balters Bionator. Angle Orthod. 2015 Sep; 85 (5):790-8.
4. DOS SANTOS PINTO PR, PARSEKIAN L, DOS SANTOS PINTO A, GONZAGA L, BARNABÉ D, MATHEUS DOS SANTOS PINTO CC. Mandibular growth and dentoalveolar development in the treatment of class II, division 1, malocclusion using Balters Bionator according to the skeletal maturation. Dental Press J Orthod. 2013 Jul-Aug;18(4):43-52.
5. FERLIN ANTUNES C, BIGLIAZZI R, BERTOZ FA, FEIJÓ ORTOLANI CL, FRANCHI L, FALTIN JR K. Morphometric analysis of treatment effects of the Balters bionator in growing Class II patients. Angle Orthod. 2013 May;83(3):455-9.
6. KUMAR A, DUGGAL R, PARKASH H. Skeletal and dentoalveolar effects of Twin-block and bionator appliances in the treatment of Class II malocclusion: a comparative study. Am J Orthod Dentofacial Orthop. 2006 Nov;130(5):594-602.
7. PERINETTI G, PRIMOŽIČ J, FURLANI G, FRANCHI L, CONTARDO L. Treatment effects of fixed functional appliances alone or in combination with multibracket
posteriormente, en el pico de máximo crecimiento puberal, ha sido muy satisfactoria en la estimulación del avance y/o crecimiento mandibular.
2. La técnica de autoligado pasivo USS con prescripción variable ha sido muy conveniente en la biomecánica del caso, así como en la reducción del tiempo global de tratamiento.
3. El splint o guarda como aparato de contención en el mantenimiento de los resultados conseguidos durante la última etapa de crecimiento puberal ha sido clave para evitar la recidiva en nuestra paciente. ●
appliances: A systematic review and meta-analysis. Angle Orthod. 2015 May;85(3):480-92.
8. O’BRIEN K, WRIGHT J, CONBOY F, SANJIE Y, MANDALL N, CHADWICK S, CONNOLLY I, COOK P, BIRNIE D, HAMMOND M, HARRADINE N, LEWIS D, MCDADE C, MITCHELL L, MURRAY A, O’NEILL J, READ M, ROBINSON S, ROBERTS-HARRY D, SANDLER J, SHAW I. Effectiveness of early orthodontic treatment with the Twin-block appliance: a multicenter, randomized, controlled trial. Part 1: Dental and skeletal effects. Am J Orthod Dentofacial Orthop. 2003 Sep;124(3):234-43.
9. IRFANULLA KHAN M, KUMAR NEELA P, UNNISA N, KUMAR JAISWAL A, AHMED N, PURKAYASTHA A Dentoskeletal effects of Twin Block appliance in patients with Class II malocclusion. Med Pharm Rep. 2022 Apr;95(2):191-96.
10. MORALES LF. técnica de autoligado pasivo «Universal Smile System» (USS). Parte I. Gaceta Dental 2105; 268:2-14.
11. VENTUREIRA C. Prescripción variable en ortodoncia: lo que todo ortodoncista debería conocer. Rev Esp Ortod. 2010; 40:9-24.
12. MORALES LF. técnica de autoligado pasivo «Universal Smile System» (USS). Parte II. Gaceta Dental 2106; 276:2-14.
13. KOCHER KE, GEBISTORF MC, PANDIS N, FUDALEJ PS, KATSAROS C. Long-term Effectiveness of Maxillary and Mandibular Bonded Orthodontic Retainers. Oral Health Prev Dent. 2020 Jun 8;18(1):633-41.
14. AL DBOUSH R, AL ZAWAWI E, EL-BIALY T. Do orthodontic fixed retainers guarantee the stability of dental alignment at the end of orthodontic treatment? Evid Based Dent. 2021 Dec;22(4):148-9.
28 Gaceta Dental · N o 366 | Mayo 2024 CIENCIA Y CLÍNICA. Caso clínico
Curso sobre técnicas de autoligado en ortodoncia. Casos clínicos
+ Show Cooking
Impartido por el Dr. Luis Fernando Morales Jiménez, autor de Manual de Ortodoncia Clínica. Tomo 1
25 de mayo
LBK Las Cortes
Calle Marqués de Cubas, 23 Madrid, 28014
9:30 horas

Llévate el libro gratis con tu inscripción







Más información

 Organiza:
Impulsa:
Organiza:
Impulsa:
Ciencia y clínica Rehabilitación 100% digital: desde la planificación a la carga
A propósito de un caso

DR. CARLOS LEÓN PÉREZ
Cirujano e implantólogo. Perito en Odontología. Director del Área Quirúrgica del Instituto Odontológico de Barcelona (IOB).
RESUMEN
Presentamos el tratamiento rehabilitador de una paciente, realizado íntegramente en una sesión. Para este caso se ha utilizado un protocolo quirúrgico digital y guiado mediante la Plataforma de Planificación Bego Guide. Asimismo, se ha diseñado digitalmente una prótesis de carga inmediata atornillada e impresa con resina Bego VarseoSmile TriniQ®. Por lo tanto, se trata de un caso cuyo tratamiento precisa diferentes fases, pero efectuadas, todas ellas, el mismo día. De forma sencilla y cómoda para la paciente y el odontólogo, se ha obtenido una rehabilitación fija, funcional y estética. Palabras clave: Cirugía guiada, implantología oral guiada, cirugía sin colgajo, férula quirúrgica, rehabilitación fija maxilar, impresión digital, escáner intraoral, implantes dentales.
ABSTRACT
We present a rehabilitative treatment of a patient, carried out full in one session. For this case, a digital surgical protocol was used
by Bego Guide Planning Platform. Likewise, an immediate loading prosthesis has been digital designed, screwed and printed with Bego VarseoSmile TriniQ® resin. Therefore, it’s a case whose treatment requires different phases, but all of them carried out on the same day. In a simple and comfortable way for the patient and the dentist, a fixed, functional and aesthetic rehabilitation has been obtained.
Keywords: Guided-surgery, guided-implant dentistry, flapless surgery, surgical template, maxillary fixed rehabilitation, Digital impressions, Intraoral scanner; dental implants.
CASO CLÍNICO
Estado previo y necesidad terapéutica
Paciente de sexo femenino, de 65 años. Tras realización de anamnesis constatamos que no presenta antecedentes médicos de interés, no medicada, sin reacciones adversas medicamentosas, ni hábitos tóxicos referidos.
30 Gaceta Dental · N o 366 | Mayo 2024 CIENCIA Y CLÍNICA. Caso clínico
«La cirugía con técnica guiada disminuye drásticamente el rango de desviación de los implantes dentales y permite una colocación tridimensional óptima»

La cirugía guiada registra físicamente la correcta realización de un diagnóstico, estudio y planificación previos, así como un protocolo de ejecución detallado.
Exploración Intraoral
Presenta un estado oral deficitario. Parcialmente edéntula, con colapso de mordida, migración dental patológica, restauraciones de resina antiguas fisuradas y filtradas, transparencia y exposición de cámara pulpar secundaria a desgastes con pérdida de estructura e integridad de tejido dental importante (Figuras 1 a 4). Portadora a tiempo parcial de prótesis removibles desadaptadas de más de 10 años de antigüedad, refiriendo incapacidad de adaptación a este tipo de prótesis.
Exploración extraoral
Se constata reducción del tercio facial inferior produciendo a nivel estético una apariencia envejecida por formación de surcos en las comisuras labiales («líneas de marioneta») secundarias a una disminución de la dimensión vertical por desgaste dental (Figuras 5 y 6).
Exploración radiológica
Mediante CBCT constatamos atrofias óseas severas y disminución de soporte óseo periodontal en relación con las piezas dentales.
Diagnóstico y planificación digital
A tenor del estado oral proponemos múltiples opciones terapéuticas, consensuando entre paciente y facultativos una rehabilitación implantoprotésica fija superior e inferior. Debido a la lejanía de la residencia de la paciente, y motivados por las necesidades estéticas que esta exige, consideramos realizar una carga inmediata impresa con resina definitiva el mismo día de la cirugía. Tras el escaneado intraoral con el escáner Dexis IS3700 (Figuras 7 y 8) y realización de CBCT, subimos los ficheros a la plataforma Bego Guide,
31 Gaceta Dental · N o 366 | Mayo 2024 Caso clínico. CIENCIA Y CLÍNICA







 Figura 3. Visión intraoral oclusal mandibular.
Figura 4. Visión intraoral frontal.
Figura 1. Visión intraoral oclusal maxilar.
Figura 2. Visión lateral izquierda intraoral.
Figura 7. Escaneado intraoral maxilar con Dexis IS3700.
Figura 8. Escaneado intraoral mandibular con Dexis IS3700.
Figura 5. Visión extraoral lateral sonrisa.
Figura 3. Visión intraoral oclusal mandibular.
Figura 4. Visión intraoral frontal.
Figura 1. Visión intraoral oclusal maxilar.
Figura 2. Visión lateral izquierda intraoral.
Figura 7. Escaneado intraoral maxilar con Dexis IS3700.
Figura 8. Escaneado intraoral mandibular con Dexis IS3700.
Figura 5. Visión extraoral lateral sonrisa.
32 CIENCIA Y CLÍNICA. Caso clínico Gaceta Dental · N o 366 | Mayo 2024
Figura 6. Visión extraoral frontal sonrisa.
procediendo a realizar una solicitud de encargo a través de un formulario. Antes de 72 horas recibimos una propuesta terapéutica. En ella se facilitan vistas 3D detalladas, así como valoraciones y consideraciones a tener en cuenta durante el fresado y la inserción de los implantes (Figuras 9 a 19). Decidimos realizar extracción de todas las piezas remanentes, dada su nula viabilidad a corto-medio plazo y en Bego (a través del portal) proponen mantener 3 piezas (las más viables técnicamente) en cada arcada para proporcionar el anclaje óptimo de la
férula. Tras la aceptación del caso envían a la clínica la férula quirúrgica junto con un claro protocolo de secuencia de fresado.
Preoperatorio
Previamente a la intervención, nos reunimos con la paciente. Mediante las ilustraciones tridimensionales obtenidas de la planificación, se expone el caso. Las imágenes facilitan la compresión del tratamiento y ayuda a solventar dudas. Ello permite la adhesión de la paciente al tratamiento, aumenta la confianza médico-paciente y reduce

Figura 9. Propuesta de planificación maxilar con encerado diagnóstico digital. Se visualiza emergencia de los implantes y emergencia protésica con pilares angulados.

Figura 11. Encerado diagnóstico digital sobre maxilar superior.

Figura 10. Propuesta de planificación maxilar con encerado diagnóstico digital. Destaca la angulación del implante 1.6 esquivando el seno maxilar con un ángulo de inserción de 30 º y una emergencia protésica verticalizada.

Figura 12. Encerado diagnóstico digital teniendo en consideración un aumento de la dimensión vertical.
33 Caso clínico. CIENCIA Y CLÍNICA Gaceta Dental · N o 366 | Mayo 2024

Figura 13. Representación gráfica de la futura colocación de los implantes y su relación con la rehabilitación.


16. Superposición radiológica implante 45 angulado, teniendo en consideración el encerado diagnóstico y preservando estructuras nerviosas.

Figura 14. Representación tridimensional. Destaca la protección de estructuras nobles (nervio mentoniano) al presentar un implante angulado con íntima relación.
Figura 15. Visión general tridimensional. Destaca la uniformidad en la disposición de los implantes. En amarillo emergencia implantológica y en gris emergencia protésica mediante pilares transepiteliales angulados multiplus.

17. Implante 31

18. Implante 14.
la resistencia, inseguridades y miedos típicos de este tipo de intervenciones. Confeccionamos e individualizamos un documento de consentimiento informado, el cual leemos conjuntamente, solventamos dudas, realizamos las aclaraciones pertinentes y firmamos juntamente, con el tiempo suficiente, previo a la intervención.

19. Superposición radiológica considerando encerado diagnóstico en el 1 er cuadrante.
Ejecución técnica quirúrgica mediante férula guiada Bajo anestesia infiltrativa realizamos extracciones atraumáticas de todas las piezas a excepción de los dientes que actúan como anclaje o pilares para la fijación de la férula quirúrgica (Figuras 20 y 21). Seguidamente insertamos la férula comprobando una buena adaptabilidad y estabilidad
Figura
Figura
en posición ideal.
Figura
Figura
34 CIENCIA Y CLÍNICA. Caso clínico Gaceta Dental · N o 366 | Mayo 2024


Figura
de dientes estratégicos para fijar la férula quirúrgica.








 Figura 23. Férula quirúrgica inferior.
Figura 24. Fresado guiado con férula y cucharilla.
Figura 20. Extracciones dentales.
21. Conservación
Figura 22. Férula quirúrgica superior.
Figura 25. Inserción de implante RSX de Bego a través de férula quirúrgica.
Figura 27. Conexión de pilar angulado multiplus sobre implante.
Figura 26. Implante insertado en lecho a través de férula quirúrgica.
Figura 28. Muestra del perfecto paralelismo tras la colocación de pilares angulados multiplus.
Figura 29. ScanBody sobre pilares transepiteliales.
Figura 23. Férula quirúrgica inferior.
Figura 24. Fresado guiado con férula y cucharilla.
Figura 20. Extracciones dentales.
21. Conservación
Figura 22. Férula quirúrgica superior.
Figura 25. Inserción de implante RSX de Bego a través de férula quirúrgica.
Figura 27. Conexión de pilar angulado multiplus sobre implante.
Figura 26. Implante insertado en lecho a través de férula quirúrgica.
Figura 28. Muestra del perfecto paralelismo tras la colocación de pilares angulados multiplus.
Figura 29. ScanBody sobre pilares transepiteliales.
35 Caso
Y CLÍNICA Gaceta Dental · N o 366 | Mayo 2024
Figura 30. Tapones de cicatrización sobre pilares transpiteliales.
clínico. CIENCIA
(Figuras 22 y 23). Se realiza fresado transgingival mínimamente invasivo y guiado hasta la inserción de los implantes, siguiendo el protocolo preestablecido e indicado (Figuras 24 a 26).
Durante la colocación de los implantes comprobamos una inserción con torque superior a 35 N/cm2
Retiramos la férula y comprobamos una correcta estabilidad primaria mediante mediación de valores
ISQ favorables en la mayoría de los implantes. Seguidamente se extraen los dientes remanentes que han actuado de medio retentivo para la férula quirúrgica.
Dentro de la fase quirúrgica propiamente dicha, una vez terminada la inserción de los implantes y


comprobada su estabilidad primaria, colocamos pilares transepiteliales
Multiplus para registrar una impresión digital mediante escaneado sobre ellos (Figuras 27 a 29)
Ejecución técnica protésica
Dado que la estabilidad primaria se ha conseguido en la mayoría de los implantes, coincidiendo con la previsión propuesta en la planificación, procedemos ahora a la fase protésica. En el caso que nos ocupa, la paciente reside lejos, por lo tanto, colocamos tapones sobre los pilares transepiteliales y descansa en la sala de recuperación (Figura 30).
El procedimiento de diseño, impresión, pulido y cementación de aditamentos consume


 Figura 34. Rehabilitación superior impresa en resina
Bego VarseoSmile TriniQ® lista para atornillar. Se han anulado de la oclusión aquellos implantes que no obtuvieron una estabilidad primaria superior a 35 N/cm2
Figura 31. Escaneado intraoral postcirugía. Figura 32. Rehabilitación recién impresa a través de impresora Varseo XS con resina Bego VarseoSmile TriniQ®.
Figura 33. Ajuste pasivo entre aditamentos protésicos y la rehabilitación impresa.
Figura 34. Rehabilitación superior impresa en resina
Bego VarseoSmile TriniQ® lista para atornillar. Se han anulado de la oclusión aquellos implantes que no obtuvieron una estabilidad primaria superior a 35 N/cm2
Figura 31. Escaneado intraoral postcirugía. Figura 32. Rehabilitación recién impresa a través de impresora Varseo XS con resina Bego VarseoSmile TriniQ®.
Figura 33. Ajuste pasivo entre aditamentos protésicos y la rehabilitación impresa.
36 CIENCIA Y CLÍNICA. Caso clínico Gaceta Dental · N o 366 | Mayo 2024
Figura 35. Visión gingival de la rehabilitación impresa.


HASTA EN EL MÁS MÍNIMO DETALLE
Semado s ® Es t he t ic Lin e





















VISÍTANOS EN EL STAND 8E16

































PERFECCIÓN



aproximadamente una hora y media. Usamos resina Bego VarseoSmile TriniQ® para puentes definitivos. Aunque en este caso la vamos a usar para confeccionar unas prótesis fijas atornilladas provisionales de larga duración, dado al aumento de dimensión vertical que vamos a realizar a la paciente, de esta forma obtendremos una neuroprogramación de la ATM reinstaurando una Dimensión Vertical apropiada y mejorando la estética facial de la paciente. Excluimos de la carga aquellos implantes que no obtuvieron una estabilidad primaria superior a 35 N/ cm2. El material permite la realización de una carga inmediata en material definitivo en puentes (Figuras 31 a 38).
DISCUSIÓN
España es uno de los países de la Unión Europea donde más implantes dentales se colocan. Concretamente entre 1.200.000 y 1.400.000 millones de implantes al año. En cuanto a la franja de edad, dos de cada diez personas de entre 25 y 79 años tienen colocado un implante dental (1). Los implantes dentales se encuentran entre los tratamientos odontológicos más solicitados, junto a los tratamientos estéticos y ortodónticos (2).
A todo ello, debemos sumar que en los últimos 15 años la presión legal
de los pacientes se ha convertido en un hecho de intensidad creciente que preocupa cada vez más a los profesionales (3). De hecho, la Odontología es la cuarta actividad sanitaria más reclamada en los tribunales españoles (4). Por lo tanto, debemos realizar los tratamientos implantológicos con la máxima precisión (y normopraxis) posible.
Uno de los aspectos que nos convenció para utilizar un sistema guiado fue la baja tasa desviación que presentan los implantes. Si bien la cirugía a mano alzada es completamente válida, no estamos exentos de que se produzca una desviación de 11.2° ± 5.6° (5), mientras que usando sistemas guiados, dicha desviación se reduce significativamente a un 2.1° ± 1° (6). Otro factor favorable es que contempla la posición tridimensional ideal (7, 8), teniendo en cuenta el espacio de confort, así como una rehabilitación protésicamente guiada a partir de un encerado diagnóstico digital efectuado sobre referencias anatómicas obtenidas de un CBCT y modelos de estudio tridimensionales a través de un escaneado intraoral. Su uso, sin duda, facilita la fase protésica y reduce significativamente los cambios en el plan de tratamiento protésico, teniendo claro, desde el
Figura 36. Carga inmediata provisional recién atornillada.
38 CIENCIA Y CLÍNICA.
clínico Gaceta Dental · N o 366 | Mayo 2024
Figura 37. Resultado final visión frontal. Figura 38. Resultado final visión lateral.
Caso
«La cirugía guiada, en combinación con la impresión 3D, permite reducir el riesgo de la pérdida ósea marginal periimplantaria y, por ende, futuras patologías periimplantarias asociadas»
Decidimos realizar una prótesis impresa ya que permite trabajar bajo el concepto «chairside», es decir, de ser necesario, desde la misma consulta, con el paciente en ella (en nuestro caso descansando desde la sala de recuperación), sin necesidad de intermediarios, se puede confeccionar una prótesis completamente personalizada con una adaptación y pasividad total. Asimismo parece que la impresión 3D produce coronas permanentes con una precisión dimensional superior (12).
inicio, el tipo de prótesis y aditamentos a utilizar, permitiendo así una comunicación con el laboratorio mucho más fluida.
La planificación digital previa permite prever los pilares transepiteliales necesarios para registrar una impresión digital sobre ellos, no volviéndolos a desatornillar, siguiendo la filosofía de trabajo «one abutment one time». De este modo, se minimiza la posible pérdida ósea marginal periimplantaria que todo implante pude sufrir, así como posibles patologías periimplantarias ya que la conexión y reconexión de los pilares en los tejidos blandos produce modificaciones y pérdidas en los implantes con cambio de plataforma (9). Nos decantamos por realizar una carga inmediata el mismo día de la cirugía, no solo por los beneficios que aporta al paciente (rapidez y comodidad), sino porque al obtener una correcta estabilidad primaria, el hecho de rehabilitar tempranamente parece favorecer la estabilidad de los tejidos blandos, pudiendo contribuir a reducir la pérdida ósea marginal (10, 11).
Finalmente nos sorprendió la pronta recuperación de la paciente, refiriendo un mínimo dolor percibido (más bien descrito como mínimas molestias), sin apenas precisar analgésicos ni antiinflamatorios postoperatorios (salvo en las primeras 12 horas), distando mucho del postoperatorio estándar en casos de cirugía convencional (13).
CONCLUSIONES
• La cirugía con técnica guiada disminuye drásticamente el rango de desviación de los implantes dentales y permite una colocación tridimensional óptima, respetando el espacio de confort y bajo el concepto de Implantología protésicamente guiada.
• La cirugía guiada registra físicamente la correcta realización de un diagnóstico, estudio y planificación previos, así como un protocolo de ejecución detallado. La existencia de un documento médico legal y técnico (que se debe adjuntar a la historia médica) acredita una correcta normopraxis.
• Las ilustraciones tridimensionales proporcionadas facilitan la comunicación interprofesional y médico-paciente.
• La planificación previa, así como el encerado digital, permiten conocer
39 Caso clínico. CIENCIA Y CLÍNICA Gaceta Dental · N o 366 | Mayo 2024
de antemano los aditamentos protésicos necesarios para no requerir posteriores cambios de los mismos, fomentando así, la filosofía «one abutment one time».
• La cirugía guiada, en combinación con la impresión 3D, permite la confección protésica el mismo día de la intervención, siempre y cuando se obtenga estabilidad primaria.
• La cirugía guiada, en combinación con la impresión 3D, permite reducir el riesgo de pérdida ósea marginal periimplantaria y, por ende,
BIBLIOGRAFÍA
1. SALINAS N. España, uno de los países europeos donde más implantes dentales se colocan. El periódico de España. Madrid. [Internet]. 2023. [Consultado 17 Ene 2024]. Disponible en: https://www.epe.es/es/sanidad/20230904/espanapaises-europeos-implantes-dentales-91682576.
2. LLODRA JC, BOURGEOIS D. La salud bucodental en España 2020. Consejo Dentistas. Madrid. [Internet]. 2020 [Consultado 17 Ene 2024] Disponible en: https:// consejodentistas.es/wp-content/uploads/2023/05/SaludBucodental-2020.pdf
3. PEREA PÉREZ B, LABAJO GONZÁLEZ ME, SANTIAGO SÁEZ A, ABARRÁN JUAN ME. Responsabilidad profesional en odontología. Rev Esp Med Legal. 2013; 39:149- 156.
4. PEREA PÉREZ B, SANTIAGO SÁEZ A, LABAJO GONZÁLEZ ME, ALBARRÁN JUAN ME, SÁNCHEZ SÁNCHEZ JA. Análisis de las consecuencias medicolegales de las reclamaciones judiciales de pacientes. Estudio comparativo de los casos de traumatología, ginecología y obstetricia, anestesia y reanimación y odontoestomatología. Trauma Fund Mapfre. 2009; 20:264-268.
5. HOFFMANN J, WESTENDORFF C, GOMEZ ROMAN G, REINERT S. Accuracy of navigation-guided socket drilling before implant installation compared to the conventional free-hand method in a synthetic edentulous lower jaw model. Clin Oral Implants Res. 2005;16(5):609-14.
6. BRANDT J, LAUER HC, PETER T, BRANDT S. Digital process for an implant-supported fixed dental prosthesis: A clinical report. The Journal of Prosthetic Dentistry, 2015 2015, 4469-473.
7. JIVRAJ S, CHEE W, CORRADO P. Treatment planning of the edentulous maxilla. British Dental Journal. 2006. (201); 261–279.
8. BUSER D, MARTIN W, BELSER U. Optimizing esthetics for
futuras patologías periimplantarias asociadas.
• Permite realizar cirugías mínimamente invasivas, con baja morbilidad, limpias, suponiendo un beneficio significativo para el paciente, con dolor mínimo, reduciendo la administración de analgésicos y antinflamatorios.
• De forma sencilla y cómoda para la paciente y el odontólogo, se obtiene una rehabilitación fija, funcional y estética.
• Es un tratamiento estable, fiable y predecible. ●
implant restorations in the anterior maxilla: anatomic and surgical considerations. Int J Oral Maxillofac Implants. 2004. (19); 43-61.
9. BECKER K, MIHATOVIC I, GOLUBOVIC V, SCHWARZ F. Impact of abutment material and dis-/re-connection on soft and hard tissue changes at implants with platform-switching. J Clin Periodontol. 2012 Aug;39(8):774-80.
10. PÉREZ SAYANS M, CASTELO BAZ P, PENARROCHA OLTRA D, SEIJAS NAYA F, CONDE AMBOAGE M, SOMOZA MARTÍN JM . Impact of abutment geometry on early implant marginal bone loss. A double-blind, randomized, 6-month clinical trial. Clin Oral Implants Res. 2022 Oct;33(10):1038-48.
11. PÉREZ SAYÁNS M, VIANNA CAMOLESI GC, VIEIRA E SILVA FF, PÉREZ JARDÓN A. New approaches in the control of peri implant marginal bone loss. Av Odontoestomatol vol.39 no.3. Madrid 2023 Epub 06-Nov-2023.
12. KUMOTICA. Un nuevo estudio encuentra que la impresión 3D es más precisa que el fresado en la creación de coronas dentales. 2022. [Internet]. Valenia [Consultado 17 Ene 2024]. Disponible en: https://kumotica.es/blog/sectordental-u-odontologico/estudio-encuentra-impresion3d--mas-precisa-que-fresado-en-la-creacion-coronasdentales.
13. POZZI A, TALLARICO M, MARCHETTI M, SCARFÒ B, ESPOSITO M. Computer-guided versus free-hand placement of immediately loaded dental implants: 1-year post-loading results of a multicentre randomised controlled trial. Eur J Oral Implantol. 2014 Autumn; 7(3):229-42.
40 CIENCIA Y CLÍNICA. Caso clínico Gaceta Dental · N o 366 | Mayo 2024
Organiza:
Impulsa:
¡Novedad editorial en la Tienda GD!
Un viaje guiado entre la Biología, la Estética y la Cirugía
Conviértete en un experto en cirugía de implantes con este libro de 2 volúmenes, que ofrece tratamientos innovadores y tradicionales para abordar cada situación, incluidos los casos clínicos “imposibles”.





· tienda.gacetadental.com · 606 948 236
Ciencia y clínica
Pacientes asmáticos en Odontopediatría (y II)

Alumna del Máster en Odontopediatría y Ortodoncia Interceptiva y Funcional. Universidad CEU San Pablo.
Clara Sandibel Garcete Delvalle
Profesora del Máster en Odontopediatría y Ortodoncia Interceptiva y Funcional. Universidad CEU San Pablo.
Alberto Adanero Velasco
Profesor del Máster en Odontopediatría y Ortodoncia Interceptiva y Funcional. Universidad CEU San Pablo.
Marta Bruna Del Cojo
Profesora del Máster en Odontopediatría y Ortodoncia Interceptiva y Funcional. Universidad CEU San Pablo.
Eva María Martínez Pérez
Directora del Máster en Odontopediatría y Ortodoncia Interceptiva y Funcional. Universidad CEU San Pablo.
Caridad Arias Macías
Directora del Departamento de Odontología. Universidad CEU San Pablo. MARÍA FLÓREZ
El paciente pediátrico con enfermedad asmática es una problemática diaria en Odontopediatría. Tanto las características propias de la enfermedad como sus repercusiones bucodentales, se deben tener en cuenta para individualizar a cada paciente y buscar su salud oral. Son pacientes con mayor susceptibilidad a caries, gingivitis o erosión dental, entre otras consecuencias debidas a su farmacoterapia. Por ello, es importante que los profesionales de la salud tengan conocimiento para tomar medidas preventivas sobre su higiene oral. De tal forma, la segunda parte de este trabajo (accede al QR para ver la primera parte) tiene la finalidad de presentar una puesta al día sobre la enfermedad asmática y sus manifestaciones clínicas y orales, así como la manera de actuar ante una crisis asmática durante el tratamiento dental. Así pues, se va a realizar una revisión bibliográfica
42 CIENCIA Y CLÍNICA. Ciencia Gaceta Dental · N o 366 | Mayo 2024
MORA
«El odontólogo tiene un papel muy importante en la prevención, diagnóstico y tratamiento de las manifestaciones bucodentales del asma en los niños y niñas»

con el fin de actualizar el protocolo en la consulta dental con pacientes asmáticos y, de esta manera, poder reducir su problemática dental.
OBJETIVOS
Objetivo principal
Conocer las manifestaciones clínicas de los pacientes asmáticos en Odontopediatría.
Objetivos específicos
Describir las manifestaciones extraorales de los pacientes asmáticos; determinar las repercusiones intraorales de los pacientes asmáticos; y analizar las consecuencias de la farmacoterapia de la enfermedad asmática sobre la salud oral.
MATERIALES Y MÉTODOS
La búsqueda bibliográ fic a se ha centrado en buscadores con acceso desde la Blibioteca Ceu San Pablo: Dentistry & Oral Sciences Source, Medline Pubmed, Dialnet Plus y desde el metabuscador EBSCO Discovery Service; adem á s, se h a realizado una búsqueda manual en libros y bases de datos como Semantic Scholar.
RESULTADOS
Ramos-Ríos y cols. estudiaron dos escuelas con niños de rango de edad de 6 y 12 años, en México. Para ello, se empleó un cuestionario para los padres y se obtuvo que un 6,84% padecían asma; de éstos se llevó a cabo el estudio (Tabla 1).
Tras los resultados obtenidos llegaron a la conclusión de que son muchas las patologías asociadas al asma, y no solo repercusiones sobre su salud oral, sino maloclusiones del tipo mordida abierta o paladar ojival asociadas a deglución atípica, propias de una respiración oral
43 Ciencia. CIENCIA Y CLÍNICA Gaceta Dental · N o 366 | Mayo 2024
Imagen cedida por la Dra. Clara Garcete, profesora de Grado y Máster de la Universidad CEU San Pablo.

también relacionada con esta patología. El pH ácido se encontró en un 96,42% de los niños y se sabe que tiene relación directa con la formación de caries. No encontraron asociaciones con xerostomía, erosión dental o candidiasis, siendo estas patologías relacionadas, al mismo tiempo, con la inmunosupresión generada por los fármacos (1).
Brigic y cols. evaluó la cantidad de concentración de Streptococcus Mutans presentes en la boca, comparando un grupo control con niños asmáticos y otro grupo experimental con niños sin asma. Los resultados obtenidos fueron que el 69% tenía niveles altos de Streptococcus Mutans, pero sin haber diferencias significativas entre ambos grupos, ni tampoco en relación con su índice salival. Entonces, no consideran que exista una reducción relevante de la secreción salival, por lo tanto, está de acuerdo con Ramos-Ríos y cols. en que ambos no encontraron xerostomía en sus estudios. Su estudio
apoya la etiología multifactorial de las caries y no asocia un mayor riesgo de caries en niños asmáticos, ya que, en la mayoría de los casos, la medicación inhalatoria consistía en un tratamiento intermitente y no acumulativo (38).
Además, Brigic y cols. quisieron comparar, con el mismo tamaño muestral, el potencial cariogénico de los medicamentos inhalatorios propios del asma. Entre las variables estudiadas se encontraron resultados contradictorios. Por un lado, los hábitos de higiene eran similares en ambos grupos. También había diferencias en cuanto al nivel socioeconómico, lo que puede influir en el resultado. Concluyeron que el efecto de la medicación sobre las caries no se puede observar dentro del cuadro de su etiología multifactorial; y, por ello, hay que incluir el estilo de vida, edad o hábitos de higiene, entre otros (31).
Samec y cols. estudiaron 138 pacientes asmáticos y a sus 140 hermanos sin patología. A
44 CIENCIA Y CLÍNICA. Ciencia Gaceta Dental · N o 366 | Mayo 2024
Tabla 1. Tabla de elaboración propia sobre los datos obtenidos en el estudio de Ramos-Ríos y cols. (1).
diferencia de Brigic y cols. excluyó a aquellos niños cuyo tratamiento con inhalatorios era intermitente y escogió una población estudio de niños diagnosticados con asma y tratados durante al menos 1 año, siendo la duración media de 5 años. Para evitar más factores influyentes, se valoró que tuviesen los mismos estilos de vida al ser hermanos y las mismas condiciones ambientales que les rodeasen. Los niños asmáticos que tomaban antagonistas del receptor de leucotrienos tenían menor índice de caries que aquellos con glucocorticoides inhalados; al igual que a mayor dosis diaria, mayor prevalencia de caries (6).
Samec y cols. afirmaron la existencia de asociación directa entre aparición de caries y el empleo diario de glucocorticoides inhalados, ya que pasados los 3 años el incremento de lesiones cariosas fue significativamente superior en los niños asmáticos frente a sus hermanos sin patología (6).
Domenzain-Sanchez y cols. realizaron un estudio transversal de casos y controles con pacientes de 5 a 12 años. Un 80% de los asmáticos presentaban caries, a pesar de que los autores no encontraban relación directa entre caries y enfermedad asmática. Éstos consideran que la medicación es la causa principal de las caries, ya que gran parte se queda en la orofaringe, además de reducir el flujo salival y tener azú cares. Los niños asmáticos tienen 1,02 mayor riesgo de erosión dental que los niños no asmáticos; esto se debe a la acidez de los fármacos que reducen el pH y provocan reflujo gastroesofágico. La mayoría de los estudios no avalan una asociación directa con el bruxismo, ya que en niños es muy frecuente, pero concretamente
«La mayoría de los autores consultados considera que existe una asociación directa entre la caries y el asma, respetando su origen multifactorial»
en este estudio resultó que un 14% presentaban bruxismo dentro del grupo de asmáticos y lo justifican con la obstrucción parcial prolongada o completa de las vías respiratorias (53).
Gorji y cols. realizaron un metaanálisis para establecer la asociación entre caries y asma. Llegaron a la conclusión de que el asma es un factor de riesgo de caries y de no tratarse adecuadamente y tener las medidas preventivas necesarias, aumenta la probabilidad de desarrollar caries. Atendiendo a la falta de suministro de oxígeno, los ameloblastos se ven afectados y se altera la formación del esmalte, lo que origina defectos sin posibilidad de reparación como el MIH o síndrome de hipomineralización incisivo-molar (9).
Świgtkowska-Bury y cols. indican que los pacientes asmáticos infantiles tenían mayor tendencia al consumo de azú cares, y los autores indican que es un efecto compensatorio a la enfermedad. De este estudio se concluyó que, durante la dentición primaria, son más susceptibles a caries por las propiedades de la dentición (Brigic y cols. y Samec y cols.).
Otro estudio realizado en Taiwán por Wu y cols. analizó la
ACCEDE A LA PRIMERA PARTE DEL ARTÍCULO 45 Ciencia. CIENCIA Y CLÍNICA Gaceta Dental · N o 366 | Mayo 2024
«En un estudio realizado, los niños asmáticos que tomaban antagonistas de leucotrienos tenían menor índice de caries que aquellos con glucocorticoides inhalados»
que llevaban medicados, siendo a partir del noveno mes, un periodo más largo, y relacionado con estado de mala higiene oral. A diferencia de Wu y cols. no encontraron diferencia en los resultados sobre el tipo de inhalador (55).
prevalencia de la caries dental en niños asmáticos, así como el efecto de la medicación: 4.601 pacientes con asma y 4.589 sin patología; cuya edad fue de 0-9 años. La prevalencia de caries obtenida fue del 85,2% en niños sin asma, frente a un 90% con enfermedad respiratoria. Además, los niños tratados con broncodilatadores presentaban mayor prevalencia y severidad de caries. Este estudio, al igual que Samec y cols., confirma la asociación entre los broncodilatadores y el desarrollo de la caries (6, 54).
De igual modo, hay que tener en cuenta la población escogida, edad y etnia, ya que se estima que un 89% tienen prevalencia de caries en dentición temprana (54).
Bansal y cols. realizaron un estudio en la India, cuya finalidad era examinar la salud oral de niños asmáticos y compararla con niños sin patología. El índice de placa fue considerablemente mayor en niños asmáticos, así como la prevalencia de caries, periodontitis y candidiasis oral. Lo que destacó fue el periodo
La respiración bucal es muy frecuente en niños con asma y surge como una función adaptativa, ya que tienen dificultad respiratoria. Puede implicar cambios de postura a nivel cervical, afectando al crecimiento del niño; además de alteraciones en el crecimiento de maxilares y en los m ú sculos orofaciales, la posición baja de la lengua detiene el crecimiento transversal, originando paladar ojival y mordida cruzada posterior. A nivel anterior, la alteración en la posición lingual provoca deglución atípica.
Castañeda-Zetina y cols. realizaron un estudio para comparar las maloclusiones en niños asmáticos y sanos, en el cual se incluyeron 186 pacientes de entre 5 y 12 años. Los resultados obtenidos fueron que más del 50% de los niños asmáticos tienen respiración oral. Las principales alteraciones oclusales presentadas eran mordida abierta anterior y mordida cruzada posterior, menos frecuente; además de una menor frecuencia de clase III, solo un 11,6%, ya que el cambio postural de estos pacientes favorece la entrada del aire inclinando la cabeza hacia atrás y favoreciendo la aparición de clase II al posterorrotar la mandíbula. Estas modificaciones posturales van a producir alteraciones maxilares y desequilibrio en los m ú sculos periorales; por ello, su detección precoz ayudará a resolver el problema con un abordaje multidisciplinario y dando armonía al complejo dentoesquelético (56).
46 CIENCIA Y CLÍNICA. Ciencia Gaceta Dental · N o 366 | Mayo 2024
Diferencia tu clínica potenciando el cuidadode
tu salud y la de tus pacientes
Bambach la original
Postura de Sentado
¿miedo a las agujas?

Wand STA


























Anestesia local Controlada por computadora
































Sin Miedo. Sin Dolor.







* Nota importante: ¿Ya tienes un The Wand STA?¡Contáctanos y te actualizaremos sobre su uso! kdental.esSTA?
¿Tienes un The Wand STA? ¡LLámanos!


30 - 40 cm 76 - 89 cm 63 - 71 cm prueba
Ergonómica Dolorosa
10 días GRATIS
THE
Bambach - Kdental - C/ Sabino Arana 66 - 48640 Berango - Bizkaia - Tef 94 668 04 03 - WhatsApp 689 889 273 info@bambach.es info@kdental.eswww.bambach.es - www.kdental.es Bambach.es kdental.es
«Los niños asmáticos tienen 1,02 mayor riesgo de erosión dental que los niños no asmáticos; esto se debe a la acidez de los fármacos que reducen el pH y provocan reflujo gastroesofágico»

DISCUSIÓN
Tras la revisión bibliográfica se observa controversia en los resultados y se debe a las variables de la población muestral entre los distintos estudios analizados. Por un lado, Brigic y cols. consideran que no existe relación directa entre la enfermedad asmática y un mayor índice de caries; pero no tuvo en cuenta que su población muestral tuviera un tratamiento continuo, es decir, consideró a niños tratados con inhalatorios de forma esporádica e intermitente. En cambio, Samec y cols. escogieron en su estudio a niños diagnosticados con la enfermedad y que llevaran al menos 1 año de tratamiento, por lo que ambos estudios no son comparables. Otro punto de interés que escogieron Samec y cols. fue que quisieron comparar resultados entre hermanos, es decir, tomaron un grupo de niños asmáticos y un grupo de niños sanos hermanos de los niños asmáticos. Por este motivo, Samec y cols. quisieron reunir los factores influyentes en la enfermedad asmática como el estilo de vida, estatus social, demografía, genética y hábitos dietéticos e higiénicos, considerando que entre hermanos fueran muy similares. Además, se ha tenido en cuenta artículos sobre población estudio de diferentes países para considerar el factor demográfico dentro del análisis de resultados (21, 54).
Conviene destacar la observación de Domenzain-Sánchez y cols., en su estudio transversal, que afirman que no existe asociación entre ambas patologías. A diferencia de los que sí encuentran asociación, en su mayoría, estudios longitudinales. Aun así, no por ello se niega la asociación, pero se confirma, por
Imagen cedida por la Dra. Clara Garcete, en Clínica Ciro.
48 CIENCIA Y CLÍNICA. Ciencia
Dental · N o 366 | Mayo 2024
Gaceta
una parte, la etiología multifactorial de ambas patologías, y por otra, la disparidad de resultados debido a sus m ú ltiples factores influyentes tanto genéticos como ambientales. Por tanto, es esencial dar a conocer la relación que tienen ambas para prevenir los problemas de salud oral y alteraciones dentoesqueléticas (53). La mayoría de los autores están de acuerdo en las manifestaciones orales halladas, siendo las más frecuentes la caries dental, gingivitis, erosión dental y pH ácido. Los autores relacionan el aumento de prevalencia de caries a la reducción salival producida por la farmacoterapia, ya que reduce el pH salival y aumenta la concentración de Streptococcus Mutans; así como otros lo asocian con los az ú cares contenidos en los medicamentos. Aunque hay otros autores como Brigic y cols. que opinan que el tratamiento intermitente no produce cambios permanentes en las glándulas salivales y la salud oral del niño. No obstante, hay autores que no han encontrado xerostomía en los resultados de sus estudios, a pesar de que los autores afirmen que la medicación produce tanto xerostomía como reducción de pH (1, 38). El pH ácido favorece la desmineralización y, con ello, aumenta el riesgo de caries. Asimismo, la bacteria Streptococcus Mutans es considerada la principal en el desarrollo de caries. A su vez, la candidiasis es un efecto colateral de la inmunosupresión provocada por los fármacos. Tanto es así que todos los autores recomiendan el enjuague bucodental posterior a la inhalación. A pesar de ello, no es suficiente con ingerir un vaso de agua, sino que hace falta el cepillado para evitar el establecimiento de
«La candidiasis es un efecto colateral de la inmunosupresión provocada por los fármacos. Tanto es así que todos los autores recomiendan enjuague bucodental posterior a la inhalación»
caries. Además, la erosión dental es debida al efecto miorrelajante derivado de la medicación, que con la intención de revertir la broncoconstricción produce la dilatación del m ú scu lo del esfínter esofágico inferior, siendo el reflujo el factor fundamental de la erosión dental. A pesar de ello, la dosis y el tipo de medicación, así como la vía de administración, también influyen en las consecuencias de la medicación; como la posibilidad del uso de espaciadores para disminuir los efectos secundarios (6, 9, 21).
Por otro lado, durante la infancia, los niños están en continuo crecimiento y desarrollo. Por esta razón, cualquier alteración en las estructuras involucradas puede originar desequilibrios en su anatomía y fisiología. En este aspecto, hay consenso de gran parte de los autores que afirman que las alteraciones anatómicas y fisiológicas de los niños asmáticos se deben a su respiración oral. A nivel exterior se puede observar un cambio postural a nivel cervical y un
49 Ciencia. CIENCIA Y CLÍNICA Gaceta Dental · N o 366 | Mayo 2024
excesivo crecimiento vertical que origina aspecto de cara larga. Durante la respiración oral, la lengua se coloca en una posición más baja para favorecer el paso del aire. Esta situación puede desarrollar diversas alteraciones, ya que impide el crecimiento transversal del maxilar, originando mordida cruzada posterior, apiñamiento, erupciones ectópicas de los primeros molares permanentes e incluso el desplazamiento de caninos a una posición más palatina. Todo ello ocurre a nivel transversal, pero a nivel anterior también afecta, ya que favorece la deglución atípica como alteración de la posición de la lengua al tragar, provocando mordida abierta anterior (1, 56).
CONCLUSIONES
El asma, junto con su farmacoterapia, se relaciona con un incremento de lesiones cariosas, gingivitis, erosi ó n dental y candidiasis orofarí ngea. La mayorí a de los autores consultados considera que existe una asociación directa entre la caries y el asma, respetando su origen multifactorial.
«Samec y cols. afirman la existencia de asociación directa entre la aparición de caries y el empleo diario de glucocorticoides inhalados»
Las medidas de prevenci ó n recomendadas incluyen: buena higiene y control de dieta, de enjuague y cepillado posterior a las inhalaciones, y aplicaciones frecuentes de flúor.
Al ser una patolog í a cró nic a frecuente en ni ñ os, requiere de un plan de prevenci ó n ind ividualizado y atenci ó n de los odontó log os como parte del equipo interdisciplinar. ●
BIBLIOGRAFÍA
1. RAMOS RÍOS JA, RAMÍREZ HERNÁNDEZ E, MIREYA VÁZQUEZ RODRÍGUEZ E, VÁZQUEZ NAVA F. Repercusiones en la salud bucodental asociadas con el asma en niños de 6 a 12 años de edad. Rev Alerg Mex [Internet]. 2017; 64 (3): 270–6. Available from: http://www.revistaalergia.mx
2. NAVARRETE RODRÍGUEZ E, JOSÉ J, SIENRA MONGE L, FIRETH POZO BELTRÁN C. Asma en pediatría. 2016; 59 (4): 5–15.
3. GIL LM, DE LA CRUZ A, LOZANO BLASCO J, GIL M, BLASCO L. Asma: aspectos clínicos y diagnósticos. 2019; 2: 103–15. Available from: www.aeped.es/protocolos/
4. BILITSKI MS, WENZEL S, CATHY, BSN V, AE-C RN, FAHY B ET AL. ¿Qué es el asma? Am J Respir Crit Care Med [Internet]. 2013; 188: 7–8. Available from: www.thoracic.org
50 CIENCIA Y CLÍNICA. Ciencia Gaceta Dental · N o 366 | Mayo 2024
Escanea el código QR con tu smartphone para acceder al listado de precios o accede a www.expadent.com/precios




YA DISPONIBLE EXPADENT APP


Hemos mejorado nuestro sistema de gestión, y ahora cualquiera de nuestros clientes podrán realizar los pedidos directamente desde nuestra aplicación, intuitivamente.

También permite hacer un seguimiento total del proceso de fabricación y de envío del pedido realizado. CORONA ZIRCONIO MULTICAPA 49,90 euros …y como siempre con los precios más competitivos del mercado






LÍDERES EN LA ELABORACIÓN DE PRÓTESIS DENTALES +34 910 059 139 info@expadent.com www.expadent.com LA ERA DIGITAL TAMBIÉN HA LLEGADO A EXPADENT MÁNDANOS TUS ARCHIVOS STL
NOS PONDREMOS MANOS A LA OBRA
Y
5. MORAL L, ASENSI MONZÓ M, JULIÁ BENITO JC, ORTEGA CASANUEVA C, PANIAGUA CALZÓN NM, PÉREZ GARCÍA MI, ET AL. Pediatric asthma: The REGAP consensus. An Pediatr (Engl Ed). 2021 Aug 1; 95 (2): 125.e1-125.e11.
6. SAMEC T, AMAECHI BT, JAN J. Influence of childhood asthma on dental caries: A longitudinal study. Clin Exp Dent Res. 2021 Dec 1; 7 (6): 957–67.
7. SKÖLD UM, BIRKHED D, XU JZ, LIEN KH, STENSSON M, LIU JF. Risk factors for and prevention of caries and dental erosion in children and adolescents with asthma. Vol. 17, Journal of Dental Sciences. Association for Dental Sciences of the Republic of China; 2022. p. 1387–400.
8. CORONA RIVERA J, PEÑA PADILLA C, MORALES DOMÍNGUEZ GE, ROMERO BOLAÑO YM. Genetic aspects involved in asthma. Rev Alerg Mex. 2022; 69 (1): 21–30.
9. ELYASSI GORJI N, NASIRI P, MALEKZADEH SHAFAROUDI A, MOOSAZADEH M. Comparison of dental caries (DMFT and DMFS indices) between asthmatic patients and control group in Iran: a meta-analysis. Asthma Res Pract. 2021 Dec; 7 (1).
10. VALLINA FERNÁNDEZ KELLY C, GRANDE BOLOQUE R, APOITA SANZ M, MONTAÑÉS DE LA FUENTES A, PAREDES RODRÍGUEZ V, HERNÁNDEZ VALLEJO G. Manejo y consideraciones clínicas de los pacientes asmáticos en la consulta dental. CientDent Coem. 2018; 15 (3): 217–24.
11. LÓPEZ PEREIRA P, MARÍA GANDARILLAS GRANDE A, DÍEZ GAÑÁN L, ORDOBÁS GAVÍN M, PATRICIA LÓPEZ
PEREIRA C. Evolución de la prevalencia de asma y factores sociodemográficos y de salud asociados en población de 18 a 64 años de la Comunidad de Madrid (1996-2013). Rev Esp Salud P ú bli ca [Internet]. 2017 May 25; 91: 1–14. Available from: www.msc.es/resp
12. BIMSTEIN E, WILSON J, GUELMANN M, PRIMOSCH RE. The Relationship Between Oral and Demographic Characteristics of Children with Asthma. The Journal of Pediatric Dentistry. 2006; 31 (2): 86–9.
13. CORTÉS RICO O. Tratamiento del asma. Rev Pediatr Aten Primaria Supl. 2013; 22:97–103.
14. TREVIÑO SALINAS MB, MUÑOZ MENDOZA D, GONZÁLEZ DÍAS SN, ARIAS CRUZ A, CHAPA RODRÍGUEZ A, RODRÍGUEZ ORTIZ PG. Prevalencia de respiraci ó n ora l y su efecto en el desempeño escolar en niños con alergia respiratoria. Medicina Universitaria. 2009; 11 (42): 17–21.
15. MARTIN REYES BAQUE JI, JARAMILLO BAQUE III Y, HIDALGO ACEBO RI, MARTIN REYES BAQUE J, LISSETTE CAJAPE GONZÁLEZ A, JARAMILLO BAQUE Y ET AL. Características clínicas y epidemiológicas del asma bronquial en niños. 2021; 7 (2): 1371–90. Available from: http:// dominiodelasciencias.com/ojs/index.php/es/index
16. GALLEGOS LÓPEZ L, MARTÍNEZ PÉREZ EM, PLANELLS DEL POZO P, MIEGIMOLLE HERRERO M. Efecto de los medicamentos inhalados en la salud oral de los pacientes asmáticos. Odontología Pediatrica. 2003; 11 (3): 102-10.
17. TORRES BORREGO J, CASANUEVA CO, TORTAJADAGIRBÉS M, BORREGO T, CASANUEVA O. Tratamiento del asma pediátrica. Tratamiento de la crisis de asma. Protoc diagn ter pediatr [Internet]. 2019; 2: 117–32. Available from: www.aeped.es/protocolos/
18. ZDANOWICZ MM. Pharmacotherapy of Asthma. Am J Pharm Educ. 2007; 71 (5).
19. HARRIS C. Asthma and the paediatric dental patient. Dental Nursing. 2013 Sep; 9 (9): 524-7.
20. AYINAMPUDI B, GANNEPALLI A, PACHA V, KUMAR J, KHALED S, NAVEED M. Association between oral manifestations and inhaler use in asthmatic and chronic obstructive pulmonary disease patients. J Dr NTR Univ Health Sci. 2016; 5 (1): 17.
21. ŚWI ĄTKOWSKA-BURY M, KULUS M, OLCZAK-KOWALCZYK D. The use of anti-asthmatic inhalation therapy and the risk of dental caries in a group of Polish children: a prospective study. Eur J Paediatr Dent. 2022; 23 (2): 157-62.
22. GODARA N, KHULLAR M, GODARA R, SINGH V. Evaluation of cariogenic potential of dry powder inhalers: A casecontrol study. Lung India. 2013 Apr; 30 (2): 113-6.
23. ÚBEDA SANSANO M, CORTÉS RICO O, MONTÓN ÁLVAREZ J, LORA ESPINOSA A, PRAENA CRESPO M. Dispositivos de inhalación El Pediatra de Atención Primaria y los dispositivos de inhalación. 2013.
24. RUIZ COBOS M, ARNALICH JIMÉNEZ M, CASANOVA ESPINOSA A. Tratamiento de mantenimiento y en la exacerbación asmática. Monografía NeumoMadrid XXI. 2013; 87–102.
25. DOCIO DE LERA D. Medicamentos para el tratamiento del asma en niños y sus repercusiones a nivel oral. 2014.
26. SANTOS NC, JAMELLI S, COSTA L, BARACHO FILHO C, MEDEIROS D, RIZZO JA, ET AL. Assessing caries, dental plaque and salivary flow in asthmatic adolescents using inhaled corticosteroids. Allergol Immunopathol (Madr). 2012 Jul; 40 (4): 220–4.
27. GODARA N, GODARA R, KHULLAR M. Impact of inhalation therapy on oral health. Vol. 28, Lung India. 2011. p. 272–5.
28. SANTOS MILANÉS H. Capitulo 87: Utilización de inhaladores [Internet]. Available from: http://www.eccpn.aibarra.org/ temario/seccion5/capitulo67/capitulo67.htm
29. ASHUJA R, NANDINI D, VIDYASAGAR B, ASHWINI R, DONOGHUE M, MADHUSHANKARI G. Oral carriage of cariogenic bacteria and Candida albicans in asthmatic adults before and after anti-asthma medication: A longitudinal study. J of Oral and Maxillofac Pathol. 2018 Jan 1; 22 (1): 144–5.
52 CIENCIA Y CLÍNICA. Ciencia Gaceta Dental · N o 366 | Mayo 2024
30. BRASIL OLIVEIRA R, CRUZ ÁA, SOUZA MACHADO A, PINHEIRO GP, INÁCIO D DOS S, SARMENTO VA, ET AL. Oral health-related quality of life in individuals with severe asthma. Jornal Brasileiro de Pneumologia. 2021; 47 (1): 1-7.
31. BRIGIC A, KOBASLIJA S, ZUKANOVIC A. Cariogenic Potential of Inhaled Antiasthmatic Drugs. Med Arch. 2015 Aug 1; 69 (4): 247–50.
32. RIZZO P. Consecuencias en la cavidad bucal del asma bronquial en niños y su prevención. 2013; 7 (1): 40–3.
33. PETERSON A.. The Need to Support Underprivileged Asthmatic Pediatric Dental Patients. 2018; 39 (2).
34. ARAFA A, ALDAHLAWI S, HUSSIEN A. Impact of Secretory Immunoglobulin A Level on Dental Caries Experience in Asthmatic Children. Int J Clin Pediatr Dent. 2019 Oct; 12 (5): 414–8.
35. GANI F, CAMINATI M, BELLAVIA F, BAROSO A, FACCIONI P, PANCERA P, ET AL. Oral health in asthmatic patients: a review: Asthma and its therapy may impact on oral health. Vol. 18, Clinical and Molecular Allergy. BioMed Central Ltd; 2020.
36. LLENA-PUY C. The rôle of saliva in maintaining oral health and as an aid to diagnosis. Med Oral Patol Oral Cir Bucal. 2006; 11: 449–55.
37. THOMAS MS, PAROLIA A, KUNDABALA M, VIKRAM M. Asthma and oral health: A review. Vol. 55, Australian Dental Journal. 2010. p. 128–33.
38. BRIGIC A, KOBASLIJA S, ZUKANOVIC A. Antiasthmatic Inhaled Medications as Favoring Factors for Increased Concentration of Streptococcus Mutans. Materia Socio Medica. 2015; 27 (4): 237.
39. DONG J, LI W, WANG Q, CHEN J, ZU Y, ZHOU X, ET AL. Relationships Between Oral Microecosystem and Respiratory Diseases. Vol. 8, Frontiers in Molecular Biosciences. Frontiers Media S.A.; 2022.
40. ARAFA A, ALDAHLAWI S, FATHI A. Assessment of the oral health status of asthmatic children. Eur J Dent. 2017; 11 (3): 357–63.
41. BOZEJAC BV, STOJŠIN I, Đ URIĆ M, ZVEZDIN B, BRKANIĆ T, BUDIŠIN E, ET AL. Impact of inhalation therapy on the incidence of carious lesions in patients with asthma and COPD. Journal of Applied Oral Science. 2017 Sep 1; 25 (5): 506–14.
42. CÁCERES P, CAROLA T. CONSIDERACIONES DEL ASMA EN ODONTOLOGíA PEDIÁTRICA. Odontol Pediatr. 2006; 5 (2): 13–9.
43. HELI VIEIRA B, MILLENA M, BRANDÃO V. Dental Caries in Children With Asthma: A Mini-Review. Res Pediatr Neonatol. 2021; 6 (2): 505–6.
44.MARKOVIĆ D, PERIĆ T, SOVTIĆ A, MINIĆ P, PETROVIĆ V. Oral health in children with asthma. Srp Arh Celok Lek. 2015; 143 (9–10): 539–44.
45. GUGGENHEIMER J, MOORE PA. The Patient with Asthma: Implications for Dental Practice. Compendium [Internet]. 2009; 30 (4): 200–8. Available from: www.compendiumlive. com
46. CHILLÓN G, DOMÍNGUEZ C, SUAREZ C, DOMÍNGUEZ RA. Repercusiones bucodentales del asma en la infancia y adolescencia. VoxPaediatrica. 2011; XVIII (2): 22–9.
47. DO ĞAN M, ŞAHINER ÜM, ATAÇ AS, BALLIKAYA E, SOYER ÖU, ŞEKEREL BE. Oral health status of asthmatic children using inhaled corticosteroids. Turkish Journal of Pediatrics. 2021; 63 (1): 77–85.
48. RUSSELL L. Dental Anxiety, Dental Health Attitudes, and Bodily Symptoms as Correlates of Asthma Symptoms in Adult Dental Patients with Asthma. Journal of Dental Hygiene [Internet]. 2004; 78 (3). Available from: www. ingenta.com.
49. CHHABRA K, SOOD S, SHARMA N, SINGH A, NIGAM S. Dental management of pediatric patients with bronchial asthma. Vol. 14, International Journal of Clinical Pediatric Dentistry. Jaypee Brothers Medical Publishers (P) Ltd; 2021. p. 715–8.
50. HARRINGTON N, PRADO N, BARRY S. Dental treatment in children with asthma - A review. Br Dent J. 2016 Mar 25;220(6):299–302.
51. GUTIÉRREZ LIZARDI P, GUTIÉRREZ JIMÉNEZ HA. Urgencias médicas en odontología. 2012.
52. GONZÁLEZ RUÍZ I. Urgencias y emergencias en el gabinete dental. Sevilla; 2016.
53. DOMENZAIN SÁNCHEZ BA, CHUC GAMBOA MG, AGUILAR PÉREX FJ, PINZÓN TE AL, REJÓN PERAZA ME, ESPARZA VILLALPANDO V. Manifestaciones bucales en pacientes pediátricos con asma. Estudio de Casos Controles. Revista de Odontopediatría Latinoamericana. 2021 Jul 1;11(2).
54. WU F YI, LIU J FEN. Asthma medication increases dental caries among children in Taiwan: An analysis using the National Health Insurance Research Database. J Dent Sci. 2019 Dec 1;14(4):413–8.
55. BANSAL V, REDDY K, SHRIVASTAVA S, DHADED S, NOORANI S, SHAIKH M. Oral health assessment in children aging 8-15 years with bronchial asthma using inhalation medication. Tzu Chi Med J. 2022 Apr 1;34(2):239–44.
56. CASTAÑEDA ZETINA J, CHUC GAMBOA MG, AGUILAR PÉREZ FJ, PINZÓN TE AL, ZÚÑIGA HERRERA ID, ESPARZA VILLALPANDO V. Malocclusions in Pediatric Patients with Asthma: A Case–Control Study. Healthcare (Switzerland). 2022 Aug 1;10(8).
53 Ciencia. CIENCIA Y CLÍNICA Gaceta Dental · N o 366 | Mayo 2024


Tenemos un libro para cada profesional dental
tienda.gacetadental.com y elige: ¿cuál es el tuyo?


¡Accede a la tienda!















Organiza:
Impulsa:

Ciencia y clínica
Magnificación en Odontología restauradora
«Solo podemos tratar lo que podemos ver»

DR. JESÚS
OSTOS
Licenciado en Odontología. Universidad Santa María (Venezuela). Especialista en Estomatología Integral del Adulto. Universidad Santa María.
Especialista en Implantología. CPO Uninga São Paulo (Brasil).
Miembro activo de la Academia Latinoamericana de Oseointegración (ALAO).
Miembro activo de Digital Dental Craftsmen. Director de Dentimpact.
El uso de la magnificación juega un papel sumamente importante y/o indispensable en la Odontología moderna. Estamos en una profesión donde se requieren habilidades motoras precisas guiadas por una agudeza visual, la cual es muy limitada. Es entonces donde podemos conseguir diferentes opciones en el mercado para mejorar estas limitaciones: desde lupas simples o compuestas hasta microscopios.
El microscopio es un instrumento diseñado para magnificar nuestra visión a niveles sin precedentes y permitirnos realizar diagnósticos y tratamientos con precisión. Esto nos da la oportunidad de mejorar la calidad de nuestros procedimientos y realizar una Odontología extremadamente conservadora con el diente (1).
Existen tres conceptos clave que ayudan a dimensionar la utilidad del microscopio: la magnificación, la iluminación y la documentación. La magnificación es determinada por la
potencia del ocular, la longitud focal de los binoculares, el regulador de los factores de aumento y la longitud focal del objetivo. La iluminación de los microscopios es coaxial con la línea de visión, lo que permite que se pueda ver el campo de visión sin sombras. Al ser paralela la luz, se evita la convergencia ocular, manteniendo los ojos en reposo, y así poder realizar procedimientos prolongados sin fatiga ocular. Además, a través de diferentes aditamentos, ofrece la capacidad para la documentación de todo el procedimiento clínico (2).
Actualmente es muy conocido el uso del microscopio en el área de la Endodoncia, pero cada día la popularidad de estos dispositivos va ganando terreno en diferentes especialidades, debido a los innumerables beneficios, accesorios y herramientas que pueden hacer aplicadas a las áreas de Cirugía, Periodoncia, Odontología restauradora y la técnica dental. Durante varias décadas, muchos técnicos de laboratorio dental han utilizado
56 Gaceta Dental · N o 366 | Mayo 2024 CIENCIA Y CLÍNICA. Informe
«Existen tres conceptos clave que ayudan a dimensionar la utilidad del microscopio: la magnificación, la iluminación y la documentación»
microscopios estereoscópicos para recortar matrices, refinar piezas fundidas y realizar otros procedimientos que requieren un alto grado de precisión (3).
La Odontología restauradora y la cirugía son disciplinas muy exigentes a nivel visual y postural. La necesidad de ver en detalle estructuras anatómicas muy pequeñas requiere, en muchas ocasiones, acercarse en exceso sobre el área de tratamiento, lo que da a lugar a posturas inadecuadas y forzadas. Trabajar a distancias muy próximas supone, además, someter a nuestro sistema visual a una situación de esfuerzo constante.
Todos los profesionales dentales deben considerar el uso de la mejora visual adecuada para hacer que la práctica de la Odontología sea más precisa, más fácil, más placentera y para reducir el riesgo de lesiones musculoesqueléticas (1).

Con el microscopio Flexion Twin de CJ-Optik (Figura 1) tenemos la capacidad de un aumento mínimo de 1,5X (escala diferente que la de las lupas porque es la suma del aumento de varias lentes) en el que disponemos de un gran campo de visión, muy útil para tener una visión generalizada de toda la cavidad bucal. A partir de ahí, disponemos de un cambiador de aumentos (en un rango de 0,4/0,63/1/1,6/2,5) que permite llegar a conseguir una magnificación de hasta 20X y que dependerá también de la distancia del objetivo al área de tratamiento. Además, herramientas como el VarioFocus, con el que podemos realizar el ajuste fino sin necesidad de modificar la distancia de trabajo, nos permite un dinamismo visual que facilita el poder cambiar de aumento según sea nuestra necesidad en las
57 Gaceta Dental · N o 366 | Mayo 2024 Informe. CIENCIA Y CLÍNICA
Microscopio Twin Blue.
«La magnificación por sí sola no es suficiente para conseguir un campo de visión completo y claro de la zona a tratar»
mejorar el rendimiento y longevidad profesional. El uso de magnificación permite trabajar a una mayor distancia del paciente con una postura más saludable, con la espalda recta y evitando inclinaciones forzadas del cuello.
diferentes partes del tratamiento que estemos realizando.
Otro dato importante es el hecho de que el 80% de odontólogos, cirujanos, veterinarios y otros profesionales relacionados sufren dolor de cuello y molestias lumbares, con una prevalencia mucho más elevada que la población en general. Esto viene acompañado de fatiga, dolor, incomodidad, dificultad para mantener la concentración mental y molestias en tu cuello y espalda, por lo que la magnificación ayuda a
La magnificación por sí sola no es suficiente para conseguir un campo de visión completo y claro de la zona a tratar. La cantidad y calidad de la luz en el campo de trabajo es tan importante como el grado de aumento. Por esta razón, los microscopios incorporan una potente fuente de luz (LED o xenón), que se transmite por el mismo camino por donde observamos, dando como resultado una iluminación perfecta de la zona de trabajo por muy profunda y oscura que sea. Por eso, el microscopio Flexion Twin cuenta con una potente luz LED de hasta 200.000 lux (modelo Flexion Twin White) y una temperatura de luz de 5.500 K y filtros que tienen una gran utilidad a la hora de trabajar en el día a día como rehabilitador oral.

58 Gaceta Dental · N o 366 | Mayo 2024 CIENCIA Y CLÍNICA. Informe
Figura 1. Microscopio Flexion Twin de CJ-Optik.
FILTROS Y SUS USOS EN REHABILITACIÓN ORAL
Solo podemos tratar lo que podemos ver, por lo que el sistema de filtros selectivos (Figura 2) se hace indispensable para alcanzar tratamientos más eficientes y precisos. Flexion Twin de CJOptik cuenta con varios filtros selectivos que facilitan el trabajo del odontólogo:
-Filtro de fluorescencia (Figura 3) : muy útil para dar visibilidad a materiales y superficies fluorescentes, gracias a su modo de visualización con luz ultravioleta (UV). En Odontología, una de las propiedades más importantes
que deben de tener los materiales restauradores para imitar el comportamiento del diente natural es la fluorescencia. Esta viene dada por componentes añadidos luminóforos que hacen visible cualquier tipo de restauración, atache, exceso de cemento, fisura, sarro, profundidad de lesiones y hasta placa bateriana que pueda haber sobre la superficie del diente. Por ello, es una herramienta que, en el día a día, nos ayuda a convertir visible lo invisible. Disponible en la versión Flexion Twin Blue.
-Filtro antiglare (antibrillo) (Figura 4) : la toma de color en Odontología es uno de los pasos cruciales para el éxito de nuestros



 Figura 3. Filtro de fluorescencia.
Figura 4. Filtro antiglare (antibrillo).
Figura 5. Filtro naranja.
Figura 3. Filtro de fluorescencia.
Figura 4. Filtro antiglare (antibrillo).
Figura 5. Filtro naranja.
59 Gaceta Dental · N o 366 | Mayo 2024 Informe. CIENCIA Y CLÍNICA
Figura 2. Detalle del joystick para el manejo de la selección de filtros.
tratamientos restauradores estéticos. Este filtro antiglare es un gran aliado, ya que nos permite eliminar el brillo de la imagen que vemos y capturamos, facilitándonos el poder adentrarnos y ser más precisos en la selección y comunicación del color con nuestro protésico dental y/o permitiéndonos seleccionar la masa del material de elección que cumpla con lo necesario en cuanto a matiz, croma y valor para cada caso.
-Filtro Natural Light: todos sabemos que realizar una restauración directa a mano alzada en resina compuesta es una tarea que necesita de mucho conocimiento, destreza y, sobre todo, tiempo para poder plasmar todos los detalles y características anatómicas que tiene un diente natural. Este filtro permite prolongar el tiempo de manipulación de los materiales fotosensibles en el que, a su vez, podemos tener una referencia visual del color del material e incluso hacernos una idea del cómo quedará nuestra restauración final.
-Filtro naranja (Figura 5 ): este filtro permite que la alta potencia de la luz del microscopio no active la reacción en cadena de la polimerización, producto de la energía lumínica recibida por el material.
-Filtro verde: es el gran aliado en cuanto a contraste de sangre y tejido se refiere, filtro ideal y también incluido en la versión Flexion Twin Blue.
Ciertamente se requiere de una curva de aprendizaje para el uso de este tipo de dispositivos y es necesario incorporar protocolos al equipo de trabajo y el uso de microinstrumentos que permitan adaptarse al campo de visión aumentado, pero reducido, que ofrece el microscopio dental (4). Por supuesto, el resultado merece la pena, consiguiendo una mayor ergonomía, menor fatiga para el profesional, así como tratamientos de mayor calidad y menos invasivos para el paciente. Definitivamente, nos ayuda a conseguir un nivel más alto de Odontología. ●
BIBLIOGRAFÍA
1. FRIEDMAN M. Magnification in a restorative dental practice: from loupes to microscopes. Compend Contin Educ Dent. 2004 Jan; 25 (1): 48, 50, 53-5.
2. DEL FABBRO M, TASCHIERI S, LODI G, BANFI G, WEINSTEIN RL. No evidence that magnification devices improve the success of endodontic therapy. Evid Based Dent. 2016; 17: 84-85.
3. CARR GB, MURGEL AF. The use of the operating microscope in endodontics. Dent Clin N Am. 2010; 54 (2): 191-214.
4. FRIEDMAN M, MORA AF, SCHMIDT R. Microscope-assisted precision dentistry. Contin Educ Dent. 1999 Aug; 20 (8): 7238, 730-1, 735-6; quiz 737.
5. MORADAS ESTRADA M. Importancia de la magnificaci ó n en odontolog í a conservadora: revisi ó n bib liográ fica . Av Odontoestomatol. 2017; 33 (6): 283-293.
60 Gaceta Dental · N o 366 | Mayo 2024 CIENCIA Y CLÍNICA. Informe











Di 2 gital al dí 2 a Carga inmediata con prótesis prefabricada y protocolos Di2gitalArch®
Caso bimaxilar con implantes yuxtaóseos y convencionales

PDR. LUIS CUADRADO DE VICENTE
MD DDS i2 Implantología Madrid.
Dra. Cristina Cuadrado Canals
DDS i2 Implantología Madrid.
Dr. Luis Cuadrado Canals
DDS i2 Implantología Madrid.
Dra. Fedra Coraspe
DDS Custom Implants.
Dra. Sara Perrone
DDS i2 Implantología Madrid.
Roberto Vives
TPD Laboratorio «Dental Full Digital» Madrid.
Ignacio Montiel
TPD Laboratorio «Dental Full Digital» Madrid.
resentamos un caso práctico bimaxilar tratado en dos tiempos quirúgicos. Inicialmente se trató el maxilar superior mediante un implante yuxtaóseo diseñado y fabricado por Custom Implants y al mes se trató el maxilar inferior mediante implantes convencionales, ambos con prótesis fija provisional inmediata, en el día de la cirugía.
Se trata de una paciente de 70 años, sin antecedentes médicos de interés, portadora de prótesis superior completa desde hace muchos años y dentición terminal en la parte anterior del maxilar inferior. Además de los problemas funcionales de alimentación, deglución y masticación, presentaba un evidente problema estético.
La paciente había sido desahuciada en numerosas ocasiones y rechazaba cualquier abordaje terapéutico que incluyera un tratamiento mediante injertos óseos. Primaba el recibir un tratamiento inmediato para solucionar tanto
62 Gaceta Dental · N o 366 | Mayo 2024 DI 2GITAL AL DÍ 2 A. Caso clínico
«La cirugía debe ser extremadamente precisa para que los implantes estén en la posición exacta planificada y la prótesis ajuste pasivamente y en el lugar protéticamente predeterminado»
los problemas funcionales como la mejora de su aspecto estético.
CASO CLÍNICO (FIGURAS 1-42)
Inicialmente se realizó una OPG y CBCT bimaxilar. Mientras el maxilar inferior era perfectamente tratable mediante implantes convencionales, el maxilar superior presentaba una evidente atrofia. Excluyendo los injertos óseos, las únicas dos opciones eran los implantes cigomáticos y los implantes yuxtaóseos.
En esta época del doctor Google no son raros los pacientes que rechazan de plano los implantes cigomáticos; de hecho, es lo primero que comparten en su primera consulta. Obviamente se debe al desconocimiento sobre esta técnica y a muchos vídeos en internet de escasísima calidad que no transmiten lo que es esta técnica.
En esta paciente, además de su negativa personal, estaba indicado también por la morfología ósea un implante yuxtaóseo.








Para su diseño es necesario realizar un TAC helicoidal con técnica de doble CT con marcadores en su completa. Se decidió así para poder diseñar la posición de las conexiones en la localización óptima, en función de su prótesis, pero teniendo en cuenta la adecuada proyección anterior de la nueva prótesis fija.
Una vez diseñado el implante yuxtaóseo, en este caso con conexiones MU, Custom Implants envió al laboratorio el archivo con la posición espacial de las conexiones. De esta manera, y también gracias al archivo del escaneado intraoral con la prótesis con sus marcadores radiopacos, el laboratorio DDF puede diseñar y fabricar la prótesis provisional inmediata antes de la
63 Gaceta Dental · N o 366 | Mayo 2024 Caso clínico. DI 2GITAL AL DÍ 2 A
Figura 1. Rx preoperatoria.




intervención. Así pues, la intervención se llevó a cabo bajo anestesia local y sedación consciente. Obviamente, la cirugía debe ser extremadamente precisa para que los implantes estén en la posición exacta planificada y la prótesis ajuste pasivamente y en el lugar protéticamente predeterminado.
Se colocó una fijación en cada hemimaxilar y, finalizada, se colocó la prótesis directa a las conexiones MU con un ajuste perfecto. La OPG que se muestra en las figuras muestra un ligero desajuste en el sector 1 debido a que, en la cirugía, no se apretó en condiciones la prótesis.
Pasado un mes se trató el maxilar inferior con exodoncias y colocación de implantes convencionales, también con pilares MU y escaneado intraoral, y el mismo día se colocó una prótesis fija provisional. El postoperatorio de ambas intervenciones fue










extraordinario y la mejora estética y funcional de la paciente, absoluta. Una de las enormes ventajas de la provisionalización inmediata es, sin lugar a dudas, la información que nos proporciona para la prótesis final. En este sentido, en este caso presentamos las prótesis definitivas, ambas con estructura de titanio y estructura estética Ivotion, realizadas por el laboratorio Digital Future de Madrid. Se realizaron mínimas modificaciones del resultado de la profesionalización inmediata. El resultado del tratamiento ha sido enormemente satisfactorio para la paciente y para el equipo de tratamiento, mejorando tremendamente su función y estética. Muchas gracias a Phibo, Custom Implants y al laboratorio Digital Future por su excelente implicación en este caso complicado, que se ha transformado en sencillo. ●













 Figura 2. Intraoral preoperatoria.
Figura 3. Preoperatoria sin la prótesis completa.
Figura 4. Intraoperatoria yuxtaósea Custom Implants.
Figura 2. Intraoral preoperatoria.
Figura 3. Preoperatoria sin la prótesis completa.
Figura 4. Intraoperatoria yuxtaósea Custom Implants.
64 Gaceta Dental · N o 366 | Mayo 2024 DI 2GITAL AL DÍ 2 A. Caso clínico
Figura 5. Guía de asentamiento.

























































 Figura 6. Prótesis realizada preoperatoriamente.
Figura 7. Resultado intraoperatorio con la prótesis provisional.
Figura 8. Ajuste provisional prefabricado.
Figura 9. Revisión al mes.
Figura 10. Escaneado del Trios para la parte inferior.
Figura 11. Escaneado con Trios parte inferior. Carga inmediata.
Figura 12. Detalle escaneado. Carga inmediata inferior.
Figura 6. Prótesis realizada preoperatoriamente.
Figura 7. Resultado intraoperatorio con la prótesis provisional.
Figura 8. Ajuste provisional prefabricado.
Figura 9. Revisión al mes.
Figura 10. Escaneado del Trios para la parte inferior.
Figura 11. Escaneado con Trios parte inferior. Carga inmediata.
Figura 12. Detalle escaneado. Carga inmediata inferior.
66 Gaceta Dental · N o 366 | Mayo 2024 DI 2GITAL AL DÍ 2 A. Caso clínico
Figura 13. Sin información de color.























































 Figura 14. Conexiones MU carga inmediata inferior.
Figura 15. Prótesis inmediata tres horas después.
Figura 16. Colocación.
Figura 17. Colocación.
Figura 18. Tornillo MU.
Figura 19. Prótesis inmediata colocada.
Figura 20. Detalle.
Figura 14. Conexiones MU carga inmediata inferior.
Figura 15. Prótesis inmediata tres horas después.
Figura 16. Colocación.
Figura 17. Colocación.
Figura 18. Tornillo MU.
Figura 19. Prótesis inmediata colocada.
Figura 20. Detalle.
67 Gaceta Dental · N o 366 | Mayo 2024 Caso clínico. DI 2GITAL AL DÍ 2 A
Figura 21. Resultado con las provisionales.























































 Figura 22. Vista lateral.
Figura 23. Vista lateral.
Figura 24. Sonrisa inmediata.
Figura 25. Rx postoperatoria.
Figura 26. Control gingival yuxtaóseo.
Figura 27. Control inferior.
Figura 28. Control inferior tres meses.
Figura 22. Vista lateral.
Figura 23. Vista lateral.
Figura 24. Sonrisa inmediata.
Figura 25. Rx postoperatoria.
Figura 26. Control gingival yuxtaóseo.
Figura 27. Control inferior.
Figura 28. Control inferior tres meses.
68 Gaceta Dental · N o 366 | Mayo 2024 DI 2GITAL AL DÍ 2 A. Caso clínico
Figura 29. Control yuxtaóseo tres meses.























































 Figura 30. Prótesis definitiva superior.
Figura 31. Vista interna de la prótesis definitiva superior.
Figura 32. Colocación.
Figura 33. Colocación.
Figura 34. Prótesis colocada.
Figura 35. Vista oclusal.
Figura 36. Situacion inferior en la colocación definitiva.
Figura 30. Prótesis definitiva superior.
Figura 31. Vista interna de la prótesis definitiva superior.
Figura 32. Colocación.
Figura 33. Colocación.
Figura 34. Prótesis colocada.
Figura 35. Vista oclusal.
Figura 36. Situacion inferior en la colocación definitiva.
69 Gaceta Dental · N o 366 | Mayo 2024
DI 2GITAL AL DÍ 2 A
Figura 37. Prótesis definitiva inferior.
Caso clínico.

































¡CONSIGUE EL LIBRO DEL DR. LUIS CUADRADO DE VICENTE EN LA TIENDA GACETA DENTAL!


70 Gaceta Dental · N o 366 | Mayo 2024 DI 2GITAL AL DÍ 2 A. Caso clínico
Figura 38. Vista interna.
Figura 39. Prótesis colocada.
Figura 40. Vista oclusal.
Figura 41. Resultado final.
Figura 42. Rx definitiva.









Acorta tu tratamiento con la superficie más novedosa.



















Tiempo record de oseointegración
Stands E37-E38 Taller de elevación de seno fácil y segura con CAS - LAS Kit. Dr. Berrazueta.
Ciencia y clínica
La solución de restauración SmART
Una serie de casos

DR. KHALED ALY NOUR
Licenciado y Doctorado en cirugía dental. Profesor asociado de Odontología Operativa en la Universidad AinShams de El Cairo (Egipto). Fundador del Equipo de Rehabilitación Oral Conservadora y Estética (CORE, por sus siglas en inglés).
Antes del desarrollo de los híbridos de vidrio, el cemento de ionómero de vidrio era el único restaurador en Odontología cuyas propiedades mecánicas y ópticas mejoraban día a día (1). Estas clases de restauradores brillantes poseen una serie de propiedades únicas que no están disponibles en ningún otro restaurador y les permiten ser una solución inteligente para una gran variedad de retos clínicos ante los que cualquier otro material se quedaría corto.
Son los únicos materiales que pueden adherirse a los tejidos dentales afectados por la caries de forma similar a los tejidos dentales sólidos (2, 3), lo que los convierte en la mejor opción de restauración para el sellado de las superficies de contacto con el esmalte o la dentina desmineralizados y afectados por la caries. Pueden insertarse en bloque sin provocar fuerzas de contracción destructivas que puedan romper el sellado obtenido o agrietar el esmalte debilitado (4-7). Por lo tanto, ofrecen una solución conservadora
inteligente en una serie de casos con destrucción extensa de caries en los que es inevitable recurrir a restauraciones indirectas en caso de que se elimine el esmalte debilitado. También tienen un efecto anticariogénico que resulta muy útil en retos con un riesgo elevado de caries (8, 9) y en el sellado de grietas y defectos propensos a caries cuando su eliminación complicaría el diseño de la cavidad (10).
Los híbridos de vidrio y los ionómeros de vidrio son los únicos restauradores respetuosos con la pulpa que pueden conseguir una restauración y una protección de ésta en un solo paso sencillo y, por lo tanto, se recomiendan para casos en los que las pulpas están comprometidas y amenazadas (11). Al ser los únicos materiales autoadherentes y de obturación en bloque que no necesitan ningún procedimiento de adhesión, el procedimiento de introducción es el más rápido en Odontología (12, 13). Son lo suficientemente rápidos para ser transportados
72 Gaceta Dental · N o 366 | Mayo 2024 CIENCIA Y CLÍNICA. Informe
«Aquí se discuten situaciones clínicas en las que un híbrido de vidrio se ofrece como la opción más inteligente a la vista de las pruebas disponibles actualmente presentes en la bibliografía dental»
bajo el aislamiento de rollos de algodón en menos de dos minutos, lo que, a su vez, los impone como la mejor solución para la Odontología geriátrica y pediátrica y en casos en los que la aplicación del dique de goma es difícil o molesta (14).
Los ionómeros de vidrio y los híbridos de vidrio no se disuelven en los fluidos orales (15). Sin embargo, en los desafíos de caries graves en los que el pH local cae por debajo de 5,5 y justo antes de que se produzca la desmineralización (16), su superficie actúa como un ánodo de sacrificio para aumentar el pH y liberar Ca2+, PO4- y F-, que contrarrestan la desmineralización y estimulan la remineralización (8, 17).
Con la introducción de la tecnología de híbridos de vidrio hemos ampliado su aplicación a zonas sujetas a tensión, tales como cavidades compuestas y complejas. Esta innovadora tecnología nos brinda la oportunidad de aprovechar al máximo los beneficios de este excepcional material restaurador, especialmente en el sector posterior (1, 18, 19).
Las únicas dos herramientas al alcance del clínico para mejorar el éxito de sus tratamientos son, en primer lugar, la selección de la línea de tratamiento más adecuada y, en segundo lugar, la capacidad para manipular los restauradores de forma que maximicen sus beneficios y minimicen sus deficiencias. Aquí se discuten situaciones clínicas en las que un híbrido de vidrio se ofrece como la opción más inteligente a la vista de las pruebas disponibles actualmente presentes en la bibliografía dental.
Las opciones se basan en los beneficios obtenidos frente al coste de tiempo, esfuerzo y, lo que es más
73 Gaceta Dental · N o 366 | Mayo 2024 Informe. CIENCIA Y CLÍNICA


Figura 1. (a) Segundo molar inferior de una mujer de 56 años de edad después de la eliminación de amalgama. La pieza tenía paredes delgadas remanentes con una grieta en la pared distal y un opérculo localizado en la misma zona que imposibilitaba prácticamente la restauración. (b) La pieza se restauró con híbrido de vidrio EQUIA Forte HT (GC). Caso del Dr. Amr El-Deeb.




Figura 2. (a) Cavidad oclusal en un primer molar inferior resultante de una lesión de caries extensa. Las paredes vestibular, lingual y mesial están debilitadas, pero son estructuralmente continuas. (b) La eliminación del esmalte debilitado dio como resultado una cavidad complicada no retentiva que no se puede restaurar directamente. (c) La misma situación, conservando el esmalte y (d) la pieza se restauró con híbrido de vidrio EQUIA Forte HT (GC). Casos de los Dres. Khaled Adel y Mona Galal.
74 Gaceta Dental · N o 366 | Mayo 2024 CIENCIA Y CLÍNICA. Informe
importante, el sacrificio de los tejidos dentales.
1. Sellado de grietas marginales (figura 1)
Cuando la eliminación de grietas marginales complica, en gran medida, la restauración de la cavidad, sellar las grietas se convierte en la mejor opción. Se puede colocar el híbrido de vidrio, cariostático, «autosellante», sin necesidad de extender la cavidad para eliminar la grieta. El breve tiempo de aislamiento necesario para la colocación de este restaurador permite la inserción sin necesidad de aplicar diques de goma. El bajo estrés de contracción no ejercerá ninguna fuerza dañina sobre las cúspides débiles y sus propiedades de alta resistencia mantendrán la integridad dental hasta que se complete la erupción pasiva y se pueda realizar la restauración final.
2. Presencia de esmalte estructuralmente integral pero debilitado (figura 2)
En algunos casos, la cavidad está rodeada por esmalte debilitado, pero estructuralmente sólido. El fraguado sin tensión de un híbrido

de vidrio permite la restauración de dichas caries sin comprometer ni agrietar el esmalte debilitado. Este tipo de esmalte puede sobrevivir bien bajo fuerzas masticatorias y funcionales normales y puede retener adecuadamente una restauración directa. Un material muy retráctil, como el composite, provocaría un agrietamiento y, por último, la fractura del esmalte. La eliminación de este tejido debilitado para satisfacer las necesidades de colocación de un composite puede crear una condición compleja y no retentiva que también sería muy difícil de restaurar de forma directa.
3. Eliminación parcial de caries (figura 3)
Siempre que haya riesgo de afectación pulpar, se puede optar por una eliminación parcial de las caries para prevenir daños al tejido pulpar. Por lo tanto, el material de restauración seleccionado debe humedecer y sellar la dentina afectada por la caries, lo que no se puede lograr con restauraciones a base de resina. Un híbrido de vidrio puede cumplir con estos requisitos y


75 Gaceta Dental · N o 366 | Mayo 2024 Informe. CIENCIA Y CLÍNICA
Figura 3. (a) Primer molar superior en el que se eliminaron parcialmente las caries. (b) La cavidad se restauró con híbrido de vidrio EQUIA Forte HT (GC). (c) A los 4 años de seguimiento. Caso de la Dra. Mona Galal.
adherirse a la dentina afectada por la caries de forma similar a la de la dentina profunda. Es crucial facilitar el proceso de reparación dental, y se ha evidenciado que los híbridos de vidrio contribuyen a la mejora de la remineralización, alcanzando hasta 1,5 mm de profundidad en dentina desmineralizada. Esta característica destaca su potencial para apoyar en la restauración del tejido dental afectado.
4. Presencia de caries de contacto inicial en la superficie proximal adyacente (figura 4) Siempre que se coloque una restauración próxima en contacto con una lesión cariosa inicial.

Emplear híbridos de vidrio para que la restauración esté en contacto con esta lesión inicial permitiría la prevención de la progresión de la caries y ayudaría a la remineralización de esta lesión no cavitada. De este modo, se evita la restauración y la preparación tradicional de la cavidad.
5. Presencia de esmalte desmineralizado en los márgenes de la cavidad (figura 5)
En algunos casos, el margen de la cavidad implica esmalte desmineralizado cuya eliminación complicaría, en gran medida, el caso. Materiales a base de híbridos de vidrio o ionómero de vidrio pueden adherirse

Figura 4. (a) Primer molar inferior con una lesión cariosa en la superficie mesial que requirió preparación de la cavidad. El segundo premolar adyacente presentaba una lesión cariosa en esmalte en la superficie distal que no mostraba cavitación y (b) una DEJ radiográficamente sólida. Caso del Dr. Khaled Adel.


Figura 5. (a) Molar permanente inferior con desmineralización circunferencial cervical y cavidad simple de clase II en la superficie mesial en un niño de 11 años. (b) La cavidad se restauró con EQUIA Forte HT (GC). Caso del Dr. Amr El-Deeb.
76 Gaceta Dental · N o 366 | Mayo 2024 CIENCIA Y CLÍNICA. Informe

Figura 6. Mujer de 38 años que se queja de un defecto estético debido a una lesión cariosa en la superficie vestibular de un primer premolar inferior. (a) Vista preoperatoria. (b) Después de la preparación de la cavidad. La lesión se extendió apicalmente hasta el surco gingival y pulpar hasta que la sombra pulpar fue obvia, pero sin exposición pulpar detectada. (c) Después de la restauración con EQUIA Forte HT (GC). Caso del Dr. Amr El-Deeb.
a este esmalte débil sin dañarlo, mantiene los márgenes bien sellados e, incluso, ayuda a su remineralización. Si el composite se aplica en dicha cavidad, su contracción de polimerización rompería el esmalte tan débil y provocaría microfiltraciones con la consiguiente decoloración y caries recurrentes.
6. Aproximación gingival o pulpar (figura 6)
En casos de lesiones cariosas extensas con extensiones subgingivales o aproximación pulpar, los híbridos de vidrio son una opción excelente dado que no contienen productos químicos cáusticos ni constituyentes irritantes residuales que puedan dañar químicamente la pulpa. La reacción de fraguado no va acompañada de una acumulación de calor que pueda elevar la temperatura pulpar o las tensiones de contracción que pueden romper un puente delgado de la dentina.
La buena capacidad de sellado proporciona un entorno de curación
«Con la introducción de la tecnología de híbridos de vidrio hemos ampliado su aplicación a zonas sujetas a tensión, tales como cavidades compuestas y complejas»
perfecto para la pulpa estresada, lejos de bacterias e irritantes orales. Por otra parte, son bien tolerados por el tejido blando, especialmente si se fija contra una matriz y después y se aplica seguidamente su barniz de nanorecubrimiento.
La tolerancia a la humedad y el breve tiempo de aislamiento necesarios para su colocación se
77 Gaceta Dental · N o 366 | Mayo 2024 Informe. CIENCIA Y CLÍNICA


7. (a) Segundo molar superior aislado con una cavidad oclusal-distal profunda que llega al área de furcación de la raíz cóncava. El aislamiento con dique no pudo conseguir un buen sellado durante más de tres minutos y ningún sistema matricial podía adaptarse sin problemas y sellar herméticamente el asiento gingival. (b) Diente restaurado con EQUIA Forte HT (GC). Caso del Dr. Khaled Adel.


8. (a) MOD en el segundo premolar superior de una mujer de 71 años. La cúspide bucal estaba debilitada, pero no estaba implicada en la oclusión céntrica directa. (b) La paciente solicitó un tiempo de procedimiento corto, lo cual no supuso ningún problema con híbrido de vidrio. Caso del Dr. Khaled Adel.
pueden lograr fácilmente mediante la aplicación de rollos de algodón y de hilo de retracción. Por lo tanto, la aplicación del dique de goma no es necesaria.
7. Eliminación posoperatoria de un exceso gingival inevitable (figura 7)
Siempre que sea inevitable la extrusión de material más allá de la superficie gingival, es esencial eliminar el exceso de la restauración después del tratamiento. Los excesos gingivales de EQUIA Forte (HT), a diferencia de los de resina
compuesta, se pueden eliminar fácilmente con bisturí o fresas interproximales.
8. Geriátrico y pacientes con TMD (figura 8)
Frecuentemente, los pacientes de edad avanzada y aquellos que sufren de trastornos de la articulación temporomandibular encuentran dificultades para tolerar procedimientos odontológicos prolongados o periodos extensos de aislamiento con la boca abierta. En este contexto, un vidrio híbrido, que
Figura
78 Gaceta Dental · N o 366 | Mayo 2024 CIENCIA Y CLÍNICA. Informe
Figura

con
se caracteriza por ser un material de relleno sólido, autoadhesivo y de rápida polimerización, se presenta como una opción adecuada para estos pacientes. La aplicación de este material requiere solo un breve tiempo de aislamiento, el cual puede efectuarse con el uso de rollos de algodón, eliminando la necesidad de emplear diques de goma o abrazaderas. Además, este proceso no demanda una preparación minuciosa de la cavidad, lo que contribuye a minimizar el tiempo total del tratamiento.
9. Cavidades conservadoras en situaciones de acceso restringido (figura 9)
En este caso, la lesión proximal se preparó a través de un acceso restringido desde una cavidad compuesta en la superficie proximal de la pieza adyacente. La cavidad simple preparada no tiene accesibilidad directa para permitir una inspección exhaustiva de las paredes oclusales y axiales. No se puede anular la posibilidad de dejar atrás la dentina afectada por la caries. Por lo tanto, el uso de un material anticariogénico para restaurar dicha cavidad sería

a través de
una gran ventaja. La dificultad de acceso también podría limitar la posibilidad de garantizar el paso de la luz necesario para polimerizar correctamente una restauración de resina. La restauración con híbrido de vidrio ofrece una colocación sencilla sin agentes de adhesión, anticariogenicidad, autopolimerización y buena resistencia a la abrasión, lo que permite un contacto estable. ●
AGRADECIMIENTOS
El autor desea agradecer a los siguientes miembros del equipo de CORE por su contribución con casos a este artículo: Dres. Khaled Adel, Mona Galal y Amr El-Deeb, profesores de Odontología Operativa, Universidad Ain-Shams. BDS, MSc, PhD en Universidad Ain-Shams.
el
Figura 9. (a) Un segundo molar inferior
una lesión cariosa mesial a la que se accedió
una cavidad distal en
primer molar permanente. (b) Se preparó una cavidad simple de clase II y se restauró con EQUIA Forte HT (GC). Caso del Dr. Khaled Adel.
79 Gaceta Dental · N o 366 | Mayo 2024 Informe. CIENCIA Y CLÍNICA
BIBLIOGRAFÍA
1. ILIE N. (2018). Maturation of restorative glass ionomers with simplified application procedure. Journal of dentistry, 79, 46–52. https://doi.org/10.1016/j.jdent.2018.09.008
2. NGO, H. C., MOUNT, G., MC INTYRE, J., TUISUVA, J., & VON DOUSSA, R. J. (2006). Chemical exchange between glass-ionomer restorations and residual carious dentine in permanent molars: an in vivo study. Journal of dentistry, 34(8), 608–613. https://doi.org/10.1016/j.jdent.2005.12.012
3. ANA FLÁVIA BISSOTO CALVO, FABIANA BUCHOLDZ TEIXEIRA ALVES, TATHIANE LARISSA LENZI, TAMARA KERBER TEDESCO, ALESSANDRA REIS, ALESSANDRO DOURADO LOGUERCIO, DANIELA PRÓCIDA RAGGIO. Glass ionomer cements bond stability in caries-affected primary dentine. International Journal of Adhesion & Adhesives 48 (2014) 183–187
4. FRANCISCONI, L. F., SCAFFA, P. M., DE BARROS, V. R., COUTINHO, M., & FRANCISCONI, P. A. (2009). Glass ionomer cements and their role in the restoration of noncarious cervical lesions. Journal of applied oral science : revista FOB, 17(5), 364–369. https://doi.org/10.1590/s167877572009000500003
5. KIM, Y. G., & HIRANO, S. (1999). Setting shrinkage and hygroscopic expansion of resin-modified glass-ionomer in experimental cylindrical cavities. Dental materials journal, 18(1), 63–75. https://doi.org/10.4012/dmj.18.63
6. CHEETHAM, J. J., PALAMARA, J. E., TYAS, M. J., & BURROW, M. F. (2014). A comparison of resin-modified glass-ionomer and resin composite polymerisation shrinkage stress in a wet environment. Journal of the mechanical behavior of biomedical materials, 29, 33–41. https://doi.org/10.1016/j. jmbbm.2013.07.003
7. NAOUM, S. J., MUTZELBURG, P. R., SHUMACK, T. G., THODE, D., MARTIN, F. E., & ELLAKWA, A. E. (2015). Reducing composite restoration polymerization shrinkage stress through resin modified glass-ionomer based adhesives. Australian dental journal, 60(4), 490–496. https://doi.org/10.1111/adj.12265
8. PERERA, D., YU, S., ZENG, H., MEYERS, I. A., & WALSH, L. J. (2020). Acid Resistance of Glass Ionomer Cement Restorative Materials. Bioengineering (Basel, Switzerland), 7(4), 150. https:// doi.org/10.3390/bioengineering7040150
9. TIWARI, S., KENCHAPPA, M., BHAYYA, D., GUPTA, S., SAXENA, S., SATYARTH, S., SINGH, A., & GUPTA, M. (2016). Antibacterial Activity and Fluoride Release of GlassIonomer Cement, Compomer and Zirconia Reinforced Glass-Ionomer Cement. Journal of clinical and diagnostic research : JCDR, 10(4), ZC90–ZC93. https://doi.org/10.7860/ JCDR/2016/16282.7676
10. HAFSHEJANI, T. M., ZAMANIAN, A., VENUGOPAL, J. R., REZVANI, Z., SEFAT, F., SAEB, M. R., VAHABI, H., ZARRINTAJ, P., & MOZAFARI, M. (2017). Antibacterial glass-ionomer cement restorative materials: A critical review on the current status of extended release formulations. Journal of controlled
release : official journal of the Controlled Release Society, 262, 317–328. https://doi.org/10.1016/j.jconrel.2017.07.041
11. COSGUN, A., BOLGUL, B., & DURAN, N. (2019). In vitro investigation of antimicrobial effects, nanohardness, and cytotoxicity of different glass ionomer restorative materials in dentistry. Nigerian journal of clinical practice, 22(3), 422–431. https://doi.org/10.4103/njcp.njcp_429_18
12. HOSHIKA, S., DE MUNCK, J., SANO, H., SIDHU, S. K., & VAN MEERBEEK, B. (2015). Effect of Conditioning and Aging on the Bond Strength and Interfacial Morphology of Glass-ionomer Cement Bonded to Dentine. The journal of adhesive dentistry, 17(2), 141–146. https://doi.org/10.3290/j.jad.a33994
13. HOSHIKA, S., TING, S., AHMED, Z., CHEN, F., TOIDA, Y., SAKAGUCHI, N., VAN MEERBEEK, B., SANO, H., & SIDHU, S. K. (2021). Effect of conditioning and 1 year aging on the bond strength and interfacial morphology of glass-ionomer cement bonded to dentine. Dental materials : official publication of the Academy of Dental Materials, 37(1), 106–112. https://doi. org/10.1016/j.dental.2020.10.016
14. HATIRLI, H., YASA, B., & ÇELIK, E. U. (2021). Clinical performance of high-viscosity glass ionomer and resin composite on minimally invasive occlusal restorations performed without rubber-dam isolation: a two-year randomised split-mouth study. Clinical oral investigations, 25(9), 5493–5503. https://doi.org/10.1007/s00784-021-03857-0
15. JHAMAK NOURMOHAMMADI, REZA SALARIAN, MEHRAN SOLATI-HASHJIN, FATOLLAH MOZTARZADEH. Dissolution behavior and fluoride release from new glass composition used in glass ionomer cements. Ceramics International 33 (2007) 557–561
16. SCHLAFER, S., BORNMANN, T., PARIS, S., & GÖSTEMEYER, G. (2021). The impact of glass ionomer cement and composite resin on microscale pH in cariogenic biofilms and demineralization of dental tissues. Dental materials : official publication of the Academy of Dental Materials, 37(10), 1576–1583. https://doi.org/10.1016/j.dental.2021.08.007
17. FEATHERSTONE, J. D., GLENA, R., SHARIATI, M., & SHIELDS, C. P. (1990). Dependence of in vitro demineralization of apatite and remineralization of dental enamel on fluoride concentration. Journal of dental research, 69 Spec No, 620–636. https://doi.org/10.1177/00220345900690S121
18. GURGAN, S., KUTUK, Z. B., YALCIN CAKIR, F., & ERGIN, E. (2020). A randomized controlled 10 years follow up of a glass ionomer restorative material in class I and class II cavities. Journal of dentistry, 94, 103175. https://doi.org/10.1016/j.jdent.2019.07.013
19. MILETIĆ, I., BARABA, A., BASSO, M., PULCINI, M. G., MARKOVIĆ, D., PERIĆ, T., OZKAYA, C. A., & TURKUN, L. S. (2020). Clinical Performance of a Glass-Hybrid System Compared with a Resin Composite in the Posterior Region: Results of a 2-year Multicenter Study. The journal of adhesive dentistry, 22(3), 235–247. https://doi.org/10.3290/j.jad.a44547
80 Gaceta Dental · N o 366 | Mayo 2024 CIENCIA Y CLÍNICA. Informe
EQUIA Forte™ HT
Alternativa restaurativa a largo plazo y rentable
Diseño ingenioso del bote Boquilla precisa y tapa de flip-top ergonómica
Tecnología avanzada de vidrio híbrido Fuerte, duradero y biocompatible

Intercambio iónico protector que evita la desmineralización y estimula la remineralización


Recubrimiento autoadhesivo nano-relleno resistente al desgaste, que alisa la superficie y la protege durante el proceso de maduración.
GC EUROPE N.V. Comercial.Spain@gc.dental https://www.gc.dental/europe
Higiene dental Streptococcus dentisani. Actualización sobre nuevas investigaciones
Premio GD Mejor Talento en Higiene Dental 2023
La caries y las enfermedades periodontales son las alteraciones con mayor prevalencia a nivel de salud de la cavidad oral. El Streptococcus dentisani es una bacteria anaerobia que fue aislada por primera vez por A. Mira. Ésta se encuentra en las superficies dentales con placa subgingival y supragingival, entre otras, de individuos libres de caries.

Es una especie Gram-positiva conocida por su capacidad de producir bacteriocinas, inhibiendo así el crecimiento de bacterias cariogénicas como son el Streptococcus mutans , el Porphyromonas gingivalis y el Fusobacterium nucleatum, así como la capacidad de amortiguar el pH mediante la producción de amonio a partir de arginina. Esta bacteria, además, ha demostrado tener propiedades probióticas y se puede utilizar para la prevención de la caries dental y otras enfermedades
orales. Ensayos clínicos recientes han demostrado que la aplicación del S. dentisani en diversas formas, como son la aplicación tópica o en gel bioadhesivo, ha tenido resultados favorables en aquellos individuos voluntarios que han participado en estos estudios. Es por ello que éste ha sido sugerido como un probiótico oral debido a sus características beneficiosas.
Además, hoy en día, se están estudiando futuras aplicaciones del estreptococo mediante su incorporación en pastas dentífricas de uso diario, en chicles y en la leche (en el caso de países con bajos recursos económicos y gran prevalencia de caries en niños), así como el posible efecto sinérgico de la administración del S. dentisani y el uso de pastas dentífricas con arginina en individuos con caries.
Palabras clave: Streptococcus dentisani, caries, enfermedad periodontal, probiótico oral.
PAULA ALBALAT COMECHE
Superior en Higiene Bucodental. CIPFP Ausias March. 82 HIGIENE DENTAL Gaceta Dental · N o 366 | Mayo 2024
Técnico
«S. dentisani ha demostrado tener propiedades probióticas y se puede utilizar para la prevención de la caries dental y otras enfermedades orales»
INTRODUCCIÓN

A nivel mundial, la caries y las enfermedades periodontales son las alteraciones bucodentales con mayor prevalencia. En España, ambas alteraciones tienen gran prevalencia en cuanto a la salud oral. Según la encuesta de salud oral realizada por Bravo Pérez et al., en el caso de la caries, existe una prevalencia del 35,5% en menores de 5-6 años; el porcentaje de jóvenes a los 12 y 15 años es del 28,6% y 35,5%, respectivamente; y en adultos existe una prevalencia que se sitúa entre el 93,8% y casi el 100%. Cuando se trata de enfermedad periodontal, en las cohortes de 12 y 15 años, el porcentaje de individuos con cálculo o sarro es del 28% y 34%, mientras que en la cohorte de 35-44 años encontramos un porcentaje de sujetos con bolsas profundas (>=6 mm.) del 7.6% y un 11.6%, presenta bolsas periodontales de 4-5 mm. En los adultos mayores estos valores son de 17.9% y 22.9%, respectivamente. La prevalencia de sarro es del 41.4% y 39.4%, en los adultos jóvenes y mayores, respectivamente (1). En el caso de ambas enfermedades, su etiología es multifactorial y polimicrobiana, sin embargo, uno de los factores más significativos es la microbiota oral, un conjunto de microorganismos que forman parte del ecosistema bucal y contribuyen a su equilibrio para garantizar una función fisiológica adecuada y evitar la aparición de enfermedades. En la microbiota oral podemos encontrar bacterias como el Streptococcus mutans , Fusobacterium nucleatum , Porphyromonas gingivalis y el Streptococcus oralis subspecies dentisani , en el cual nos centraremos a lo largo del trabajo.
A partir de diversos estudios realizados por A. Mira et al., se ha Freepik/tonodiaz.
83 HIGIENE DENTAL Gaceta Dental · N o 366 | Mayo 2024
«El S. dentisani es capaz de inhibir el crecimiento de bacterias acidogénicas, como es el S. mutans, a través de la metabolización de la arginina en amonio»
aplicaciones del S.dentisani como probiótico oral.
METODOLOGÍA
demostrado que el S. dentisani tiene efectos beneficiosos en procesos orales, ya que se ha comprobado que éste inhibe el crecimiento de algunos patógenos orales como el S. mutans , P. gingivalis o F. nucleatum, principales agentes causantes de la caries y las enfermedades periodontales, y posee la capacidad para amortiguar el pH ácido de la cavidad bucal, «por lo que se ha propuesto como un probiótico prometedor contra la caries y las enfermedades periodontales» (2).
Por todo lo expuesto anteriormente, en el presente trabajo se pretende realizar una revisión bibliográfica acerca del S. dentisani , para conocer cuáles son los efectos beneficiosos de esta bacteria, así como las posibles aplicaciones que puede tener como probiótico oral.
OBJETIVOS
Objetivo general
Analizar cuál es el papel del S.dentisani en la prevención de caries y enfermedades periodontales.
Objetivos específicos
Revisar el mecanismo de actuación del S. dentisani contra los patógenos orales; y describir las diferentes
Se ha realizado una revisión bibliográfica de artículos relacionados con el tema a tratar en bases de datos como PubMed y otras fuentes como es la Revista del Ilustre Consejo General de Colegios de Odontólogos y Estomatólogos de España. Los descriptores que se han utilizado son «Streptococcus dentisani», «caries», «periodontal disease», «Porphyromonas gingivalis» y hemos hecho uso del operador booleano «AND». Para la búsqueda de los artículos se han utilizado, además, algunos filtros, como son el idioma de los artículos, que en este caso podían ser artículos tanto en inglés como en español, además de una fecha de publicación de los artículos no superior a 10 años.
Han sido encontrados diecinueve artículos de los cuales trece han sido utilizados para realizar el trabajo debido a su relevancia. Sin embargo, uno de ellos ha sido rechazado ya que no era relevante para el objetivo de la revisión.
Además, se le realizó una entrevista al propio investigador del S. dentisani , A. Mira, donde nos explicó el proceso de investigación desde que se aisló la bacteria hasta la actualidad.
RESULTADOS/DISCUSIÓN
La caries dental es una enfermedad crónica no trasmisible mediada por bacterias, modulada por la dieta, dinámica, es decir, es una patología multifactorial y polimicrobiana, que resulta en la pérdida de la red de minerales que forman los tejidos duros del diente. Se considera una de las enfermedades más frecuentes en
84 HIGIENE DENTAL Gaceta Dental · N o 366 | Mayo 2024
las personas en todo el mundo. Es una enfermedad crónica que progresa lentamente y todas las personas son susceptibles de sufrir la enfermedad a lo largo de su vida, pero es una enfermedad prevenible.
Los factores de esta enfermedad son cuatro: microorganismos, huésped, dieta y tiempo (Figura 1). Al ingerir en la dieta hidratos de carbono, se produce un desequilibrio del pH de la cavidad oral, disminuyéndose por debajo del pH crítico. En la cavidad bucal se encuentra el biofilm, donde uno de los microorganismos más usuales es el S. mutans (Figura 2), que también tiene gran prevalencia en el desarrollo de la caries dental, y que se caracteriza por ser una bacteria Gram-positiva; anaerobia facultativa, esférica, que pertenece al grupo de las acidolácticas; vive y se desarrolla en medio de pH bajo; metaboliza los azúcares a ácidos y los sintetiza. De esta manera, se inicia y se desarrolla la enfermedad de la caries dental.
Las enfermedades periodontales son alteraciones de origen infeccioso o inflamatorio que se caracterizan por la inflamación de la encía provocada por la colonización bacteriana de la superficie dental

adyacente a la misma. Estas alteraciones se pueden dividir en gingivitis (inflamación de la encía sin afectación del resto de tejidos de soporte del periodonto, de carácter reversible) y periodontitis (enfermedad inflamatoria de los tejidos periodontales, que son los que soportan el diente en la que se produce una destrucción progresiva del ligamento periodontal y del hueso alveolar con la formación de bolsa, recesión o ambas, y de carácter irreversible).
Las encías, a pesar de tener un estado saludable y normal, poseen un infiltrado de leucocitos que se compone, sobre todo, de neutrófilos o leucocitos polimorfonucleares. «Estos leucocitos son fagocitos, cuyo propósito principal es matar bacterias después de migrar a través y fuera de los tejidos en el área gingival crevicular o la bolsa gingival» (3). Al tomar una muestra subgingival de placa, se observan tanto microorganismos de la placa como neutrófilos. Estos neutrófilos son reclutados en la bolsa periodontal o en la grieta gingival, debido a la atracción de moléculas liberadas por las bacterias, los péptidos quimiotácticos. Además, como
 Figura 1. Etiología de la caries.
Figura 1. Etiología de la caries.
85 HIGIENE DENTAL Gaceta Dental · N o 366 | Mayo 2024
Figura 2. Cultivo placa Petri de S. mutans.
las bacterias dañan a las células epiteliales, éstas liberan moléculas, concretamente citoquinas, que provocan que la atracción de leucocitos y neutrófilos a la grieta sea mayor. Los neutrófilos, por un lado, dentro de la grieta son capaces de fagocitar y digerir bacterias; y, por lo tanto, eliminar las bacterias de la bolsa periodontal. Por otro lado, si los neutrófilos se sobrecargan con bacterias, se degradan o «explotan». Esto provoca daño tisular de enzimas tóxicas, que son liberadas por los neutrófilos.
Los patógenos periodontales y otras bacterias anaerobias producen una variedad de enzimas y toxinas que pueden dañar los tejidos e iniciar la inflamación, además de producir productos de desecho nocivos que provocan una irritación mayor de los tejidos. Las enzimas descomponen sustancias extracelulares y las membranas de las células huésped para producir nutrientes para su crecimiento. Los microorganismos pueden dañar los tejidos del huésped e inducir respuestas inflamatorias e inmunes, pero su objetivo principal es multiplicarse, crecer y sobrevivir dentro de la bolsa periodontal.
En el caso de la bacteria P. gingivalis (un colonizador secundario del surco gingival), tiene la capacidad de invadir las células epiteliales en un período aproximado de veinte minutos, replicándose dentro de ellas, lo que le da la capacidad de evadir la respuesta inmune del huésped. Debido a su capacidad proteolítica, la alteración de la respuesta innata y adaptativa del huésped y la respuesta inflamatoria en el surco facilitan que el proceso de destrucción del periodonto se torne crónico. Por otro lado, el F. nucleatum es una bacteria anaerobia que se
encuentra en la cavidad oral y que desempeña un papel importante en el desarrollo y la progresión de la enfermedad periodontal. Éste se adhiere a la superficie del diente y forma biopelículas junto a otras bacterias, lo que contribuye a la formación de placa dental. Además, se ha demostrado que es capaz de penetrar en el tejido alveolar y el hueso alveolar, lo que contribuye a la degradación del tejido periodontal y la pérdida ósea. La bacteria puede estimular la producción de citocinas proinflamatorias y metaloproteinasas de matriz (MMPs) por parte de las células del huésped, lo que causa la degradación del tejido conectivo y óseo en la encía. Por tanto, el F. nucleatum actúa en la enfermedad periodontal por medio de su adhesión y formación de biopelículas, su capacidad para penetrar en el tejido periodontal, su capacidad para modular la respuesta inmune del huésped y su capacidad para inducir la producción de citocinas proinflamatorias y MMPs.
Descubrimiento del S. dentisani
El S. dentisani fue descubierto por casualidad por A. Mira a partir de una conversación con una amiga. Ella contó que formaba parte del 10% de personas que nunca habían tenido caries, y lo que más curioso le resultó a A. Mira fue que la pareja de su amiga había dejado de tener caries desde que estaba con ella. Pensó que tal vez ella podría transmitir a su pareja alguna bacteria protectora a través de la saliva. Hicieron cultivos y estudios de ADN, durante seis meses, analizando todas las bacterias que tenían en la boca las personas que nunca habían presentado caries, y comprobaron que tenían una frecuencia muy alta de una nueva
86 HIGIENE DENTAL Gaceta Dental · N o 366 | Mayo 2024

Masterclass Cirugía Ortognática
Federico Hernández-Alfaro, Manuel Román y Juan Carlos Pérez-Varela

Con la Masterclass de Cirugía Ortognática & Ortodoncia Invisible podremos saber qué casos podemos compensar con ortodoncia y cuáles debemos operar, entre otros muchos aspectos a tener en cuenta.

manue2Lroman acaoemv
manUC2L10man.com
«Los resultados de los ensayos clínicos realizados han demostrado que el S. dentisani puede ser aplicado como probiótico oral»
especie de bacteria, que no se conocía hasta el momento, y que a ctuaba como un escudo frente a la caries. Además, han sido aisladas unas ocho cepas del S. dentisani , de las cuales dos de estas han demostrado tener capacidad para inhibir a otras bacterias. Estas dos cepas son la 7746 y la 7747T (4), de las cuales la primera ha evidenciado poseer capacidad antimicrobiana frente al S. mutans .
En un estudio sobre el «aislamiento y tipificación bacteriocínica del S. dentisani » realizado por Georg Conrads et al., el S. dentisani fue aislado de la saliva de los individuos voluntarios en tres pasos: (1) selección de bacterias α- hemolíticas grampositivas con una colonia y una morfología celular con las cepas de referencia 7746 y 7747T; (2) aplicación de ionización por desorción láser asistida por matriz (MALDITOF MS) para seleccionar las cepas de «S. oralis» con un perfil similar de proteínas ribosómicas; (3) cribado funcional del gen de la carbamato quinasa (arcC) y de un gen del ARNr 16S específico de la especie S. dentisani (5), donde los S. oralis aislados fueron analizados más a fondo mediante una PCR cuantitativa en tiempo real, cuyos resultados
fueron positivos para ambos genes debido a que se clasificaron como cepas de dicha bacteria. El S. dentisani es una bacteria anaerobia que pertenece al grupo Mitis (6), y que fue aislada por primera vez en 2011 por A. Mira de individuos libres de caries donde un análisis metagenómico de las muestras de placa dental de estos habían mostrado una sobrerrepresentación de genes de codificación de péptidos antimicrobianos. Sus células son cocos no esporulantes, no móviles, grampositivos y catalasa negativa en crecimiento en colonias de aproximadamente 1,5 mm de diámetro, y crecen en cadenas cortas (7). Ha sido identificado como un probiótico de la cavidad oral debido a sus características beneficiosas (8). El genoma de esta bacteria codifica una larga lista de péptidos antimicrobianos (bacteriocinas), en concreto 14 péptidos, que tienen efecto inhibidor contra varios patógenos orales, incluyendo S. mutans, P. gingivalis o F. nucleatum. Además, posee la vía arginolítica completa y es capaz de amortiguar pH extracelular de 5,5 a neutro en presencia de arginina.
Éste se ha encontrado en niveles altos en la placa supra y subgingival, y en niveles más bajos en la saliva y el dorso de la lengua (9).
Inicialmente, el equipo de A. Mira propuso el nombre de Streptococcus «anticariensis», pero éste fue rechazado por el comité internacional que debía aprobarlo, porque, por lo visto, anticariensis en latín significa «nacido en Antequera, Málaga (de la antigua ciudad romana de Anticaria)». Finalmente, se le asignó el nombre de Streptococcus dentisani , que en latín significa «diente sano».

88 HIGIENE DENTAL Gaceta Dental · N o 366 | Mayo 2024
Actividad anticariogénica del S. dentisani
El S. dentisani fue introducido por López-López como un probiótico oral con triple acción anticaries, ya que coloniza los dientes, amortigua la arginina en presencia de pH ácido a través de una vía arginolítica e inhibe el crecimiento de los principales patógenos orales mediante la producción de potentes bacteriocinas (10).
El S. dentisani tiene la capacidad de metabolizar arginina en amoníaco, que neutraliza el pH de la placa dental. Por lo tanto, S. dentisani tiene un doble mecanismo anticariogénico: por un lado inhibe el crecimiento de bacterias acidogénicas, estimulando la formación de amonio, lo que daría lugar a un pH más favorable para la salud dental; y, por otro lado,
podría actuar como biomarcador de bacterias orales beneficiosas (11).
El modo de acción del S. dentisani consiste en colonizar la boca con bacterias beneficiosas que compiten con el S. mutans por los nutrientes disponibles en la boca. Al colonizar el microbioma oral, el S. dentisani regula el pH de la cavidad oral neutralizando los ácidos que se generan por la fermentación de los azúcares que se ingieren, lo que inhibe el crecimiento del S. mutans. Además, el S. dentisani también produce sustancias antimicrobianas como bacteriocinas que eliminan a las bacterias dañinas (Figura 3).
Por lo tanto, el S. dentisani actúa como una barrera protectora contra la caries dental al competir con las bacterias dañinas por los nutrientes disponibles en la boca y producir

HIGIENE DENTAL
sustancias antimicrobianas que eliminan las bacterias cariogénicas.
Efectos del S. dentisani como probiótico para las enfermedades periodontales
El S. dentisani tiene una triple acción probiótica contra los patógenos periodontales. Por un lado, tiene acción antimicrobiana, inhibiendo el crecimiento; antiadhesiva, compitiendo, desplazando e inhibiendo la adherencia a los fibroblastos gingivales; por otro lado, tiene acción antiinflamatoria, favoreciendo la respuesta inmunitaria antiinflamatoria (11).
El crecimiento de las bacterias P. gingivalis y F. nucleatum se reduce entre el 35-38% con la presencia del S. dentisani.
En un estudio in vitro realizado por Adelaida Esteban-Fernández et al. mostraron que este estreptococo ejerce una fuerte acción inhibitoria frente a la colonización por P. gingivalis y F. nucleatum en fibroblastos humanos, alcanzando una inhibición casi completa de la adherencia a las células gingivales. Además, es capaz de desplazar a los patógenos previamente adheridos
previamente, así como impedir la adhesión de estas bacterias.
Asimismo, el S.dentisani, «regula la respuesta inflamatoria presentando un perfil antiinflamatorio cuando se expone solo a fibroblastos gingivales humanos y disminuye la producción de citoquinas proinflamatorias desencadenadas por la exposición a P. gingivalis o F. nucleatum» (12).
Aplicaciones del S. dentisani: ensayos clínicos
Desde el descubrimiento de este estreptococo, se han realizado diferentes ensayos clínicos con la aplicación del S. dentisani en diversas maneras.
En uno de los estudios realizados por A. Mira et al. se realizó un ensayo clínico a 184 individuos voluntarios que consistió en la aplicación tópica del S. dentisani durante 45 días. En total se realizaron 14 aplicaciones, durante las cuales en los días 15, 30 y 45 se realizaban muestreos. Los resultados del ensayo fueron favorables, ya que éste parece mejorar varias características clínicas asociadas con la salud bucodental, como es el caso de la

90 HIGIENE DENTAL Gaceta Dental · N o 366 | Mayo 2024
Figura 3. Inhibición del S. mutans por parte del S. dentisani.


Expertos en la prevención de caries
POR DENTISTAS E HIGIENISTAS PARA LAS CARIES* RECOMENDADA MARCA n°1




Acción inmediata
Remineraliza y fortalece el esmalte dental ayudando a prevenir las caries.






Acción prolongada
Protección a largo plazo formando un escudo que protege el esmalte de los ataques ácidos, incluso después del cepillado.
Fluoruro sódico Monofluorofosfato sódico Monofluo Na F F O O O Na Na P Tecnología Bi-fluoré Fórmulas únicas · Doble Acción
*Estudio IQVIA de seguimiento de dentistas e higienistas en España (Noviembre, 2022). Ver instrucciones de uso en el envase.
«Los patógenos periodontales y otras bacterias anaerobias producen una variedad de enzimas y toxinas que pueden dañar los tejidos e iniciar la inflamación»
sugiere que es necesario que haya una presencia mínima de este organismo para llegar a observar una mejora en las características clínicas y microbiológicas de la cavidad oral. Además, dado que el S. dentisani hace uso de la arginina, esto sugiere comprobar si el uso de pastas dentífricas que contienen arginina y la administración del S. dentisani como probiótico pueden tener un efecto sinérgico en individuos con la enfermedad de caries.
acumulación de placa, la calidad de la saliva y el flujo salival, así como una mejora de la disbiosis bacteriana asociada a la enfermedad. «Algunas de estas mejoras pueden atribuirse a la actividad antimicrobiana de las bacteriocinas del S. dentisani y a su capacidad pH buffering a través de la vía arginolítica» (11).
En otro estudio realizado a 75 voluntarios, que consistía en la aplicación de un gel bioadhesivo que contiene dicho estreptococo en férulas o cubetas individuales, se demostró que la administración de éste durante una semana «provocó un aumento del pH salival, una reducción de la producción de ácido láctico hasta 30 días después de su aplicación, una reducción de la colonización de S. mutans y un aumento de la presencia de S. dentisani hasta 14 días después de su aplicación» (13).
Al realizar un segundo ensayo y aplicar el probiótico durante un mes, pudieron observarse tanto mejoras en los índices de placa y gingival como en los niveles de amoniaco salival y patógeno. Esto
En otro de los ensayos, en este caso realizados por Maria D. Ferrer et al., se administraba la cepa 7746 del estreptococo integrada en un gel o un barniz que fue aplicado directamente en las superficies de los dientes, durante cuatro semanas a 11 individuos libres de caries y sanos voluntarios (6 mujeres y 5 hombres) de entre 25-35 años durante un mes. Éstos tenían que cepillar sus dientes 2 veces al día. El día 0 se realizó una limpieza con ultrasonidos de los cuadrantes 1 y 4 para, posteriormente, aplicar el barniz en estos, mientras que los cuadrantes 2 y 3 se mantenían intactos. Los individuos los días establecidos debían realizar seis aplicaciones sucesivas en casa cada 24 horas. Además, se pidió a los participantes que se abstuvieran de cepillarse los dientes la mañana de los días de muestreo (día 0, día 14 y día 28), en los que se realizaba el mismo procedimiento.
Los resultados de este ensayo también fueron exitosos para la colonización bacteriana. No obstante, lo adecuado para esta administración sería la aplicación por parte de los profesionales debido a sus concentraciones (13).
92 HIGIENE DENTAL Gaceta Dental · N o 366 | Mayo 2024

PARA CADA SITUACIÓN, UNA SOLUCIÓN POLA
POLA DAY
RADII XPERT
Desde 30 min con férula
Disponible al 6% de peróxido de hidrógeno
• Disponible en kit de 4, 10 o 50 jeringas

RADII XPERT
RADII XPERT
¡LA ÚNICA QUE SE
CONVIERTE EN LÁMPARA DE BLANQUEAMIENTO!

¡LA ÚNICA QUE SE CONVIERTE EN LÁMPARA DE BLANQUEAMIENTO!
¡LA ÚNICA QUE SE CONVIERTE EN LÁMPARA DE BLANQUEAMIENTO!
POLA NIGHT
Desde 90 minutos al día
Disponible en peróxido de carbamida al 10% y 16%
Disponible en kit de 4, 10 o 50 jeringas

La tecnología única de asistencia a la focalización de Radii Xpert permite obtener el correcto posicionamiento de la luz, así como el ángulo adecuado antes del fotocurado.
POLA FOR ALIGNERS
Máxima comodidad para el paciente en un kit de blanqueamiento
Contiene nitrato de potasio y flúor para reducir la sensibilidad durante su uso a largo plazo


SOOTHE
Alivio instantáneo – úselo antes o después del proceso de blanqueamiento
Nitrato de potasio al 6% y flúor al 0.1%,
Con férula
La tecnología única de asistencia a la focalización de Radii Xpert permite obtener el correcto posicionamiento de la luz, así como el ángulo adecuado antes del fotocurado.
La tecnología única de asistencia a la focalización de Radii Xpert permite obtener el correcto posicionamiento de la luz, así como el ángulo adecuado antes del fotocurado.




POLA LIGHT
• El sistema Pola Light se combina con el gel Pola Day
• Formulado para eliminar con seguridad las manchas más duraderas
• Remineralización para fortalecer los dientes.
• Hidratación adicional para minimizar la sensibilidad








PINCEL APLICADOR INCLUIDO!
MULTIDIRECCIONAL















TRÍPODE MULTIDIRECCIONAL
Diseño inteligente Estable
•Manejo fácil y cómodo


facebook.com/sdipola/españa instagram/sdi_espana
facebook.com/sdipola/españa instagram/sdi_espana
SDI ESPAÑA
SDI ESPAÑA
COMPOSITES | IONOMEROS DE VIDRIOS | BLANQUEAMIENTO DENTAL | FDP RIVA STAR | CEMENTOS/ADHESIVOS | ETCHING | APARATOLOGÍA llamada gratis 00800 022 55 734 www.sdi.com.au www.polawhite.com.au
PARA CADA SITUACIÓN, UNA SOLUCIÓN POLA
SITUACIÓN, POLA
TRÍPODE
inteligente cómodo
facebook.com/sdipola/españa instagram/sdi_espana
«El S. mutans produce sustancias antimicrobianas que eliminan las bacterias dañinas»
Futuras implicaciones del S. dentisani
Hoy en día, la patente del S. dentisani pertenece a la empresa multinacional japonesa Kaneka.
En cuanto a las futuras implicaciones del estreptococo, en España se prevé el lanzamiento de un dentífrico dental en los próximos años que contenga al S. dentisani de forma liposomada, para garantizar la viabilidad de éste en la pasta dental. En EE. UU., se contempla la posibilidad de integrar la bacteria del S. dentisani en chicles. Y en países de América Latina, como es el caso de Chile, se ha considerado la probabilidad de incorporar dicha bacteria en la leche y repartirla en la entrada de los colegios debido a la gran prevalencia de caries en niños por falta de recursos económicos. Actualmente se encuentran en fase de ensayo clínico en colaboración con la Universidad de Valencia en la que se está estudiando la aplicación de prebióticos orales. Se trata de un complemento alimenticio a base de verduras ricas en nitratos que son transformadas por las bacterias orales en óxido nitroso. Se ha observado que el óxido nitroso tiene efectos beneficiosos en la tensión arterial, debido a que es un vasodilatador. Asimismo, se están estudiando otras bacterias que puedan estar
presentes en algunos tipos de cáncer, como es el cáncer de colon. Se ha demostrado que las bacterias P. gingivalis y F. nucleatum son capaces de promover la progresión tumoral en ratones. Asimismo, la infección por P. gingivalis ha sido asociada con cáncer orodigestivo, aumento de la invasión de cáncer oral y proliferación de células madre de cáncer oral. Debido a que el S. dentisani inhibe el crecimientos de ambas bacterias, esto sugiere que pueda tener también efectos beneficiosos en aquellos tipos de cáncer que estén relacionados con la microbiota oral.
CONCLUSIONES
Los estudios realizados demuestran que el S. dentisani es capaz de inhibir el crecimiento de bacterias acidogénicas, como es el S. mutans , a través de la metabolización de la arginina en amonio, neutralizando así el pH de la cavidad oral. Además, se ha demostrado que este estreptococo produce sustancias antimicrobianas que eliminan las bacterias dañinas; por ello, el S. dentisani actúa como barrera protectora frente a la caries.
Asimismo, S. dentisani es capaz de inhibir la colonización por P. gingivalis y F. nucleatum , desplazar e inhibir la adherencia a los fibroblastos gingivales y favorecer la respuesta inmunitaria antiinflamatoria. Como consecuencia, el S. dentisani tiene efectos beneficiosos inhibiendo el desarrollo de las enfermedades periodontales.
Los resultados de los ensayos clínicos realizados han demostrado que el S. dentisani puede ser aplicado como probiótico oral. En dichos ensayos ha sido aplicado de forma tópica, en forma de gel bioadhesivo o como un gel o barniz
94 HIGIENE DENTAL Gaceta Dental · N o 366 | Mayo 2024
aplicado directamente sobre las superficies dentales. Todos han tenido resultados exitosos frente a la colonización bacteriana, mejorando las características clínicas y microbiológicas de la cavidad oral. Además, a partir del ensayo de la aplicación del estreptococo como gel bioadhesivo se ha sugerido comprobar si el uso de
dentífricos que contienen arginina y la administración de éste como probiótico pueden tener un efecto sinérgico en individuos con caries. Gracias a los exitosos resultados de los ensayos, se ha sugerido aplicar el S. dentisani en diferentes formas. En el caso de España como pasta dentífrica, en EE. UU en formato de chicles y en países como Chile incorporado en la leche. ●
BIBLIOGRAFÍA
1. BRAVO M, ET AL. (2020) ”Encuesta de Salud Oral en España 2020”. RCOE: Revista del Ilustre Consejo General de Colegios de Odontólogos y Estomatólogos de España, ISSN 1138123X, Vol.25, N o.4 págs. 12-69.
2. LÓPEZ SANTACRUZ H. D, LÓPEZ LÓPEZ A, REVILLA GUARINOS A, CAMELO CASTILLO A, ESPARZA VILLALPANDO V, MIRA A, ARANDA ROMO S. (2021). Streptococcus dentisani is a common inhabitant of the oral microbiota worldwide and is found at higher levels in cariesfree individuals. International Microbiology.
3. KINANE DF. (2001). Causation and pathogenesis of periodontal disease. Periodontology 2000, 25 (1), 8-20. https://doi.org/10.1034/j.1600-0757.2001.22250102.x
4. LÓPEZ LÓPEZ A, CAMELO CASTILLO A, FERRER MD, SIMON SORO A, MIRA A. (2017). “Health-associated niche inhabitants as oral probiotics: The case of Streptococcus dentisani. Frontiers in Microbiology, 8 (MAR).
5. CONRADS G, WESTENBERGER J, LÜRKENS M, ABDELBARY MMH. (2019). Isolation and Bacteriocin-Related Typing of Streptococcus dentisani. Frontiers in Cellular and Infection Microbiology, 9.
6. LLENA C, ALMARCHE A, MIRA A, LÓPEZ MA. (2019a). Antimicrobial efficacy of the supernatant of Streptococcus dentisani against microorganisms implicated in root canal infections. Journal of Oral Science, 61 (1), 184-194.
7. CAMELO CASTILLO A, BENÍTEZ PÁEZ A, BELDA FERRE P, CABRERA RUBIO R, MIRA A. (2014). Streptococcus dentisani sp. nov., a novel member of the mitis group. International Journal of Systematic and Evolutionary Microbiology, 64 (Pt_1), 60-65.
8. ANGARITA DÍAZ MP, ET AL. (Jun. 2019), “Presence of Streptococcus dentisani in the dental plaque of children from different Colombian cities”. Clinical and Experimental Dental Research, vol. 5, 3, págs. 184–190, doi: 10.1002/ cre2.158.
9. MARUYAMA H, MASAGO A, NAMBU T, MASHIMO C, TAKAHASHI K, OKINAGA T. (2020). Inter-site and interpersonal diversity of salivary and tongue microbiomes, and the effect of oral care tablets. F1000Research, 9, 1477.
10. ZHANG D, TAKESHITA T, FURUTA M, KAGEYAMA S, ASAKAWA M, NAMBU K, YAMASHITA Y. (2021). Tongue Microbiota Composition and Dental Caries Experience in Primary School Children. MSphere, 6 (2).
11. FERRER MTE, PÉREZ S, LÓPEZ AL, SANZ JL, MELO MJ, LLENA C, MIRA A. (2021). Evaluation of Clinical, Biochemical and Microbiological Markers Related to Dental Caries. International Journal of Environmental Research and Public Health, 18 (11), 6049.
12. ESTEBAN FERNÁNDEZ A, FERRER MTE, ZORRAQUÍN PEÑA I, LÓPEZ LÓPEZ A, MORENO ARRIBAS MV, MIRA A. (2019). In vitro beneficial effects of Streptococcus dentisani as potential oral probiotic for periodontal diseases. Journal of Periodontology, 90 (11), 1346-1355.
13. FERRER MTE, LÓPEZ LÓPEZ A, NICOLESCU T, PÉREZ VILAPLANA S, BOIX AMORÓS A, DZIDIC M, GARCÍA S, ARTACHO A, LLENA C, MIRA A. (2020). Topic Application of the Probiotic Streptococcus dentisani Improves Clinical and Microbiological Parameters Associated With Oral Health. Frontiers in Cellular and Infection Microbiology, 10.
95 HIGIENE DENTAL Gaceta Dental · N o 366 | Mayo 2024


DRES. FRANCISCO SÁNCHEZ Y RICARDO LÓPEZ
Presidente y secretario, respectivamente, de la Sociedad de Odontología Digital Andaluza (SODA)
Compartir y difundir las ventajas de la Odontología digital entre todos los profesionales del sector. Con este objetivo, entre otros, se ha constituido recientemente la SODA, una entidad, en palabras de su presidente y secretario, los Dres. Francisco Sánchez y Ricardo López, «que quiere situar a Andalucía en el primer puesto en el desarrollo de la Odontología en Europa».
96
Protagonistas Gaceta Dental · N o 366 | Mayo 2024
Aunque fue en diciembre de 2019 cuando empezó a gestarse la creación de la Sociedad de Odontología Digital Andaluza (SODA), no fue hasta 2023 cuando, después de cuatro años (pandemia de por medio), se constituyó. ¿Cómo y por qué surgió la iniciativa de crear esta organización? ¿Qué les motivó a hacerlo?
—Dr. Francisco Sánchez: La SODA surgió como una iniciativa de un grupo de compañeros comprometidos con la Odontología digital con el objetivo de compartir y difundir las ventajas de esta disciplina entre todos los profesionales, tanto dentistas como protésicos y resto de profesionales dentales.
—Dr. Ricardo López: Siendo nuestra «madre» la SOCE (Sociedad Española de Odontología Digital y Nuevas Tecnologías), que la fundamos en 2004, queremos -colaborando con ellaque la SODA potencie con mayor intensidad el desarrollo de la digitalización dental en Andalucía, porque aquí se encuentra un numeroso conjunto de profesionales muy avanzados en la digitalización, y formar un un equipo que trabaje persiguiendo nuestros fines para llegar al más alto nivel, liderando en Europa la Odontología más avanzada con los instrumentos digitales.
En este sentido, su origen se remonta a diciembre de 2019, cuando nos reunimos en Sevilla, en la cochera de un compañero, intentando construir prototipos de sistemas de CAD/CAM y otros dispositivos propios «made in Andalucía». Ahí comprendimos la necesidad de sumar a otros colegas, ya que sentíamos que estábamos dispersos y desconectados entre nosotros y que debíamos unir fuerzas para mejorar nuestro entorno cercano, el andaluz, que es tan rico en expertos en Odontología digital, para poder compartir experiencias, investigación, proyectos ambiciosos de creación de aparatos y programas, ciclos de estudios y formación, centros de innovación, industrias y comercios expertos, además de numerosos objetivos que pueden incrementarse para que Andalucía lidere el mayor progreso hacia los niveles más altos de Europa, beneficiando a
«Muchos profesionales se enfrentan a los programas digitales sin la información adecuada y sin una formación estandarizada»
todos los profesionales del sector, a la economía regional y, principalmente, a todos nuestros pacientes, porque la Odontología digital conlleva una atención de enorme beneficio para la salud de todos ellos.
—Con ese objetivo de alcanzar el mayor nivel de conocimientos para la aplicación exitosa de las nuevas herramientas digitales, ¿cuáles son las iniciativas que están llevando a cabo para promover la formación y educación en Odontología digital entre los profesionales de Andalucía?
—FS: Es fácil promover la formación porque las bondades de la Odontología digital son evidentes: simplificación de protocolos, reducción del tiempo de tratamiento y mayor precisión en los resultados. Esto se traduce en una mayor predictibilidad y calidad en nuestros tratamientos, así como en una menor invasión en nuestras intervenciones que todos desean, cuanto antes, aplicar.
Sin embargo, somos conscientes de que existe una brecha entre los profesionales digitales y los tradicionales. Muchos colegas se enfrentan a los programas digitales sin la información adecuada y sin una formación estandarizada. Esto causa frustración y, en ocasiones, lleva a abandonar estas herramientas. Así que, desde la SODA queremos reducir esta brecha y facilitar el acceso a la Odontología digital. Para ello, ofrecemos formación clara y progresiva, desde lo más básico hasta lo más avanzado, a precios reducidos mediante el uso de softwares de código abierto.
—RL: Hoy en día, además de los caminos clásicos en la enseñanza y formación más
97 Gaceta Dental · N o 366 | Mayo 2024
Dres. Francisco Sánchez y Ricardo López. PROTAGONISTAS
DESAFÍOS DEL FUTURO
Para el Dr. Francisco Sánchez, «la falta de relación entre profesionales es uno de los principales desafíos de la Odontología digital en Andalucía y, por tanto, uno de los principales aspectos de mejora».
También están, en palabras del Dr. Ricardo López, «la información independiente, útil para las decisiones a tomar en la elección de procedimientos; los sistemas, dispositivos y programas; la ayuda en la formación para el uso eficiente de todos los instrumentos digitales; la actualización permanente para sobrellevar los cambios continuos de mejora; el aporte de opciones de digitalización sin sufrir riesgos económicos con inversiones excesivas que, en poco tiempo, quedan obsoletas; y ser digitales sin caer en la cascada de compras continuas y peligrosas, al conseguir adaptar los sistemas veteranos a los procedimientos más actuales».
«La SODA busca eliminar las barreras de la curva de aprendizaje y los costes económicos para que más compañeros puedan acceder a la Odontología digital»
aprender los unos de los otros por las vías mas rápidas, económicas y abiertas, dentro del esquema que tratamos en conferencias y comunicaciones: «Mejores medios documentales para un profesional actualizado». Enseñar qué fuentes son más rentables o eficaces respecto a su coste en tiempo y dinero, para mantenerse en la «cresta de la ola» de la profesión. Aquí la comunicación es clave. Necesitamos interconectarnos permanentemente con los colegas más destacados y que fluya la relación sin limitaciones, con total transparencia y en colaboración, ayudándonos mutuamente en nuestros progresos, sin egoísmos particulares, ya que siempre será mas productivo y nos enriquecerá a todos. En esto, la SODA apostará por la creación de medios digitales y físicos que aumenten la compartición de la ciencia y práctica, dirigidos a la creación y la innovación digital dental.
—Y, siguiendo esta línea, ¿cómo está evolucionando la adopción de tecnologías digitales en las prácticas odontológicas de la región?
—FS: Muy ampliamente. Y ahí está nuestra misión principal, que es crear una comunidad en la que los profesionales expertos compartan sus conocimientos con los que se inician en esta disciplina. Queremos acercar los extremos y beneficiarnos mutuamente, y especialmente a nuestros pacientes, que son la meta donde se plasma nuestra avanzada práctica. La Odontología digital es universalmente aplicable y puede llevarse a cualquier lugar, ofreciendo la misma calidad en zonas rurales y en grandes ciudades.
académica, hay que difundir con fuerza la exitosa fórmula de esta nueva era, muy destacada desde que comenzó el nuevo siglo, que es enseñar a autoformare; es decir,
—RL: Por ahora, el cambio a la Odontología digital ha llegado a generalizarse. La digitalización en toda Andalucía es sorprendente, muy extensa, pero queremos superar todos los límites y alcanzar el primer puesto europeo en la eficiencia de su aplicación, los mejores protocolos de trabajo, y conseguir diferentes métodos de integración de la imprescindible Odontología clásica junto a la Odontología digital, porque las ventajas que tiene combinar ambas formas superan
98 Gaceta Dental · N o 366 | Mayo 2024 PROTAGONISTAS. Dres.
Francisco Sánchez y Ricardo López
al cacareado «full digital». Por ejemplo, tener modelos dentales de escayola en minutos, con un material ideal, controlable y preciso de trabajo, con una «resolución infinita», mientras que tardamos más tiempo en obtener modelos dentales de resina, sometidos a los errores incontrolables del escaneo y la polimerización y en un material no tan práctico a la manipulación, con resoluciones menores al obtener solo puntos, aunque sean muy cercanos. Esto es lo que queremos potenciar: la utilización de la Odontología digital lógica, conociendo las bases verdaderas eficaces de los procesos. O evitar las falsas creencias de producir en clínica determinados aparatos o dispositivos como más rentables cuando realmente no lo son y merecen seguir siendo trabajos del laboratorio protésico.
—¿De qué manera pueden participar los profesionales en las actividades que propone la Sociedad?
—FS: El potencial de la Odontología digital es ilimitado. Compartiendo cada uno sus conocimientos con el resto de compañeros dentro de la Sociedad, avanzaremos todos a mayor velocidad, permitiéndonos ser más creativos y dándonos soluciones a los retos diarios. El que uno entre a formar parte de este proyecto nos hará servir a los demás y recibir conjuntamente más capacidades de trabajo, nos brindará un mayor control en los tratamientos y nos ayudará a mejorar como
profesionales, a la vez que seremos ilimitados como grupo.
—RL: La principal ayuda para que la SODA alcance para Andalucía el primer puesto en el desarrollo en Europa de la Odontología digital avanzada está en hacerse socio, miembro activo de la Sociedad. Con una cuota bajísima de 50 euros al año, necesitamos hacer que todos los compañeros andaluces se inscriban, pues nuestra fuerza estará en compartir conocimientos, experiencias y proyectos que, solo entre todos, podemos lograr enriquecer. Así que, todos los dentistas (unos 7.000 andaluces), protésicos dentales, higienistas, auxiliares dentales, ortodoncistas, cirujanos maxilofaciales, médicos orales, radiólogos dentales, informáticos e ingenieros dentales, fabricantes y comerciales dentales, tienen que contribuir a lograr que nuestras actividades consigan ese enorme beneficio de la digitalización para toda la región: una salud privilegiada para todos nuestros pacientes.
—¿Cuáles han sido los últimos avances en Odontología digital que se están utilizando en la comunidad andaluza?
—FS: La decisión de establecer la Sociedad a nivel andaluz permite acentuar la implantación de la digitalización de forma particular e intensiva. Aunque todas las aplicaciones digitales más actuales se están aplicando en la región, que cuenta con una extensa

99
PROTAGONISTAS
Dres. Francisco Sánchez y Ricardo López.

«Queremos formar a nuevos profesionales para que se conviertan en expertos
comunidad con profesionales de calidad, podemos controlar con mayor proximidad y de forma más cercana esa excelencia digital con los mejores métodos de actuación. Esto es, por ejemplo, acentuar el uso de los escáneres volumétricos de campo amplio (CBCT maxilofacial), pues así podemos impulsar el prestigio de la atención dental en Andalucía y competir con otras regiones, mostrando todo lo que podemos lograr con las herramientas digitales, llegando a incorporar lo más avanzado de la ciencia actual.
—RL: En Andalucía no solo se utilizan hoy los últimos avances, sino que, además, estos se están creando, especialmente en protocolos actualizados e integración original de sistemas existentes. Estos incluyen: software; nuevos materiales plásticos de fresado e impresión; impresoras y fresadoras adaptadas; el sinterizado metálico; la integración de la radiología 3D de campo amplio como necesidad básica en toda rehabilitación; la búsqueda de aplicaciones de IA o automatismos
informáticos; macros, scripts o addons que elevan las posibilidades generando contenidos y diseños; armonizados geométricamente con la biometría, cefalometría (craneometría del aparato estomatognático), odontometría (medidas del odontón del sistema dentario) y dentometría (medidas del diente), que permiten rehabilitaciones instantáneas desde la lectura de imagenología 3D, y un largo etcétera.
—Por otro lado, desde la SODA destacan «el problema existente de la falta de comunicación intensa y fluida entre los compañeros profesionales dentales, sobre la digitalización dental y su necesidad». ¿Cómo fomentan, en este sentido, la colaboración entre los distintos profesionales del sector?
—FS: Para hacer realidad todas estas ideas, moveremos todo tipo de comunicaciones digitales, a través de las redes sociales y otras vías de conexión. Aunque ahora los inicios son reducidos, pretendemos convertirnos en insuperables en cantidad y calidad de contenidos. Por ello, hemos empezado creando una página web, donde ofrecemos formación online en Odontología digital de código abierto, con un orden claro y progresivo. Además, planeamos realizar encuentros y charlas para compartir conocimientos y experiencias. Esperamos que estas actividades se conviertan en congresos y eventos de mayor envergadura en el futuro.
Presentación pública de la SODA en el Colegio de Dentistas de Sevilla, el día 6 de marzo del 2024. Imagen: cedida por el Dr. Ricardo López.
digitales» 100 Gaceta Dental · N o 366 | Mayo 2024 PROTAGONISTAS. Dres. Francisco Sánchez y Ricardo López
—RL: Nos ha servido mucho la difusión de los medios de comunicación en red que se impusieron por la pasada pandemia. Hoy en día podemos conseguir con las aplicaciones de mensajería, las videollamadas y videoconferencias una interrelación que se soñaba en los años prepandémicos, pero que no se generalizaba y no llegaba a practicarse. Todas las reuniones físicas y las digitales se organizarán para evitar ese problema de la incomunicación, que va a desaparecer como uno de los objetivos principales de la SODA, incentivando la interconexión.
—A su juicio, ¿cómo creen que ha mejorado la atención al paciente con la implementación de las tecnologías?
—FS/RL: La SODA busca eliminar las barreras de la curva de aprendizaje y los costes económicos para que más compañeros puedan acceder a la Odontología digital. Queremos que todos vean su potencial y tomen decisiones informadas al invertir en esta tecnología.
La diferencia entre la Odontología clásica y la Odontología digital es drástica gracias al tremendo avance que supone la imagenología 3D, donde todo el proceso que llamamos EDPT digital (de estudio, diagnóstico, planificación y tratamiento) consigue información trascendente inalcanzable en la «era industrial», por su elevado coste y dificultad de acceso. Por otro lado, en la actualidad, esta «era digital» es posible gracias a la gratuidad de programas abiertos, donde los tratamientos asistidos por ordenador se logran con dispositivos de muy bajo coste si se desea. De esta forma, los pacientes digitales mejoran en todos los aspectos sus rutas de atención, con gran cantidad de datos clínicos trascendentes, en menor tiempo, sin o con mínimas molestias, pronósticos ajustados y mayor satisfacción, siendo muy beneficiosos los resultados eligiendo las opciones digitales.
—Por último, ¿cómo se fomentará la investigación e innovación que también necesitan para esta Odontología digital dentro de Andalucía?
—FS: Incentivando a los profesionales, los centros de formación y enseñanza, los laboratorios y las universidades andaluzas para que formen a nuevos profesionales con estudios especializados y que se conviertan, de esta manera, en expertos digitales, dentistas digitales, auxiliares dentales digitales, higienistas digitales, protésicos clínicos digitales y asesores dentales especializados y muy preparados. También es importante, en este sentido, la creación de bases de datos dentales de pacientes digitales y la inteligencia artificial dental aplicada. ●
CÓMO COLABORAR CON LA SODA
«Como Sociedad científicaprofesional sin ánimo de lucro, necesitamos que todos los profesionales dentales andaluces, que pueden alcanzar los 20.000, entren como miembros. También, ayudados de una perfecta administración de los recursos y encontrando ayudas regionales, nacionales y europeas a la digitalización, que sean claramente ventajosas para la Odontología, junto con tantos profesionales de alto nivel preparados, instalaciones dispuestas y centros de producción trabajando hacia estos objetivos», detalla el Dr. Francisco Sánchez.
Si quieres colaborar con la SODA, puedes llamar al teléfono 660 426 987 o acceder a este QR.
101 Gaceta Dental · N o 366 | Mayo 2024
PROTAGONISTAS
Dres. Francisco Sánchez
y Ricardo López.
A la última
Clínica Kreo
«La sonrisa como espejo de una gran salud dental», «Sin salud oral no es posible alcanzar un correcto balance en la salud general» o «Tratamientos completos e integrales para el presente y para el futuro» son algunos de los lemas que abandera la Clínica Kreo, un espacio sanitario innovador en el que el paciente es la prioridad absoluta. No en vano, la atención individual y personalizada es uno de los pilares de la filosofía de trabajo de todo el equipo de esta joven clínica madrileña.
«Libertad es volver a sonreír». Bajo esta premisa nació en 2023 la Clínica Kreo, un espacio de vanguardia en el madrileño barrio de Aravaca donde el cuidado y la tranquilidad del paciente es lo primero. Como destacan sus fundadoras, las Dras. María Gutiérrez y Daniela Carranza, «queríamos que la experiencia Kreo empezase desde el primer contacto y eliminar, en cierto modo, las connotaciones negativas que un espacio médico, sobre todo dental, tiene para muchas personas». Pero, ¿por qué ese nombre?
«El nombre viene de un juego de palabras: Rehabilitación estética y oral, Cirugía, Ortodoncia, Estética, Clínica, Odontopediatría…, pero tenía que transmitir algo muy
importante para nosotros y lo que los pacientes nos llevan transmitiendo durante muchos años: que creen en nosotros y en nuestra Odontología. Por ello lo hemos querido plasmar de una manera muy rotunda y diferenciadora: de ahí la K. Porque somos un poco diferentes y vamos más allá», añaden sus fundadoras. Y es en esa diferencia donde residen, precisamente, los valores de Clínica Kreo: honestidad diagnóstica, ética, profesionalidad, formación, experiencia, calidad y excelencia asistencial. Unos principios que giran en torno a un lema: «El paciente siempre es lo primero».
Por este motivo, «la atención que se le ofrece al paciente es, ante todo, personalizada y diferencial. Intentamos que, desde el primer
102
Gaceta Dental · N o 366 | Mayo 2024 A LA ÚLTIMA. Clínica Kreo


103
Gaceta Dental · N o 366 | Mayo 2024
De izda. a dcha.; las Dras. Daniela Carranza y María Gutiérrez, fundadoras de Clínica Kreo, un espacio de vanguardia en el madrileño barrio de Aravaca. Imágenes: cedidas por las Dras. Carranza y Gutiérrez.
LA ÚLTIMA
Clínica Kreo. A
contacto, el paciente empiece a percibir que lo que va a encontrar en Kreo es diferente y que es una clínica del siglo XXI», cuentan las Dras. María Gutiérrez y Daniela Carranza. En este sentido, «antes de su primera visita, el paciente recibe una serie de contactos e información digital que incluye un recorrido virtual por su futura visita a Kreo. Con eso eliminamos la ansiedad propia de algo desconocido y conseguimos que el paciente acuda con suficiente tiempo e información y pueda aprovechar la primera visita al máximo. Así, antes de venir ya nos conoce un poco», relatan las fundadoras de Kreo.
DETRÁS DE UN BUEN SERVICIO, UN GRAN EQUIPO DE PROFESIONALES
Esta atención personalizada es posible gracias a un grupo de profesionales bien formado y que son, ante todo, EQUIPO. «El equipo humano es la gran esencia de Kreo. Gran parte del mismo lleva trabajando de manera integrada desde hace muchos años, por lo que estamos muy compenetrados. Además, esa creencia profunda en el bienestar del paciente al más alto nivel es lo que ha conseguido mover
de manera cohesionada a todo el equipo», apostillan las Dras. Gutiérrez y Carranza.
«Que todos trabajemos de manera tan estrecha y con la misma filosofía hace que todo avance en la dirección que hemos marcado. Todos creemos en ello, en que siempre se puede mejorar, y todos tenemos las mismas ganas e ilusión. Esto se transmite a los nuevos miembros del equipo que se están integrando en esta familia Kreo», detallan.
Así pues, en Clínica Kreo cuentan con un equipo médico de expertos en Cirugía; Implantología y Periodoncia; Estética, Prótesis y Rehabilitación Oral; Ortodoncia y Ortopedia dentofacial; Odontología conservadora y restauradora; Odontopediatría; y Odontología del bebé y pacientes especiales. Un total de cinco odontólogos a los que se sumará, próximamente, un experto más en Odontología restauradora y estética. Además, «en el departamento de Patología articular se va a incorporar un fisioterapeuta y, en un tiempo, se unirá al equipo un experto en Estética facial», comentan las Dras. Gutiérrez y Carranza.

104
Dental · N o 366 | Mayo 2024 A LA ÚLTIMA. Clínica Kreo
«Queríamos que la experiencia Kreo empezase desde el primer contacto y eliminar, en cierto modo, las connotaciones negativas que un espacio médico, sobre todo dental, tiene para muchas personas», destacan las doctoras María Gutiérrez y Daniela Carranza. Gaceta


Mejorando sus flujos de trabajo a través de la innovación Profilaxis















Una solución única para todos los procedimientos de profilaxis.
El flujo de trabajo en profilaxis de ACTEON® ofrece una solución completa para los dentistas durante cada paso del tratamiento del paciente. Mejora la atención y el rendimiento, sirviendo a los mejores intereses tanto de los dentistas como de los pacientes.









ACTEON MEDICO-DENTAL IBERICA, S.A.U. Una compañía de ACTEON® Group Pol. Ind. Can Clapers Avda. Principal Nº 11H 08181 Sentmenat BARCELONA Tel. +34 932 714 481 info.es@acteongroup.com
información
Productos sanitarios. Para más
lea las instrucciones de uso o el etiquetado dedicado a cada producto.
«La tecnología no serviría de nada sin la base de una gran formación y muchos años de excelencia»
Asimismo, añaden, «contamos con un equipo auxiliar extraordinario compuesto por tres higienistas, una responsable de atención al paciente que es nuestra gran embajadora, y una recepcionista y una coordinadora que se encargan de que todo esté perfectamente engranado y que el paciente se sienta como en casa».
LA TECNOLOGÍA,
UNA HERRAMIENTA
PARA LOGRAR LA EXCELENCIA
Y para que el paciente se sienta como en casa, la tecnología tiene mucho que ver, ya que, en palabras de las Dras. Gutiérrez y Carranza, «nos proporciona unas herramientas que nos ayudan a llegar a unos diagnósticos mucho más precisos y a que nuestros planes de tratamiento más complejos lleguen a resultados de alto nivel, que es nuestro objetivo. Se produce un ahorro de tiempo importante tanto en la propia visita como porque se reduce el número de repeticiones de pruebas».
Para alcanzar la excelencia en los tratamientos odontológicos, la formación continuada de los profesionales es clave. «La tecnología no serviría de nada sin la base de una gran formación y muchos años de excelencia. La tecnología no funciona sola y sin una base sólida puede, incluso, ser un arma de doble filo. Es como un coche de carreras sin un



106
Dental · N o 366 | Mayo 2024 A LA ÚLTIMA.
Para las fundadoras de Clínica Kreo, «la tecnología nos proporciona unas herramientas que nos ayudan a llegar a unos diagnósticos mucho más precisos». Gaceta
Clínica Kreo


buen piloto», destacan las fundadoras de Clínica Kreo. Por ello, «esto implica un equipo en formación constante con un alto grado de exigencia e implicación».
En este sentido, explican, «empleamos toma de registros 100% digital: desde nuestro estudio de fotografía profesional, pasando por pruebas radiológicas digitales 3D con el equipo más avanzado del mercado hasta la grabación intraoral 3D, para la cual usamos los escáneres intraorales de iTero y Cerec. A través de esta tecnología diseñamos planificaciones de ortodoncia en el mismo día de la primera visita; es decir, hacemos un diseño de sonrisa completo para que el paciente pueda ver cómo será su sonrisa futura a través de Digital Smile Design».
«Las coronas y otras restauraciones unitarias se diseñan íntegramente por parte del Dr. Paterna gracias al sistema Cerec CAD/CAM y, de este modo, conseguimos dientes restaurados en el día con un gran control de calidad de todo el proceso de fabricación», apostillan.
LA GESTIÓN Y LA COMUNICACIÓN, PARCELAS IMPORTANTES
Además de la tecnología, en Kreo cuidan mucho la gestión y la comunicación. Por este motivo, «sin descuidar la calidez y la cercanía del trato humano que damos, estamos implementando una visita virtual a través del móvil, y también la recogida y entrega de datos en soportes digitales. Asimismo, nos mantenemos en contacto con los amigos de Kreo a través de redes y web. Para ello intentamos generar contenido de calidad que pueda ser de utilidad para quien nos sigue, tanto si es paciente como si no», especifican las fundadoras.

107
Las Dras. María Gutiérrez y Daniela Carranza, fundadoras de Clínica Kreo.
Gaceta Dental · N o 366 | Mayo 2024
Perfil de Instagram de Clínica Kreo: @clinicakreo
A LA ÚLTIMA
Clínica Kreo.
Asimismo, la planificación de implantes también se realiza íntegramente de manera digital: desde el CBCT (escáner radiológico), a la simulación de dónde se colocarían y de ahí a la fabricación mediante impresora 3D de la férula quirúrgica.
En el resto de áreas también hay una apuesta clara por la tecnología digital: desde la recogida de datos del paciente a la Odontología restauradora mediante la endodoncia con motor guiado por iPad, los composites inyectados, la endodoncia rotatoria, los protocolos de remineralización con nuevos productos, los mantenimientos periodontales con aeropulidor de última generación con regulación de temperatura, el diagnóstico periodontal con sonda Florida, las cirugías mínimamente invasivas y la terapia periodontal con láser.
Además, «desde Clínica Kreo tenemos planificada la incorporación, en los próximos meses, de ciertas innovaciones como la toma de color con espectrofotómetro, una impresora 3D, pantallas táctiles adicionales para presentaciones, un equipamiento adicional de vídeo y herramientas de comunicación y seguimiento del paciente», señalan. Y es que, estar al tanto de las nuevas innovaciones es clave en Clínica Kreo, ya que, como manifiestan sus fundadoras, «para nosotras es impensable volver atrás.
Aunque muchas veces la curva de aprendizaje es dura y consume mucho tiempo, merece la pena y, a la larga, reduce tiempo y mejora experiencia y resultados. Por ello, es fundamental implicar a todo el equipo para que no lo reciban como una complicación, sino como una simplificación, e implementarlo desde
«Hay que mejorar el confort del paciente durante su tratamiento dental y disminuir los tiempos de consulta»
el primer momento en todos los procesos».
Pero, a pesar de los beneficios que, hoy por hoy, proporciona la Odontología digital, ¿qué queda por hacer y mejorar? Las Dras. Gutiérrez y Carranza lo tienen claro: «Hay que mejorar el confort del paciente durante su tratamiento dental y disminuir los tiempos de consulta. También, que todo el tiempo que llevamos invertido en tecnología, lo podamos recuperar con un poco de tiempo libre y poder disfrutar de la familia y los amigos, muchos de los cuales empezaron como pacientes».
Pacientes que, a su vez, valoran y se interesan por saber cómo funcionan las nuevas tecnologías que implementan en la clínica. ●
CLÍNICA KREO
¿Dónde está?
-Camino de la Zarzuela 19-21. Madrid.
¿Quieres saber más?
108
Gaceta Dental · N o 366 | Mayo 2024 A LA ÚLTIMA. Clínica Kreo

EN ESTOS MOMENTOS, EN LOS QUE NADA ES LO QUE PARECE, NOSOTROS, SEGUIMOS PROYECTANDO PRÓTESIS DE GRAN ALTURA

Trabajamos para su tranquilidad, para facilitarles la vida a ustedes y a sus pacientes, con el objetivo constante de conseguir LA PRÓTESIS DEFINITIVA.

Tlf. 91 103 44 37 www.geckomedicaldevices.com

Cómo reducir el absentismo
laboral en las clínicas dentales
Estrategias para maximizar el potencial profesional y alcanzar un éxito sostenible
110 Gaceta Dental · N o 366 | Mayo 2024 TENDENCIAS. Recursos Humanos en la clínica
Imagen: cedida por Instituto IDEOD.
Tendencias
La rotación laboral en las clínicas dentales es un desafío crítico al que se enfrentan los profesionales del sector odontológico en todo el mundo.
Concretamente, en España, las actividades sanitarias están en el tercer puesto de absentismo laboral. Así lo muestra el último informe de Randstad Research sobre el tercer trimestre de 2023, donde indica que los médicos y las enfermeras registraron un 9,2% de absentismo. Las clínicas con una alta rotación se ven afectadas no solo en su calidad de servicio y reputación con los pacientes, sino que también pueden tener un impacto en sus costos de capacitación y administración. Además, se requiere tiempo para la adaptación del nuevo personal a las dinámicas y protocolos de trabajo, trayendo como consecuencia falta de productividad y eficiencia del equipo, afectando a la cohesión del mismo. En este artículo nos introduciremos en uno de los asuntos que más interés suscita entre los alumnos del Máster en Dirección
«Implementar un plan de carrera sólido que brinde a los empleados oportunidades claras de crecimiento y desarrollo profesional puede ser clave para retener talentos en la clínica dental»
y transformación de clínicas de IDEOD: cómo las clínicas dentales pueden reducir la rotación laboral y maximizar el potencial profesional de su personal para lograr un éxito sostenible a largo plazo.
Los beneficios y problemas de la rotación laboral
La rotación del personal puede mostrar ventajas al permitir que las clínicas dentales renueven el personal con ideas frescas, energía nueva y experiencias diferentes. Sin embargo, también puede acarrear costes, lo que motiva a la mayoría de las empresas a retener su talento. Otra cosa diferente es que dejes marchar a personas que no encajan con tus valores y los de tu clínica: eso es una decisión estratégica.
Causas subyacentes de la rotación
Las causas que nos encontramos detrás de la rotación incluyen salarios bajos, discrepancia entre la carga de trabajo y la remuneración, falta de beneficios y prestaciones, escasas oportunidades de desarrollo,

SOFÍA SOLANO MENDOZA
Directora de Instituto IDEOD y de su Máster en Dirección y transformación de clínicas dentales. Directora de Coinsol Dental. Cofundadora de Dental Data. Experta en Recursos Humanos aplicados al sector dental. Optimización de procesos y resultados en clínicas dentales.
111 Gaceta Dental · N o 366 | Mayo 2024 Recursos Humanos en la clínica. TENDENCIAS

percepciones de inseguridad laboral, problemas de comunicación con la dirección, presión laboral, falta de motivación y alta carga de responsabilidad.
En las clínicas dentales es muy común que los trabajadores estén desbordados. Uno de los ejemplos más comunes es el de la recepcionista que hace a veces de higienista, administrativa, coordinadora y hasta de comercial. ¿Cómo pensáis que esta trabajadora se siente teniendo un sueldo mínimo que no se corresponde a su desempeño y responsabilidades?
Es fundamental abordar estas causas subyacentes de manera efectiva para reducir la rotación laboral y promover un entorno de trabajo saludable y productivo.
Estrategias para reducir la rotación laboral y maximizar el potencial profesional
1. Desarrollar un plan de carrera integral. Implementar un plan de carrera sólido que brinde a los empleados oportunidades claras de
crecimiento y desarrollo profesional puede ser clave para retener talentos en la clínica dental. Este plan puede incluir programas de capacitación y desarrollo, oportunidades de promoción interna y asignación de proyectos desafiantes que permitan a los empleados desarrollar nuevas habilidades y avanzar en sus carreras.
Para los dentistas, un plan de carrera bien diseñado puede abarcar la posibilidad de especializarse en áreas específicas de la Odontología, como la Ortodoncia, la Endodoncia o la Periodoncia. Esto no solo amplía su conjunto de habilidades, sino que también les permite satisfacer las necesidades específicas de los pacientes y mantenerse competitivos en el mercado.
Por otro lado, para el personal auxiliar, los planes de carrera pueden implicar la participación en programas de formación continua para mejorar sus habilidades en áreas como la atención al paciente, la gestión de clínicas y la tecnología dental. Este enfoque no solo mejora la
112 Gaceta Dental · N o 366 | Mayo 2024 TENDENCIAS. Recursos Humanos en la clínica
Gráfico sobre los factores doctores. Imagen: cedida por Instituto IDEOD.

eficiencia operativa de la clínica, sino que también aumenta la satisfacción laboral y la retención del personal, al sentirse valorados y respaldados en su crecimiento profesional.
Cuando los empleados sienten que tienen un camino claro para avanzar en sus carreras y alcanzar sus objetivos profesionales, es más probable que se comprometan con la misión y los valores de la clínica. Esto no solo reduce la rotación de personal, sino que también crea un ambiente de trabajo positivo y colaborativo donde todos los miembros del equipo se sienten valorados y motivados para alcanzar su máximo potencial.
Desarrollar planes de carrera en tu clínica te puede traer múltiples beneficios como la retención del talento, la mejora de la calidad del servicio y el crecimiento y éxito del negocio.
2. Mejorar las condiciones laborales. Evaluar y mejorar las condiciones laborales en la clínica dental, como el tipo de contrato, fecha de pago de nómina, pago
de horas extra, carga de trabajo, el equilibrio entre vida laboral y personal y los beneficios ofrecidos, puede ayudar a aumentar la satisfacción y el compromiso de los empleados. Escuchar activamente las preocupaciones y necesidades del personal y tomar medidas para abordarlas puede marcar una gran diferencia en la retención del talento.
3. Fomentar una cultura organizacional positiva. Cultivar una cultura organizacional que promueva el trabajo en equipo, la comunicación abierta, el reconocimiento del desempeño y el apoyo mutuo puede ayudar a fortalecer la cohesión del equipo y mejorar el ambiente de trabajo en la clínica dental. Los empleados que se sienten valorados y apoyados tienden a estar más comprometidos con su trabajo y menos propensos a abandonar la organización.
4. Implementar programas de bienestar y salud laboral. Priorizar el bienestar y la salud laboral de los empleados puede tener un impacto significativo en la reducción de la

114 Gaceta Dental · N o 366 | Mayo 2024 TENDENCIAS. Recursos Humanos en la clínica
Gráfico sobre los factores recepción. Imagen: cedida por Instituto IDEOD.

rotación laboral. Esto puede incluir la implementación de programas de bienestar que promuevan la actividad física, la alimentación saludable y la gestión del estrés, así como la provisión de servicios de apoyo psicológico y asesoramiento para empleados que lo necesiten.
5. Implementación de incentivos según alcance de los KPI. Además de las estrategias convencionales para reducir la rotación laboral, como las mencionadas anteriormente, las clínicas dentales pueden considerar la implementación de incentivos basados en el logro de los principales indicadores clave de desempeño (KPI). Estos incentivos pueden estar diseñados para reconocer y recompensar el rendimiento excepcional en áreas como la producción, la rentabilidad, la eficiencia de agendas por doctores, la aceptación de presupuestos, etc.
Por ejemplo, los empleados que logren superar ciertos objetivos de producción, como el número de tratamientos realizados o la cantidad de ingresos generados, podrían
ser elegibles para bonificaciones adicionales o incentivos monetarios. De manera similar, aquellos que demuestren un alto nivel de eficiencia en la gestión del tiempo y la agenda, reduciendo la ociosidad y maximizando la productividad, podrían recibir incentivos adicionales como reconocimiento por su contribución al éxito general de la clínica.
Al vincular directamente los incentivos al logro de KPI específicos, las clínicas dentales pueden motivar a su personal a trabajar hacia objetivos claros y medibles, al tiempo que promueven una cultura de rendimiento y excelencia. Esto no solo puede ayudar a reducir la rotación laboral al aumentar la satisfacción y el compromiso de los empleados, sino que también puede contribuir a mejorar el rendimiento general de la clínica y su posición en el mercado.
En resumen, la implementación de incentivos basados en el alcance de los principales KPI puede ser una estrategia efectiva para reducir la rotación laboral y maximizar el
115 Gaceta Dental · N o 366 | Mayo 2024 Recursos Humanos en la clínica. TENDENCIAS
Gráfico sobre los factores auxiliares. Imagen: cedida por Instituto IDEOD.
potencial profesional en las clínicas dentales.
Al proporcionar incentivos adicionales a aquellos que contribuyen de manera significativa al éxito de la clínica, las clínicas dentales pueden motivar a su personal a alcanzar metas ambiciosas y establecer un estándar más alto de desempeño y excelencia en el lugar de trabajo.
En conclusión, para abordar de manera efectiva la rotación laboral en las clínicas dentales, es fundamental implementar una combinación de estrategias que aborden tanto las causas subyacentes como las necesidades y expectativas del personal. Desarrollar un plan de carrera integral proporciona a los empleados una visión clara de su futuro dentro de la organización, al tiempo que mejora su compromiso y lealtad. Mejorar las condiciones laborales, como la carga de trabajo y el equilibrio entre vida laboral y personal, es esencial para aumentar la satisfacción y el bienestar de los empleados. Fomentar una cultura
organizacional positiva, basada en el trabajo en equipo, la comunicación abierta y el reconocimiento del desempeño, contribuye a fortalecer la cohesión del equipo y promover un ambiente de trabajo saludable. Implementar programas de bienestar y salud laboral ayuda a mantener la salud física y mental de los empleados, reduciendo el estrés y aumentando su productividad y satisfacción laboral.
Finalmente, implementar incentivos basados en el alcance de los KPI clave proporciona a los empleados un incentivo adicional para alcanzar metas ambiciosas y contribuir al éxito general de la clínica. Estas son solo algunas de las estrategias que ayudamos a aplicar de manera personalizada en cada una de las clínicas de los alumnos del Máster en Dirección y transformación de clínicas de IDEOD. Al adoptarlas de manera integral, las clínicas consiguen reducir la rotación laboral y maximizar el potencial profesional de su personal para lograr un éxito sostenible a largo plazo. ●

116 Gaceta Dental · N o 366 | Mayo 2024 TENDENCIAS. Recursos Humanos en la clínica
Gráfico sobre el salario fijo y las variables. Imagen: cedida por Instituto IDEOD.
19 Sep · Madrid



¡La gran esta de la Odontología!




¡Envía tu candidatura y elige el camino de la excelencia!
Plazo de recepción: 30 de junio
¡Consulta las bases!
27
Organiza: Impulsa:
Edición
Salud mental en la clínica dental: psicología de pacientes y dentistas
Aunque cada vez hay más gente que pide ayuda para tratar su salud mental, son muchos los profesionales de la Odontología que lo hacen tarde, cuando el problema ya está cronificado y es más difícil de gestionar. Entonces, ¿cuándo hacerlo? ¿Cómo identificar que algo no va bien? ¿Quién es más proclive a padecer un problema de salud mental?
Según la Organización
Mundial de la Salud (OMS), el 25% de la población mundial tiene o tendrá algún trastorno de salud mental a lo largo de su vida. Los profesionales sanitarios, en concreto, son uno de los colectivos más vulnerables a padecerlos, siendo la ansiedad y la depresión dos de los trastornos más frecuentes. En el caso de los dentistas, Silvia Álava, doctora en Psicología, empieza por el principio, destacando la importancia de conocer las particularidades de la carrera de Odontología.
Como indica la experta, «es una carrera sanitaria muy técnica y con
características muy específicas. Tú sales de ella preparado para saber cómo tiene los dientes una persona y qué es lo que tienes que hacer, sin embargo, el odontólogo luego no trabaja en el Sistema Nacional de Salud, sino que la mayor parte van a tener que trabajar en un centro privado, ya sea emprendiendo o trabajando para otras personas. Entonces, ese conocimiento de gestión, que no se estudia en la carrera, empieza a generar mucha ansiedad y falta de control, porque lo necesitan en su día a día».
«¿Y cómo lo tengo que ir aprendiendo? Pues autoformándome sobre la marcha, teniendo en cuenta que hay cosas en las que,
118
GDentalk Gaceta Dental · N o 366 | Mayo 2024 GDENTALK. Salud mental en la clínica dental

119
Gaceta Dental · N o 366 | Mayo 2024
Shutterstock/Elnur.
dental. GDENTALK
Salud
mental en la clínica

«En el momento en el que empiezas a notar que hay cosas que no sabes cómo manejar o gestionar y que te pueden estar afectando en tu día a día y en tu trabajo, hay que pedir ayuda»
Silvia Álava
si te equivocas, pueden tener consecuencias económicas muy altas. Entonces, eso genera una ansiedad y un estrés muy específico. Luego sabemos que todas las personas que trabajan de cara al público, es mucho más probable que
desarrollen Síndrome de burnout», detalla Silvia Álava.
«El Síndrome de burnout es uno de los riesgos más peligrosos que acechan a los dentistas a día de hoy. Este se aplica a aquel profesional que está literalmente ‘quemado’ de y en su trabajo. Por muchos y diversos motivos, los profesionales se ven envueltos en una presión asistencial debido a las exigencias de los centros donde llevan a cabo su ejercicio profesional, los cuales les hacen ir a un ritmo de trabajo no deseado generando un estrés que afecta a su situación laboral, personal y familiar», destaca el Dr. Pedro J. Alomar, jefe de estudios de la Facultad de Odontología de la Escuela Universitaria ADEMA-UIB, en el reportaje «Los nuevos riesgos laborales en Odontología» publicado en Gaceta Dental.
Por su parte, el Dr. Simón Pardiñas, odontólogo y divulgador científico en Dentalk.tv., coincide con Silvia Álava y añade, además, que «nosotros, en la carrera de Odontología, sí es cierto que tenemos una asignatura de Psicología, pero más enfocada a cómo tratar al paciente, y no a ti mismo para saber cómo prevenir y gestionar tus emociones. Entonces, tenemos que ir aprendiendo sobre la marcha, sobre todo en lo que se refiere a la gestión de personal, que es un tema muy importante. Y es que, aunque seamos dentistas, los que tenemos clínica propia tenemos que gestionarla como si fuera cualquier otra parte de nuestro trabajo. Entonces, por un lado, tienes que estar muy concentrado tratando a tu paciente, atendiendo a su psicología, ya que cada uno es un mundo; y, por otro, tienes que gestionar la clínica, a los empleados, gestionar la página web o el marketing…».
120
Silvia Álava, doctora en Psicología.
NUEVOS RIESGOS LABORALES EN ODONTOLOGÍA Gaceta Dental · N o 366 | Mayo 2024 GDENTALK. Salud mental en la clínica dental
ÚNETE AL CLUB DE SOCIOS
PARA EMPRESAS DE GACETA DENTAL
Consigue un año de cobertura en todos nuestros canales de comunicación desde el momento de tu inscripción y otras ventajas exclusivas para miembros

VENTAJAS
1.950€ (+IVA/año)
Tarjeta no disponible físicamente
CLUB DE SOCIOS
Descuento 30 %* en acciones print, digitales, experiencias y Premios GD
Publicación de un contenido digital (web y RRSS)
info.gacetadental.com/club-de-socios
Banner (300x150px) durante un mes en gacetadental.com
* descuento no acumulable a los obtenidos previamente
Logotipo en sección «Club de Socios» de gacetadental.com, linkado a tu web
Para más información, contacta con nosotros en Ana Santamaría • 648 234 766 • ana@gacetadental.com
Marta Pérez • 630 369 535 • marta@gacetadental.com
Manuela Binotti • 650 587 681 • mbinotti@gacetadental.com
Media página de publicidad en revista GD (210x140mm) en print y digital
Colaborador de los Premios
Gaceta Dental 2024 con presencia en todas las comunicaciones referentes a los PGD (Premios Gaceta Dental) *hasta completar aforo
LOS SÍNTOMAS A DETECTAR Y LA IMPORTANCIA DE PEDIR AYUDA
Pero, ¿cómo detectar que algo no va bien? ¿Cuáles son los síntomas más frecuentes? «La persona que empieza a sentirse incómoda con su cuerpo, es muy habitual que tenga taquicardias, que le cueste respirar, que tenga opresión en el pecho, un nudo en el estómago y mucha tensión muscular. Son sensaciones que, además, cuando no sabes que son respuesta a la ansiedad, te empiezas a preocupar porque piensas que te va a pasar algo», explica Silvia Álava. Luego, además, está toda la parte del componente cognitivo. «Entramos en un bucle de pensamientos, que los psicólogos llamamos de «rumiación»; es decir, no podemos dejar de darle la vuelta a determinados temas
LA
FDI, ALIADA EN LA SALUD
MENTAL DE LOS DENTISTAS
Con el objetivo de cuidar de la salud mental de los dentistas, la Federación Dental Internacional (FDI) dispone de una web con un kit de recursos para proporcionar a las Asociaciones Dentales Nacionales (NDA) la información y las herramientas adecuadas para brindar apoyo a los dentistas y equipos dentales dentro de sus países. En este sentido, los objetivos de este kit son dos: brindar a los profesionales de la Odontología la información y las herramientas necesarias para manejar las dificultades de salud mental de todos los empleados en la práctica dental, incluidos ellos mismos; y, al mismo tiempo, mejorar la salud y el bienestar de los dentistas y otros miembros del equipo, para garantizar una atención dental de alta calidad a los pacientes.
y eso empieza a ser un problema porque afecta a la capacidad de concentración, sobre todo a la hora de tratar a un paciente».
Una vez que conocemos los síntomas, ¿cuándo pedir ayuda a un profesional? «En el momento en el que empiezas a notar que hay cosas que no sabes cómo manejar o gestionar y que te pueden estar afectando en tu día a día y en tu trabajo», añade Silvia Álava. Y es que, como cuenta la psicóloga, «aunque cada vez hay más gente que pide ayuda, es cierto que muchas veces se pide tarde, cuando la persona ya está muy mal, ha sufrido muchísimo y, en ocasiones, el problema está cronificado».
PROGRAMAS DE ATENCIÓN A LOS SANITARIOS
Es en este aspecto donde entra en juego el papel de programas específicos para el cuidado de la salud mental de los profesionales sanitarios, como el firmado hace unos meses por el Consejo General de Médicos junto a los Consejos de Dentistas, Farmacia y Veterinaria, para el apoyo e impulso en la creación, coordinación e implementación de un Programa de Atención Integral al Profesional Sanitario Enfermo, que favorecerá el acceso voluntario y la rehabilitación del profesional afectado con problemas o dificultades en materia de salud mental. Para el Dr. Óscar Castro Reino, presidente del Consejo General de Dentistas de España, con este acuerdo «queremos reconocer y valorar la importancia de la salud mental en el bienestar general de los profesionales sanitarios. En nuestro caso, los dentistas desempeñan un papel fundamental en el cuidado de la salud bucodental de la población y a menudo tienen que afrontar mucha
122
Gaceta Dental · N o 366 | Mayo 2024 GDENTALK. Salud mental en la clínica dental
presión en su práctica diaria, pues su actividad implica realizar trabajos muy delicados manteniendo altos estándares de calidad. Asimismo, es frecuente atender a pacientes que acuden a la consulta con miedo o ansiedad, lo que dificulta el tratamiento. Estas situaciones generan altos niveles de estrés en el dentista, que pueden derivar en el Síndrome de burnout e incluso en depresión. Por tanto, formar parte de un programa específico de salud que facilite el acceso a terapeutas o psicólogos es fundamental para promover su bienestar general».
ANSIEDAD EN PACIENTES Y PROFESIONALES
Otra casuística importante es cuando los profesionales se enfrentan a pacientes con problemas de salud mental o miedo al dentista. ¿Cómo actuar en este caso? «Tenemos que empezar por validar sus emociones. Decirle que entendemos sus nervios y preocupación, para que se sienta comprendido. Una vez hecho eso, le explicamos lo que le vamos a hacer, sin entrar en tecnicismos. Si tú no validas sus emociones, ese paciente puede ponerse, incluso, a la defensiva, y empezar a cuestionarte como profesional», cuenta Silvia Álava.
«En mi caso, tuvimos un paciente que no había ido al dentista en su vida y tenía la boca destrozada. El solo hecho de entrar por la puerta del dentista le generaba una ansiedad terrible y no era capaz de afrontarlo. Entonces, ¿qué pasa? Que cuando tienen que venir porque ya no soportan ese dolor, además de hacerlo con miedo, lo hacen con vergüenza por el aspecto de su boca. De esta forma, son unos pacientes muy complejos de atender y con los

que hay que ir con mucho cuidado», detalla el Dr. Simón Pardiñas.
Llegados a este punto, ¿en qué momento hay que derivar a un paciente a terapia por este tipo de fobia? «Yo creo que cuando ves a un paciente con cara de preocupación, que está pensando en cuándo va a tener que volver al dentista, ahí habría que comentárselo. Decirle: «Oye, si lo estás pasando realmente mal, quizás sería importante que lo trabajaras con un psicólogo para que te dé herramientas y te genere menos ansiedad venir al dentista». Hay que tener en cuenta, eso sí, el nivel de confianza que tengas con ese paciente», apostilla Silvia Álava. En el caso de los profesionales que sufren ansiedad al enfrentarse a un caso clínico, la experta en Psicología lo tiene claro: «Yo invitaría a trabajar, sobre todo, la parte del autoconocimiento. Es decir, saber
123
ESTRATEGIAS PARA REDUCIR LA ODONTOFOBIA Gaceta Dental · N o 366 | Mayo 2024 Salud mental en la clínica dental. GDENTALK
El Dr. Simón Pardiñas, odontólogo y divulgador científico en Dentalk.tv.
muy bien cómo reacciono y qué determinados casos me pueden suponer un mayor trago a nivel emocional. Hay que reconocer muy bien por qué en un determinado momento reaccionamos de una forma y actuamos así».
También es importante, añade el Dr. Simón Pardiñas, «no aceptar a ciertos pacientes. Ya sea porque no podemos atender sus demandas o porque nosotros no somos capaces de afrontar su caso. De hecho, me ha pasado alguna vez que he tenido que decir que no a un paciente por falta de confianza y cuestionarme todo. Si no confías en mi diagnóstico, en lo que te voy a hacer, entonces yo no soy tu dentista. El problema es que algunos se lo toman mal porque no están acostumbrados a que les digan que no y entonces son los que más insisten en pedir otra cita y en querer volver».
En cuanto a las características de los profesionales y pacientes con problemas de salud mental, en palabras de Silvia Álava, «suelen depender de muchas variables: de personalidad, de circunstancias… Por ejemplo, las personas que tienen más necesidad de control y quieren tener todas las cosas organizadas, cuando algo no sale como les gustaría, son más propensas a generar ansiedad. Sin embargo, aquellas que se adaptan a la flexibilidad, es decir, que cuando surge una cosa que no estaba planeada, son capaces de adaptarse y ser flexibles, tienen menos probabilidad de desarrollar burnout».
«Por otra parte, también depende mucho de si trabajas en una clínica que no es tuya a si tú eres el dueño de esa clínica. En esta última situación, además del añadido de ver a tus pacientes, tienes el rol de gestionar la clínica», concluye. ●
SALUD MENTAL, EN GDENTALK

El tratamiento de la salud mental en la clínica dental fue, precisamente, uno de los últimos temas tocados en el podcast de GDentalk. En este episodio, Patricia Merino, redactora de Gaceta Dental, y el Dr. Simón Pardiñas, se sentaron a charlar con Silvia Álava sobre cuáles son los principales problemas de salud mental que presentan los profesionales de la Odontología y qué medidas implementar en la clínica para evitarlos.
Además, la experta en Psicología ofreció algunas pautas para saber tratar a aquellos pacientes con problemas de ansiedad o miedo al dentista.
¡Accede a este QR para no perderte el episodio sobre salud mental en la clínica dental!
124
Gaceta Dental · N o 366 | Mayo 2024 GDENTALK. Salud mental en la clínica dental
El Dr. Simón Pardiñas, Patricia Merino y Silvia Álava.



másteres en odontología
100% de inserción laboral

Con más horas de aprendizaje práctico. En centros externos o en nuestra Clínica Odontológica Universitaria, para garantizarte un contacto directo y supervisado con los pacientes
Elige el tuyo:
Máster Universitario en Ortodoncia y Ortopedia Dentofacial

Máster de Formación Permanente en Especialización en Ortodoncia (inglés o español)
Máster de Formación Permanente en Cirugía Bucal



Máster de Formación Permanente en Cirugía Bucal e Implantología Bucofacial
Máster de Formación Permanente en Endodoncia (inglés o español)

Máster de Formación Permanente en Odontopediatría Integral
Máster de Formación Permanente en Especialización en Prótesis Avanzada

· · · · · · ·
CEU
Universidad
LEVEL UP DA
Cardenal Herrera
EL SALTO AL SIGUIENTE NIVEL
TENDENCIAS. Rincón

Scanbodies: la impresión digital llega a la Implantología
126 Gaceta
Simulación escaneado con Virtuo Vivo y Smart Flags de Apollo. Cortesía Dr. Fragola.
Dental · N o 366 | Mayo 2024
digital
Tendencias
En la era de la Odontología digital, los avances tecnológicos han transformado la forma en que los profesionales abordan los procedimientos de toma de impresión de los implantes. Entre las innovaciones más significativas se encuentran los scanbodies o transfer de impresión digitales para implantes. En este artículo exploraremos a fondo qué son, su importancia en el flujo de trabajo digital, cómo influyen en la calidad final de las restauraciones, los posibles desafíos que los profesionales pueden enfrentar al utilizarlos y el papel creciente de la inteligencia artificial en su escaneo y reconocimiento.
Los scanbodies son elementos cruciales en el proceso de toma de impresiones digitales para implantes Estos dispositivos, a menudo hechos de titanio o materiales poliméricos de alta calidad, se ajustan directamente sobre los implantes colocados en el
«Los scanbodies utilizados en entornos clínicos deben cumplir con regulaciones y estándares de calidad específicos»
paciente o sobre pilares intermedios llamados interfases. Su diseño tridimensional específico permite servir como marcadores de posición y referencia durante la captura de imágenes mediante escáneres intraorales o de laboratorio para poder indicar claramente la posición tridimensional y su relación con los tejidos circundantes duros y blandos.
La precisión es un factor fundamental en la Odontología restauradora y los scanbodies desempeñan un papel crucial en garantizar resultados óptimos. Al capturar la posición exacta y la orientación de los implantes, estos dispositivos permiten una planificación precisa de la restauración.
Esto es especialmente crítico en casos de múltiples implantes o restauraciones complejas, donde la alineación y la relación de los dientes artificiales con las estructuras adyacentes son cruciales para el éxito del tratamiento, siendo crítico,

Director médico de Estudio Dental Majadahonda. Licenciado en Odontología, Universidad Complutense de Madrid. Máster en implantología, Periodoncia y Rehabilitación Oral, New York University. Senior fellow y speaker ITI (International Team for Implantology). Anthogyr international speaker. CEO IDE Immersive Dental Experiences.
DR. GIULIANO FRAGOLA
127 Gaceta Dental · N o 366 | Mayo 2024 Rincón digital. TENDENCIAS

sobre todo, en impresiones de implantes mandibulares en totalmente desdentados.
TIPOS DE SCANBODIES
Existen en el mercado diferentes tipos de scanbodies, no siendo los mismos para uso clínico y de laboratorio. -Scanbodies de uso clínico. Estos scanbodies están diseñados para su uso intraoral, con una menor superficie para el registro comparado con los de laboratorio. En lo referente a su proceso de fabricación pueden ser de titanio, materiales poliméricos (PEEK poliéter éter cetona) o la combinación de ambos con la porción en contacto con el implante metálico y el resto de PEEK. Pueden diseñarse para restauraciones unitarias atornillándose directamente al implante o múltiples, sobre pilares intermedios o interfases.
Los diferentes materiales de confección influyen, de manera decisiva, en la precisión final de los registros obtenidos. Su utilización debe seguir las indicaciones de los fabricantes, pudiendo ser de un solo uso o reutilizables. Los procesos de esterilización deben ajustarse a los requerimientos del fabricante para evitar distorsiones.
Los scanbodies deben mantener todas sus características geométricas intactas después de cada ciclo de uso, pues de otro modo darán lugar a registros imprecisos con la consiguiente falta de ajuste de las prótesis elaboradas a partir de nuestras capturas.
La colocación y el apretamiento de los scanbodies sobre los implantes es crítica para no dañar las zonas de contacto scanbody-implante, así como para dejarlos posicionados en su lugar exacto; de ahí que estén cobrando mucha más fuerza los metálicos o combinados.
Dentro de los de uso clínico hay multitud de formas, ya que cada sistema tiene los suyos propios y cada vez más empresas se dedican a comercializar dispositivos compatibles con la mayoría de los sistemas del mercado.
Es crucial entender que se trata de un registro digital no físico de la geometría de una superficie en el medio oral para transferir la posición tridimensional del implante, su conexión y relación con los tejidos circundantes. De ahí que el resultado final y salud periimplantaria a largo plazo dependa, en gran medida, de la calidad de nuestros registros.
Es por ello por lo que no debemos basar nuestra elección en la búsqueda de los dispositivos de menor precio, sino en una mayor calidad y ajuste a los implantes que vamos a utilizar. -Scanbodies de laboratorio. Diseñados específicamente para su uso en el laboratorio de prótesis. Estos scanbodies permiten la fabricación precisa de la estructura de la prótesis sobre implantes a partir de un registro de implantes convencional con elastómeros y transfers de impresión convencionales.
128 Gaceta Dental · N o 366 | Mayo 2024 TENDENCIAS. Rincón digital
Detalle scanbodies metálicos sobre multiunit sistema Anthogyr. Cortesía Dr. Fragola.

MULTI-UNITmini
Nuevo pilar transepitelial estrecho diseñado para la lucha contra la periimplantitis gracias a la mejora del espacio biológico supracrestal.
PLATAFORMA
REDUCIDA 3,8 mm.
DISEÑO ESTRECHO
Mejora la cantidad de fibras de colágeno, incrementando la vascuralización del sellado mucoso.


GEOMETRÍA EXTERNA
Convergente hacia coronal.
Favorece la migración en esa dirección de los miofibroblastos presentes en el tejido conectivo. 1,5 2,5 3,5 4,5 5,5 6,5
BIOGOLD
Recubrimiento de superficie biocompatible.


Titanio 6AL-4V.
Grado 5. (Alta resistencia).

Dispone de librería para Ti-base y pilar provisional.
Disponibles en diferentes Alturas desde 1,5mm. hasta 6,5mm. para:
STRAUMANN® BONE LEVEL® Interna NC 3,3
BIOHORIZONS® TAPERED® Hexágono Interno 3.0 I 3,5
MIS SEVEN® Hexágono Interno NP3,30 I SP 3,75 /4,20
NOBEL BIOCARE® NOBELACTIVE® Interna Activa NP 3,5/3,75

OSSTEM® TS/ HIOSSEN® ET Cónica Interna MINI
BIOMET 3i® CERTAIN® Hexágono Interno “Click” NP3,4
BTI® Interno Tetralobular Interno NP3,5
ZIMMER® SCREW-VENT® Hexágono Interno NP 3,5
ASTRA® TECH OSSEOSPEED® Cónica Interna Yellow 3,0 I Aqua 3,5/4,0


Smart Implant Solutions T. (+34) 943 322 812 Iinfo@smartimplantsolutions.com I www.smartimplantsolutions.com ¡NOVEDAD!
I
Su diseño suele otorgarles mayor volumen y altura, facilitando la transferencia exacta de la posición de los implantes desde el modelo de escayola a través de escáneres de sobremesa.
CARACTERÍSTICAS
DE LOS SCANBODIES
Es muy frecuente ver que, para ahorrar costes globales, se buscan scanbodies económicos o se procede a imprimirlos, pero existen razones importantes por las cuales esta práctica no es recomendable:
-Precisión y ajuste. Los scanbodies deben fabricarse con tolerancias muy ajustadas para una precisión óptima en la toma de impresiones. Imprimirlos en una impresora 3D convencional puede resultar en variaciones dimensionales que afecten su ajuste sobre el implante, comprometiendo la calidad de la impresión.

-Material y durabilidad. Los scanbodies comerciales están fabricados con materiales específicos que garantizan resistencia, durabilidad y biocompatibilidad en el ambiente oral. Los materiales utilizados en impresiones 3D caseras pueden no cumplir con estos estándares, afectando la durabilidad y el rendimiento del scanbody.
-Contaminación y estabilidad dimensional. Los scanbodies deben someterse a procesos de esterilización adecuados para evitar la contaminación cruzada y mantener un ambiente clínico seguro. Los materiales de impresión 3D pueden no ser adecuados para estos procesos, comprometiendo la estabilidad dimensional y la seguridad del paciente.
-Cumplimiento normativo y responsabilidad. Los scanbodies utilizados en entornos clínicos deben cumplir con regulaciones y estándares de calidad específicos. Imprimir tus propios scanbodies puede dificultar la garantía de cumplimiento normativo y asumir la responsabilidad por cualquier resultado adverso.
El tipo de escáner intraoral utilizado también juega un papel crucial en la toma de impresiones con scanbodies. Los escáneres intraorales de última generación, con tecnología de alta resolución y captura rápida de imágenes, pueden proporcionar resultados más precisos y detallados. Estos escáneres permiten una exploración minuciosa de los scanbodies y los tejidos circundantes, garantizando una captura completa de la posición y la anatomía de los implantes. Además, algunos escáneres intraorales ofrecen herramientas de visualización en tiempo real y funciones de
130 Gaceta Dental · N o 366 | Mayo 2024 TENDENCIAS. Rincón digital
Detalle del brazo robótico para escaneado de modelos de laboratorio. Cortesía de MMC MIllbox.























ULTRADENT.ES | info@ultradent.es 696 616 752 Área Norte - 616 982 237 Área Levante - 699 888 731 Área Centro MÁS ESTUDIADO Y PROBADO QUE CUALQUIER BLANQUEADOR DENTAL PROFESIONAL



«La precisión en el proceso de toma de impresiones de implantes dentales con scanbodies es fundamental para el éxito de la restauración final»
corrección automática, lo que facilita al profesional garantizar la precisión de la impresión al igual que sistemas de inteligencia artificial que ayudan en el reconocimiento de los mismos durante el procedimiento de escaneado y su digitalización automática de una manera más rápida y precisa.
En el proceso de toma de impresiones digitales de scanbodies, la parte más importante a registrar es la posición tridimensional exacta del scanbody y las estructuras adyacentes. La captura precisa de esta información garantiza una planificación correcta de la restauración y una adecuada relación oclusal. Además, es fundamental asegurar que el scanbody esté correctamente fijado al implante durante la captura de imágenes para evitar movimientos que puedan comprometer la precisión de la impresión.
CONSIDERACIONES PARA UNA BUENA TOMA DE IMPRESIÓN
Para una buena toma de impresión digital de implantes con scanbodies, deben tenerse en cuenta algunas consideraciones.
-Preparación del paciente. Es importante tener un buen acceso a toda la cavidad oral para registrar la mayor cantidad de detalles posible tanto de los scanbodies como de tejidos circundantes. Será crucial separar los labios y disponer de suficiente apertura bucal para desplazar nuestro escáner intraoral sin dificultad.
-Selección del scanbody. Elija el tipo de scanbody adecuado para el caso específico, considerando el tipo de implante, la ubicación y la restauración planificada bien unitaria o múltiple.
-Preparación del scanbody. Se debe verificar que el scanbody esté intacto, limpio y libre de residuos o contaminantes con la zona de conexión al implante o interfase perfectamente conservada.
-Fijación del scanbody. Se colocará el scanbody en el implante asegurándonos de que esté completamente
Imagen fichero STL generado a partir de escaneado intraoral.
Cortesía Dr. Fragola.
132 Gaceta Dental · N o 366 | Mayo 2024 TENDENCIAS. Rincón digital

Tel. 91 573 86 25 / 93 300 14 56 info@masterdental.com



y CS8200

OFERTAS EXPODENTAL 2024 “40 ANIVERSARIO”









INCLUYE: PACK DE ORTODONCIA


Al comprar un escáner OVO obtienes un vale en productos de Ortodoncia de marca SIA por valor de 500 .-€ , y además una caja de prueba de alineadores transparentes i-liner (máximo 20 alineadores)
*Opción: 12 Implantes con marcas concertadas


*desde 280.-€/mes(6) *desde 788,96.-€/mes(6) *desde 425,37.-€/mes(6) *desde 160,45.-€/mes(6)


PRECIO: 6.300€
OFERTA: 4.750€
*24 pagos de 198€/mes






Dental Microscope VS-S750
-Binoculares inclinables con ajustador de distancia pupilar
-Cargador de aumento de zoom
-Iluminación LED 70.000 Lux
-Lente de enfoque variable 200-400 mm
-Brazo súper equilibrio
-Cámara 4K incorporada para tomar videos y fotografías
-Monitor y soporte para monitor -Base Móvil



RESOLUCIÓN
CS8100
PUMA ELI AREA ESTETICA E 30 BASIC F.O.V 15x20 www.masterdentalsa.com DESCUBRE MÁS:
75um
OP3D LX UNIQA BASIC INCLUYE TABLET SIN CARGO IS 3800 W LASER WIRELEES 6WAT SMARTCAM XS OFERTA: 2.552€ PROCAM XS OFERTA: 2.152€ *IVA
s.e.o.u
10%
entrada. Pendiente
aprobación financiera *Válido hasta 30.05.2024
*desde
*desde 400,40.-€/mes(6) OVO
NO INCLUIDO. Importes aproximados,
con
de
de
*desde 148,48.-€/mes(6) *desde 282,87.-€/mes(6)
212,48.-€/mes(6)
Kit
MOD
Master 4K PRECIO: 12.690€ OFERTA: 11.400€ *desde
Profesional Sin Cargo
VS-S750
178,69.-€/mes (6)
*CONSULTAR OTRAS OPCIONES *CONSULTAR OTRAS OPCIONES
asentado y apretándolo según las especificaciones del fabricante, utilizando el destornillador adecuado para evitar daños al dispositivo.
-Escaneado intraoral. Se recomienda utilizar un escáner intraoral de alta calidad, calibrado correctamente y con puntas nuevas que no presenten deterioros en los espejos o tips de registro.
Se comenzará el escaneado desde una posición clara del arco dental, avanzando gradualmente hacia el área del implante.
Algunos sistemas intraorales permiten escanear primeramente el área donde se encuentran los implantes sin los scanbodies para después crear un nuevo archivo añadiendo el registro de los mismos de manera que podamos reproducir con mayor precisión tejidos duros y blandos y, posteriormente, la posición tridimensional de los implantes.
Hay que asegurarse de capturar todas las superficies del scanbody y los tejidos circundantes con movimientos suaves y precisos. Por último, habrá que verificar la calidad




de las imágenes para asegurarse de que no haya áreas faltantes o distorsionadas o que hayan sido «rellenadas» por el software del sistema de toma de impresión digital.
PROCESAMIENTO DE LOS DATOS ESCANEADOS
Los datos obtenidos serán transferidos a un soft ware de diseño dental compatible con las geometrías de los scanbodies empleados para que sean reconocibles y sustituidos por el implante virtual para proceder al diseño de la prótesis. Es importante comunicarse con nuestro laboratorio para especificarle qué scanbodies hemos empelado, de modo que pueda proceder al realizar el «matching» o superposición de la imagen virtual intraoral con la librería del soft ware de diseño.
Como conclusión, decir que la precisión en el proceso de toma de impresiones de implantes dentales con scanbodies es fundamental para el éxito de la restauración final. Siguiendo este procedimiento paso a paso, los profesionales pueden garantizar una captura precisa de la posición y la anatomía de los implantes, lo que resulta en restauraciones bien ajustadas y estéticamente satisfactorias para los pacientes. La elección del scanbody adecuado, el uso de un escáner intraoral de calidad y el procesamiento cuidadoso de los datos escaneados son aspectos clave para obtener resultados óptimos en Odontología digital. Con una atención meticulosa a cada paso del proceso, los profesionales pueden brindar a sus pacientes restauraciones implantosoportadas que no solo sean funcionales y duraderas, sino también estéticamente armoniosas. ●
Modelo virtual en Software CAD a partir de impresión digital.
Imagen: cedida por el Dr. Fragola. 134
Rincón
Gaceta
Dental · N o 366 | Mayo 2024 TENDENCIAS.
digital
¡Envía tus inquietudes sin pensarlo dos veces!
Si te preocupa o interesa algún tema en concreto sobre el mundo dental, envía un correo a info@gacetadental.com con el asunto "Sugerencia de contenido" y tu nombre.

gacetadental.com


¿Quieres sugerir algún contenido?
GACETA DENTAL
RECABAN EL APOYO DE LAS ADMINISTRACIONES AUTONÓMICAS
Sociedades científicas, Consejo y Universidad, unidos por las especialidades



De izda. a dcha.; José Aranguren, Lluís Giner, Daniel Torres, Asunción Mendoza, Ignacio Rodríguez, Ignacio García Espona, Guillermo Pradíes y José Nart. Imagen: AEDE. En las fotos de la parte derecha, reunión del Consejo de Dentistas con el gobierno aragonés -Óscar Castro, José Luis Bancalero, Daniel Torres y Jaime Alfonso- y reunión del Consejo con el Departamento de Salud de la Gereralitat de Cataluña (Joan Carrera, Lluís Giner, Carme Bertral, José Nart y Rafael Ruiz).
AEDE, SEPA, SECIB, SEOP, SEDO y SEPES, junto con el Consejo General de Dentistas y de la Conferencia de Decanos de Facultades de Odontología, envían a las administraciones autonómicas un documento que analiza cómo llevarlo a cabo técnica y económicamente.
La petición, que ya han recibido las distintas administraciones autonómicas, plantea la creación de las especialidades de Odontología en un formato de escuela tipo MIR sin remuneración del profesorado y analiza las normas de acceso, el número de profesionales necesario, los recursos asistenciales disponibles y el presupuesto preciso para su puesta en marcha.
La Sociedad Española de Endodoncia (AEDE), la Sociedad Española de Periodoncia
y Osteointegración (SEPA), la Sociedad Española de Cirugía Bucal (SECIB), la Sociedad Española de Odontopediatrí a (SEOP), la Sociedad Española de Ortodoncia y Ortopedia Dentofacial (SEDO) y la Sociedad Española de Prótesis Estomatológica y Estética (SEPES) persiguen con esta acción un doble objetivo: el de garantizar una formación de calidad a los odontólogos y el de proporcionar el mejor servicio a los pacientes que podrán beneficiarse de una atención especializada y regulada.
ACREDITACIÓN DE TÍTULOS
Las consejerías de sanidad o salud de las comunidades autónomas, tal y como establece el Anexo I del Real Decreto 589/2022, de 19 de julio, son las encargadas de acreditar la necesidad de los nuevos títulos de especialista en Ciencias de la Salud. De este modo, estas seis sociedades científicas de ámbito nacional, que reúnen al 70% de los profesionales de cada
136 NOTICIAS DE ACTUALIDAD
Gaceta Dental · N o 366 | Mayo 2024
APOYOS REGIONALES
Murcia, Andalucía, Comunidad de Madrid, Cataluña, Cantabria, Extremadura, Baleares, Castilla y León y Aragón ya han brindado su apoyo a la Organización Colegial de Dentistas para impulsar la creación de las especialidades odontológicas.
una de sus respectivas áreas de conocimiento, llevan años trabajando conjuntamente para solicitar a las administraciones autonómicas el reconocimiento de las especialidades odontológicas y su correspondiente formación de postgrado.
En el documento enviado a las áreas de salud de las distintas autonomías, no solo instan a sus gobiernos a crear un nuevo título de especialista en Ciencias de la Salud o diploma de área de capacitación específica, sino que plantean la revisión de los ya fijados, así como el acceso y la formación de las áreas de capacitación específica. De hecho, desde el equipo de trabajo de estas sociedades científicas han establecido las normas aplicables a las pruebas anuales de acceso a plazas de formación en especialidades en Ciencias de la Salud, el número de profesionales necesarios, los recursos asistenciales disponibles y el presupuesto que esto supone.
El siguiente paso es elevar la petición al Ministerio de Educación, para lo que es necesario el apoyo de al menos siete de las 17 consejerías autonómicas que ya han recibido la petición. El equipo de trabajo de la Comisión de Especialidades está formado por José María Aranguren, presidente de AEDE; José Nart, de SEPA; Daniel Torres, de SECIB; Asunción Mendoza, de SEOP; Juan Carlos Pérez Varela, de SEDO; Guillermo Pradíes, de SEPES; Lluís Giner, de la Conferencia de Decanos; Óscar Castro, del Consejo General de Dentistas; e Ignacio Rodríguez como representante de las sociedades científicas en la institución nacional. ●







Productos 3MTM TransbondTM con las mejores condiciones:



Pídalo hoy mismo directamente



La Súper tienda de ortodoncia Más de 23.000 artículos increíblemente baratos ® Ortho Depot www.orthodepot.es más IVA € 00 99 € 99 82
a
EN BENEFICIO DE PROFESIONALES Y PACIENTES
Andalucía invierte 3,5 millones de euros en su Plan de Salud Bucodental

El Plan Integral de Salud Bucodental de Andalucía 2023-2027 plantea una mayor accesibilidad de los usuarios a los servicios de salud bucodental.
Se trata de un plan que, igualmente, prevé actualizar y mejorar el equipamiento de los gabinetes odontológicos de Andalucía con el objetivo de mejorar la calidad de la atención odontológica e incorporar tecnologías avanzadas tanto en Atención Primaria como en Atención Hospitalaria. Este nuevo equipamiento beneficia a los profesionales, aportando mayor eficiencia y precisión, y también a los propios usuarios, proporcionando más comodidad, seguridad y personalización en los tratamientos. Tal y como explican desde la Junta de Andalucía, el plan contempla la creación de nuevos gabinetes con el propósito de acercar a los ciudadanos los servicios de salud bucodental. De este modo, se abrirán 17 nuevos gabinetes en Andalucía bajo la premisa de que todos los ciudadanos tengan una consulta dental pública a menos de 30 minutos de desplazamiento de su zona básica de salud. En cuanto a la Odontología hospitalaria, se potenciará la red de dentistas
de Andalucía, dotando a todas las provincias de este recurso. Esto supondrá una mejora significativa en la asistencia hospitalaria.
Durante la presentación del Plan, a la que también ha asistido el secretario general de Humanización, Planificación, Atención Sociosanitaria y Consumo, Francisco Javier Vázquez, la consejera ha subrayado que «mantener una boca sana no solo es esencial para gozar de una buena calidad de vida, sino que también la salud bucodental está estrechamente relacionada con la prevención de enfermedades graves, como enfermedades cardíacas y diabetes». Por este motivo, ha abundado que «nuestra apuesta por la salud bucodental es cada vez más exigente».
La consejera ha incidido en el esfuerzo por la formación para contar con una red de referentes a disposición de los usuarios que redundará en el incremento de la calidad de la asistencia prestada. Por ello, en colaboración con IAVANTE, se ha puesto en marcha el «Programa Referentes», una formación especializada mediante Diplomas Universitarios de las Facultades de Odontología de Granada y Sevilla para profesionales en las áreas de conocimiento de Medicina Oral, Cirugía Oral, Odontopediatría y Endodoncia. Este Programa persigue que los dentistas especializados mejoren la asistencia de la población en Atención Primaria, además de los títulos de Odontología Hospitalaria y Endodoncia que competen a los dentistas de Atención Hospitalaria. ●
¡MAS DETALLES DEL PLAN EN NUESTRA WEB!
138 NOTICIAS DE ACTUALIDAD
Foto de familia realizada en el acto de presentación del Plan de Salud Bucodental. Foto: Junta de Andalucía.
Gaceta Dental · N o 366 | Mayo 2024

120 PROFESIONALES ASISTIERON A LA CITA
Tenerife acoge la V Jornada Canaria de Odontología Legal

Con la asistencia de más de 120 profesionales, la presidenta del Colegio de Dentistas de Santa Cruz de Tenerife, Concepción Mercedes León Martínez, inauguró la V Jornada Canaria de Odontología Legal, el pasado 6 de abril, en el Círculo de Amistad XII de Enero de la isla canaria.
La presidenta del Colegio de Dentistas de Santa Cruz de Tenerife, Concepción Mercedes León Martínez, abrió la V Jornada Canaria de Odontología Legal destacando la importancia de que los dentistas estén informados en materias legales, con el fin de enfrentarse con toda la información a problemas actuales de la profesión como el intrusismo o la publicidad engañosa. En este sentido, alentó a los dentistas a denunciar ante el Colegio cualquier caso de intrusismo que detecten, para que así la
entidad profesional pueda tomar las acciones de investigación y legales pertinentes. La primera ponencia de la Jornada Canaria de Odontología Legal se centró en la optimización fiscal disponible en el caso de los dentistas, en el actual entorno económico, un tema a cargo del economista y abogado, Víctor A. Sanz DelgadoYumar.
A continuación, se abordó la solución de conflictos tanto con los pacientes y sus familiares como con los compañeros de la clínica dental. Sebastián Elías León Martínez, asesor jurídico colaborador del Colegio de Dentistas tinerfeño, y socio fundador de ADL Abogados, trató también los ámbitos de la deontología y el secreto profesional.
Además, se abordaron los casos en los que por orden judicial o vía civil puede ser solicitado su testimonio, donde el dentista no revelará aquellos datos que no sean necesarios para la resolución del caso, una obligación del secreto profesional que es para siempre, incluso si el paciente ha fallecido. A continuación, la Fiscal Decana de lo Civil de la Audiencia Provincial de Santa Cruz de Tenerife, Carmen Ávila Álvarez, se centró en el consentimiento informado y la capacidad jurídica en la asistencia odontológica a menores en situación de crisis familiar y discapacitados. La Fiscal explicó en qué consiste la patria potestad y, en caso de separación y divorcio, la forma de abordar desacuerdos entre los progenitores en la asistencia sanitaria. También aclaró que quien tiene la guardia y custodia puede llevar al menor a un servicio sanitario en caso de urgencia, si no ha podido contactar con el otro progenitor. Cuando alguno de los progenitores solicite la intervención judicial ante un desacuerdo, los menores que tengan más de 12 años, deben ser escuchados en el juzgado.
140 NOTICIAS DE ACTUALIDAD
Gaceta Dental · N o 366 | Mayo 2024
Ponentes y Junta de Gobierno del Colegio de Dentistas de Santa Cruz de Tenerife. Foto facilitada por el colegio insular.
Otro de los aspectos que causaron más preguntas entre los dentistas asistentes fue la comprobación del acuerdo de los dos progenitores en caso de un tratamiento dental. Tal y como explicó la Fiscal Decana, Carmen Ávila Álvarez, el dentista tiene la obligación de recabar los datos, en caso de ser menores, de guardia custodia y patria potestad y, si uno de los progenitores requiere en la clínica dental que se pare el tratamiento, deben hacerlo, comunicárselo al otro, y realizar un informe con los posibles perjuicios bucodentales que esta suspensión puede ocasionar en la salud bucodental. Además, los mayores de 16 años pueden firmar el consentimiento informado si lo requieren. En el caso de personas con discapacidad, lo habitual es que exista una persona guardadora de hecho y también debe recabarse esa información al recoger los datos del paciente. Las apreciaciones subjetivas del dentista se recomienda que figuren en la historia clínica.
CONSENTIMIENTO INFORMADO
Víctor Díaz-Flores García, asesor legal del Colegio de Odontólogos de la I Región, dirigió su ponencia a la seguridad del paciente, la historia clínica y el consentimiento informado. DíazFlores recomendó los apartados específicos que debe incluir una historia clínica, con el fin de que sea útil tanto en los tratamientos de salud bucodental del paciente como para que el profesional pueda contar con toda la información necesaria de cara a cualquier aspecto legal que sea requerido.
Los datos deben conservarse, al menos, cinco años después del último tratamiento realizado.
Por último, el abogado especialista en Responsabilidad Civil y director de la Asesoría Jurídica del Consejo General de Colegios Oficiales de Dentistas de España, Pablo Málvarez, habló de los tratamientos estéticos con Ácido Hialurónico y toxina botulínica y las limitaciones para los dentistas. Tras finalizar todas las ponencias, se celebró una mesa redonda con los ponentes participantes, a los que los asistentes pudieron plantear sus dudas. ●
¡No lo piense más!




Seremos su único proveedor. Le prestaremos nuestros servicios con una cómoda cuota mensual.
Protección Radiológica
Servicio de Dosimetría
Prevención de Riesgos Laborales
Protección de Datos
Gestión de Residuos Clínicos
Tramitación Documental
Destrucción de Documentación Confidencial
Formación stericycle.es | 900 922 903
Confíe en la única compañía que puede ofrecerle soluciones integrales para todos los servicios que necesita.
Le haremos un presupuesto personalizado. Solicite información de nuestras soluciones: info.espana@stericycle.com
© 2024 Stericycle, Inc. Todos los Derechos Reservados. SRCL06pub042024
LA UCM CONTARÁ CON UN ROBOT ÚNICO EN EUROPA
Fuerte impulso a la investigación en IA y robótica aplicada a la Odontología
El profesor Guillermo Pradíes, director del Máster en Odontología Restauradora basada en las Nuevas Tecnologías de la Universidad Complutense de Madrid, ha viajado hasta Xi’an (China) para firmar un acuerdo de colaboración con el State Key Laboratory of Oral & Maxillofacial Reconstruction and Regeneration y recibir el primer sistema de navegación dinámica autónoma, capaz de realizar la preparación para lechos de implantes.
Mediante dicho acuerdo, su Máster y su equipo de investigación «Odonto CAD/CAM», el cual lleva trabajando desde 2007 y tiene más de 40 publicaciones relacionadas con este campo de la Odontología, realizarán colaboraciones científicas para desarrollar nuevas líneas de investigación en inteligencia artificial y robótica aplicada a la Odontología.
El profesor Pablo Xing, de su equipo, ha viajado también con el Dr. Pradíes y juntos han recibido entrenamiento previo y recibirán, en breve, el primer sistema de navegación dinámica autónoma, capaz de realizar la preparación para lechos de implantes.
«Comenzaremos con ensayos in vitro relacionados con tecnología de impresión 3D, navegación dinámica, etc.; y en el momento en el que el robot esté aquí, empezaremos a realizar nuevos ensayos preclínicos y luego clínicos. En China, los equipos que tienen este robot tienen operados más de 7.000 casos ya desde 2017», ha explicado el Dr. Pradíes.
No obstante, ha detallado el Dr. Pradíes, «aunque, a priori, dicho sistema será el primero que existirá en Europa, prefiero ser prudente en

este sentido hasta que realmente tengamos al robot en nuestras instalaciones. Estas gestiones son siempre delicadas y existen factores relacionados con marcados CE, aduanas, etc.; que deben ser todavía gestionados. En cualquier caso, si finalmente se materializa, será importante para nuestro grupo de investigación y entiendo que, a la larga, para nuestro país, que se colocará en una situación privilegiada en este campo».
El Dr. Pradíes ha querido destacar especialmente la participación del Dr. Pablo Xing en su equipo de trabajo ya que, «además de su preparación en el aspecto clínico y científico, es bilingüe chino-español y ha sido clave en las gestiones relacionadas a este respecto». ●
142 NOTICIAS DE ACTUALIDAD
Gaceta Dental · N o 366 | Mayo 2024
Los Dres. Pradíes y Xing, durante su reciente visita a China. Foto facilitada por el Dr. Pradíes.














Empresa de diseño y reforma de clínicas dentales, con más de 15 años de experiencia, a su disposición para ayudarle a poner en marcha de la forma más able su proyecto de clínica dental.
más de 100 clínicas dentales puestas en funcionamiento
ponga el proyecto de sus sueños en buenas manos también tramitamos Licencias de apertura Adaptación a normativa Sanitaria Rodapie




Diseño
de clínicas dentales
y Reforma
PROYECTOS DE OBRA COMPLETOS DESDE:
620 997 577 +Información: Calle Federico Grases, 22 Madrid www.wolfdyr.com 30.000€
pintura sanitaria**
quirúrgico, medidas mínimas
etc... *modelo aceptado por Sanidad ** cha técnica y certi cado info@wolfdyr.com equipo de profesionales con experiencia en el sector dental
curvo*,
grifo
gabinete,
REUNIÓN DE EXPERTOS LIDERADA POR SEPA
¿Qué papel juegan los antisépticos bucales en las enfermedades periodontales?
Dar prioridad a la prevención y tratamiento de las enfermedades periodontales y la promoción de la salud periodontal es esencial para mejorar los resultados generales de salud, preservar los dientes naturales, reducir los costes de atención médica, mejorar la calidad de vida y promover la salud pública en general. Así se ha destacado en una Cumbre Internacional de Expertos, que se celebró en la Casa de las Encías de Madrid, sede de la Fundación SEPA.
En este encuentro, impulsado por Kenvue y SEPA, se hizo una puesta en común el conocimiento actual y se analizó exhaustivamente la literatura científica y las directrices internacionales imperantes para tratar de aclarar el papel de ciertos colutorios en la higiene bucal, y en el tratamiento de la gingivitis y la prevención de la periodontitis. «Las enfermedades periodontales son muy prevalentes en todo el mundo y afectan a cientos de millones de personas», asegura la coordinadora del encuentro, la Dra. Paula Matesanz, vicepresidenta de SEPA, quien admite que «centrarnos en la prevención y promoción de la salud periodontal a nivel poblacional permite reducir la carga de esta enfermedad, mejorar la equidad en salud bucal y promover la salud pública en general». Y para alcanzar este ambicioso objetivo se cuenta actualmente con recursos eficaces, seguros y aún no suficientemente utilizados.
Los antisépticos bucales (generalmente colutorios o enjuagues antimicrobianos) pueden desempeñar un papel clave en la prevención

Los expertos que participaron en la reunión celebrada en la Casa de las Encías de SEPA. Imagen: cedida por SEPA.
de las enfermedades periodontales y su recurrencia, dada su capacidad para reducir la formación de biofilm dental. Dependiendo de los principios activos que incluyan, según revela el análisis de la literatura científica, pueden ayudar a reducir la carga bacteriana, funcionar como complemento en las prácticas diarias de higiene bucal, ayudar a reducir los índices de placa e inflamación o, incluso, incorporarse como recursos adicionales en programas de mantenimiento periodontal, ayudando a preservar la salud y el soporte periodontal, así como colaborando en el éxito a largo plazo del tratamiento periodontal.
De ahí la necesidad de acercar las guías de práctica clínica, desarrolladas por la Federación Europea de Periodoncia, y adaptadas por SEPA para su uso en España, a los profesionales de la salud bucal, a médicos y farmacéuticos, a pacientes y a la población general.
La Guía de Práctica Clínica para el tratamiento de la periodontitis en estadio I-III, y las conclusiones del XI Workshop de Periodoncia de la Federación Europea de Periodoncia proporcionan recomendaciones e indicaciones
144 NOTICIAS DE ACTUALIDAD
Gaceta Dental · N o 366 | Mayo 2024



































para la utilización de estos recursos. Sin embargo, estas recomendaciones, a veces, resultan complejas para el equipo de salud bucodental, pudiendo limitar su empleo.
La información científica que respalda el impacto de algunos enjuagues bucales y dentífricos con formulaciones antisépticas está disponible desde hace décadas, y es parte de la formación de un graduado en Odontología. Sin embargo, según afirma el Dr. David Herrera, patrono de la Fundación SEPA y codirector del Grupo de Investigación de Etiología y Terapéutica de Enfermedades Periodontales (ETEP) de la Universidad Complutense de Madrid (UCM), «como ocurre frecuentemente con la información científica, esta se mezcla fácilmente con otras fuentes de información menos fiables, induciendo confusión entre los profesionales de la salud bucal».
PREVENCIÓN PRIMARIA Y SECUNDARIA
Algunos enjuagues bucales antimicrobianos han demostrado su eficacia en el control de la biopelícula dental y la inflamación gingival en muchos estudios, incluidos numerosos ensayos clínicos aleatorios. Sin embargo, resulta clave conocer su impacto en la prevención primaria de las enfermedades periodontales (para evitar su aparición) y en la prevención secundaria (reduciendo el riesgo de recidiva tras tratamiento de la periodontitis).
Un aspecto crucial discutido por los asistentes a esta Cumbre es la necesidad de enfocar la atención sobre la prevención de la periodontitis y, por lo tanto, tratar adecuadamente la gingivitis. Tal y como resume el Dr. Iain Chapple, «es hora de cambiar el paradigma: debemos controlar la gingivitis y no esperar hasta que se desarrolle la periodontitis».
Múltiples factores económicos y de salud invitan a implementar este cambio. Se ha determinado que eliminar la gingivitis, evitando así la progresión a periodontitis, ahorraría costes considerables durante un período de 10 años en comparación con «hacer lo de siempre» (por ejemplo, unos 36.000 millones de euros en Italia, unos 7.800 millones de euros en Países Bajos), y el retorno de la inversión es
enorme (desde los 15.200 millones de euros en Italia hasta los 57.500 en Alemania). Además, recientes investigaciones revelan que la periodontitis tiene efectos sistémicos en la salud.
Los expertos reunidos en este foro también pusieron en común las posibilidades de los antisépticos en pacientes sujetos a cuidados periodontales de apoyo. « Uno de los principales componentes de esta prevención es el control del biofilm supragingival, basado fundamentalmente en el control mecánico (cepillado de dientes interdental…)», señala el Dr. David Herrera, quien apunta que « para aquellos pacientes con más del 10% de sitios de sangrado, se pueden considerar medidas adicionales, incluido el uso de antisépticos».
IMPACTO AL ALZA
El impacto socioeconómico actual de la periodontitis es enorme y su prevalencia e incidencia se relacionan fuertemente con las desigualdades en salud. «Los más desfavorecidos son los más expuestos: un bajo nivel educativo se asocia con un 86% más de riesgo de periodontitis», informa el Dr. Chapple. Esto se destacó en el 2021 White Paper by the Economist Impact «Time to take gum disease seriously», donde se ponía de relieve cómo el cuidado periodontal era simplemente inasequible para muchas personas, y se identificaban importantes problemas de acceso a los recursos básicos de salud bucodental.
Hay 4 millones de profesionales de la salud bucal en todo el mundo, de los cuales unos 2,5 millones son dentistas: alrededor del 80% de estos trabajan en países de ingresos altos o medianos altos, mientras que sólo el 1,4% ejerce en países de bajos ingresos. ●
¡MAS DETALLES
DEL
ENCUENTRO EN NUESTRA WEB!
146 NOTICIAS DE ACTUALIDAD
Gaceta Dental · N o 366 | Mayo 2024









VISIBLE PARA EL DENTISTA –
INVISIBLE PARA EL PACIENTE
• Es fluorescente bajo luz ultravioleta A! Muy buena visibilidad de excesos y los límites de la reconstrucción, también en el área subgingival profunda
• Estética! Color de dentina
• De curado dual! También para el uso en el conducto radicular para pegar postes radiculares (p.ej. Rebilda Post)
• Manipulación simple! Tallable como dentina, adaptación perfecta (fluido)







Rebilda® DC fluorescent NUEVO VOCO GmbH · Anton-Flettner-Straße 1-3 · 27472 Cuxhaven · Alemania · Línea gratuita 00800 44 444 555 · www.voco.dental
ASISTIERON MÁS DE 250 PERSONAS
La atención odontológica integrada del niño, eje del XIII Congreso de la SEOII

Jornada inaugural del XIII Congreso Nacional de la SEOII. Imagen: cedida por la SEOII.
Del 14 al 16 de marzo, León acogió el XIII Congreso Nacional de la Sociedad Española de Odontología Infantil Integrada (SEOII), un evento que contó con más de 250 asistentes y que incluyó un programa científico con más de 25 ponencias, comunicaciones científicas y mesas redondas del más alto nivel.
La inauguración del congreso corrió a cargo del Dr. Jorge Luis Castillo, con su conferencia titulada «Importancia del niño como ser humano en el manejo de la caries. Directrices de la IAPD», quien fue presentado por la presidenta de la SEOII, la Dra. Virginia Franco. También intervinieron en el acto de inauguración José Antonio Díez, alcalde de León, y José Sevilla, en representación del Colegio de Odontólogos de León.
El congreso contó con odontólogos y
estomatólogos de la SEOII y de profesionales implicados en las diferentes disciplinas de la atención infantil, así como de estudiantes de postgrado y de últimos cursos del grado de Odontología.
PONENTES Y TEMAS DE ALTO NIVEL
Entre los ponentes, de carácter nacional e internacional, destacaron los doctores Borja Zabalegui, Jenny Abanto, Rocío Lazo, Juan Carlos Rivero, Romina Vignolo, Jesús María Martínez, Yolanda Martínez Beneito, Paula Zabalegui, Antonio Ortiz o José Ramón Ubieto.
«Uno de los temas que fue evaluado durante el congreso, además de las diferentes disciplinas de la atención odontológica integrada del niño, fue el de la situación de los niños en el siglo XXI con las conferencias magistrales del excelente psicólogo clínico, José Ramón Ubieto, y del mediático juez de menores, Emilio Calatayud», destacan desde la SEOII.
Asimismo, durante el congreso se expusieron las últimas novedades científicas en el área de Odontología infantil mínimamente invasiva y se desarrolló una jornada de Ortopedia infantil en pacientes en crecimiento con un enfoque multidisciplinar, transdisciplinar e interdisciplinar.
Por otra parte, la cita contó con una zona de exposición comercial en la que estuvieron presentes las principales compañías del sector odontológico donde los congresistas pudieron disfrutar y conocer las últimas tendencias de la industria en el campo concreto de la Odontología infantil.
PRÓXIMA EDICIÓN, EN MURCIA
La próxima edición del Congrso de la SEOII se celebrará en Murcia en el mes de marzo del próximo año bajo la presidencia del Dr. Antonio Ortiz y su equipo de la Universidad de Murcia. ●
148 NOTICIAS DE ACTUALIDAD
Gaceta Dental · N o 366 | Mayo 2024
Pecket Academy es el único sistema de gestión integral de cursos dirigido a centros de formación y colectivos profesionales.
Es un producto robusto, sencillo, llave en mano, y preparado para funcionar desde el primer momento. Una herramienta que se adapta a cualquier necesidad.
Permite gestionar y comercializar acciones formativas (cursos, formaciones, jornadas, presentaciones, coloquios, etc.)
Descripción del curso, establecimiento de precio y condiciones especiales. Establecimiento de límite de alumnos.
Experiencia de cliente y desarrollo de soluciones a medida: nuestra última razón de ser.
Síguenos en RRSS:
Creación ilimitada de acciones formativas. Selección de fecha de inicio y fin de curso.
Permite gestionar informes estadísticos en tiempo real. Control de Asistencia.
pecket.es
SE CELEBRÓ A MEDIADOS DE MARZO
EN NUEVA ORLEANS
El Dr. Josep Arnabat, premiado en la 102ª Reunión de la IADR


El Prof. Josep Arnabat -dcha.- en la recogida del Premio junto con los profesores Georgios Romanos y Kinga Grzech Lesniak (que recogieron los premios en representación de los premiados Prof. Akira Aoki y Prof. Anton Sculean). Imagen cedida por IADR.
Durante esta gran cita científica, celebrada a mediados de marzo en Nueva Orleans, se dieron cita más de 4.000 profesionales de más de 85 países.
En la ‘102o General Session & Exhibition’ de la IADR (International Association for Dental, Oral, and Craniofacial Research) se presentaron más de 400 presentaciones orales y 2.000 pósteres, se celebraron más de 85 simposios y se congregaron 35 grupos científicos.
Y es que, en esta reunión anual se presenta la investigación más actualizada de los diferentes campos de la Odontología, siendo el punto de reunión de los mejores grupos de investigación de todo el mundo. Entre ellos, uno de reciente creación: el de Láser y Biofotónica en Odontología, el cual presentó una sesión científica sobre la evidencia del tratamiento de la periimplantitis con el láser, con tres ponencias: «Impacto de la irradiación del láser en las superficies de los implantes en estudios in vitro», por el Prof. Josep Arnabat de la Universidad de Barcelona; «El nivel de evidencia en la irradiación láser en periimplantitis en estudios en animales», por el Prof. George Romanos de la Universidad de Stony Brook (USA); y «El nivel de evidencia en estudios humanos en los tratamientos de periimplantitis con láser», por la Profa. Kinga Grzech Lesniak de la Universidad de Wroclaw (Polonia).
Además, en la asamblea anual del Lasers & Bio-photonics Scientific Group IADR se entregaron los premios anuales del grupo, siendo el Prof. Josep Arnabat premiado con el IADR Lasers & Bio-photonics Scientific Group Excellence in Mentoring Award 20232024. Precisamente, la asamblea nominó como presidente electo de este grupo al Prof. Josep Arnabat Domínguez. ●
PRÓXIMA PARADA: BCN
La próxima edición de la General Session & Exhibition de la IADR, conjuntamente con la IADR/PAN Europea Regional Congress, se celebrará en 2025, del 25 al 28 de junio, en Barcelona.
150 NOTICIAS DE ACTUALIDAD
Foto del grupo de Lasers & Bio-photonics Scientific Group IADR durante su asamblea anual. Imagen cedida por IADR.
Gaceta Dental · N o 366 | Mayo 2024
Adriana Sanz repite como presidenta de los dentistas de Pontevedra y Ourense
Revalida su mandato como presidenta del Colegio de Dentistas de Pontevedra y Ourense, tras un proceso electoral marcado por el consenso en torno a su candidatura.
La Dra. Sanz reafirma así «su compromiso y el de su Junta Colegial con la defensa de los intereses de la profesión». Es de destacar la continuidad de la práctica totalidad de los integrantes de la anterior Junta y la incorporación de tres nuevos miembros. Con este capital humano, afronta con ilusión este nuevo reto, en el que como la doctora indica, «continuará velando por la mejor gestión posible de los servicios colegiales».
Acompañan a la Dra. Sanz en la junta, José Ramón García Iglesias (vicepresidente); Manuel Peña Rubio (secretario); Andrés Domínguez Artime (tesorero) y Constantino Lagarón Sanjurjo, Santiago González de la Ballina González, Lara Mosquera Álvarez, Roberto Rodríguez-Ozores Sánchez, Ana Beatriz González Allo, Eduardo Capilla, Rosa Iturbe y Santiago Mareque Bueno como vocales.

La Dra. Adriana Sanz afronta con ilusión su nuevo mandato al frente de la organización colegial gallega. Foto: CDOP.
Por otro lado, la Junta Provincial de Ourense está formada por: Raquel Piñón Fernández, como presidenta; Nieves Bravo Antón como secretaria/tesorera, y Mercedes Outomuro Rial, Marisol Suárez González, Alicia Ardanuy Pizarro, Beatriz Fernández González y María Fátima Bastos Amorín como vocales. ●





Sevilla 2024
53o Congreso Anual S EPES
10 - 12 de octubre
EPA-DDS Joint Meeting
Protocolos para la práctica clínica


151 NOTICIAS DE ACTUALIDAD
Consulta aquí el programa y las tarifas de inscripción
JUNIO con TARIFA REDUCIDA
Aprovecha las PROMOS para ir con tu equipo y amigos al congreso
Inscríbete hasta el 30 DE
EELCO VAN WORT, PROTÉSICO Y USUARIO DE VITA
«VITA nos ayuda a confeccionar prótesis completas funcionales»

Desde hace 13 años, el protésico dental Eelco van Wort es, junto con su hermano Martijn van Wort, propietario del centro de fresado Dental Design Centrum (Países Bajos) y se está formando como denturista. En esta entrevista nos cuenta su experiencia con el disco de composite Vionic Dent Disc multiColor de VITA.
—¿A qué motivos obedece la creciente implantación de la prótesis completa digital en los Países Bajos?
—Desde nuestro centro de fresado ofrecemos un servicio protésico. Hemos observado que cada vez más odontólogos pueden diseñar sus propias prótesis completas en el software CAD, pero no están equipados para confeccionarlas con asistencia CAD/CAM. Y es ahí donde entramos en escena. Naturalmente, también la falta de personal especializado es una causa determinante del auge de la prótesis completa digital. Gracias a la automatización, el equipo de fresado puede trabajar de manera autónoma
también durante la noche. Se han producido grandes avances en términos de calidad, de modo que decidimos que nuestros clientes debían beneficiarse de ello.
—¿Qué diferencias clave, quizás también ventajas e inconvenientes, identifica entre la confección análoga y la digital de prótesis completas removibles?
—En mi opinión, de hecho, el factor tiempo no es tan decisivo. Es posible que alguien con mucha experiencia en prótesis completas pueda -si se apresura- ser incluso un poco más rápido que el flujo de trabajo digital. Pero, si esa persona ha pasado, por ejemplo, un mal fin de semana, es posible que el resultado el lunes por la mañana no sea tan satisfactorio como de costumbre. En el flujo de trabajo digital, la calidad será siempre idéntica y constante. Dos milímetros son siempre dos milímetros, y los montajes son siempre reproducibles. Este es, a mi juicio, el factor decisivo que me llevó a confeccionar prótesis completas en el flujo de trabajo digital.
—¿Quiénes son sus clientes y cómo han acogido las prótesis completas digitales?
¿Existen diferencias de precio entre la confección analógica y la digital?
—Por regla general, no confeccionamos prótesis analógicas. Nos hemos centrado en la confección de prótesis completas digitales con VITA Vionic Vigo. Después, ya solo tenemos que adherir en la base mediante VITA Vionic Bond los dientes prémium listos para usar. Esto nos permite ofrecer una mejor calidad que otros centros de fresado que, por ejemplo, fresan los dientes a partir de PMMA sin relleno. Nuestros clientes son, principalmente, denturistas que no tienen la capacidad de confeccionar con asistencia CAD/CAM. Así que, cuando sea
152 Gaceta Dental · N o 366 | Mayo 2024
ENTREVISTA DE EMPRESA
El protésico dental Eelco van Wort. Imagen: cedida por VITA.
denturista, me convertiré en mi propio cliente; entonces, confeccionaré mis propias prótesis completas.
—¿Existe diferencia de precio entre la prótesis completa analógica y la digital y, de ser así, cuál es dicha diferencia?
—Hace unos seis años, cuando empezamos a confeccionar prótesis completas con asistencia CAD/CAM, los materiales eran aún algo costosos en comparación con la confección analógica. Sin embargo, hemos observado que los precios de los materiales para la prótesis completa digital han ido bajando con el tiempo, de modo que se ha ido haciendo cada vez más atractiva en términos económicos. Probablemente, el encerado clásico sigue siendo un poco más económico en lo que al material se refiere, pero en la mayoría de los casos requiere una inversión de tiempo considerablemente mayor. En definitiva, la prótesis completa digital es comparable hoy en día a la prótesis completa analógica por lo que respecta al precio.
—¿Qué experiencias ha tenido hasta ahora con el disco de composite Vionic Dent Disc multiColor? ¿Para qué restauraciones removibles fresa sus propios dientes a partir de este material?
—El VITA Vionic Dent Disc multiColor ha cubierto una laguna en nuestra cartera. El disco de composite constituye una verdadera ventaja, sobre todo cuando falta espacio. En caso de altura de mordida vertical muy reducida, el material nos proporciona la flexibilidad funcional que necesitamos. Lo utilizaremos también para prótesis inmediatas. Ofrece calidad de gama alta en la confección sustractiva de material dental, ya que la fórmula del composite es la misma que la de todos los demás dientes prémium de VITA. Así pues, se parte de una calidad mejor que la de los discos de PMMA sin relleno convencionales. Por eso estoy encantado de que exista el VITA Vionic Dent Disc multiColor.
—¿Qué opinión le merece el desarrollo de la confección aditiva en la prótesis completa
«En el futuro se generalizará la digitalización y ésta se impondrá en la confección técnica de prótesis dentales»
removible? ¿Tiene previsto trabajar con esta tecnología?
—La impresión 3D es, sin duda, el futuro de la prótesis dental completa. Incluso como centro de fresado, no podemos cerrar los ojos ante ella. Es más barata y, probablemente, también más rápida. Hoy en día ya es fácil imprimir una base de prótesis monocroma. De momento no puede utilizarse para crear dientes robustos con transición cromática y translucidez en los lugares adecuados. La sostenibilidad es, actualmente, un tema prioritario también en la Odontología y la prostodoncia. En la confección aditiva se utiliza solo la cantidad de material realmente necesaria. Esto es mucho mejor para el medio ambiente que fresar a partir de un disco y desechar los restos.
—En su opinión, ¿cómo se transformará en el futuro la tecnología y, por ende, el perfil profesional del protésico dental y del denturista?
—Creo que en el futuro se generalizará la digitalización. Los materiales serán cada vez mejores y los procesos cada vez más rápidos y constantes. En cualquier caso, la digitalización se impondrá en la confección técnica de prótesis dentales. Ya hoy en día, VITA Vionic Vigo y VITA Vionic Dent Disc multiColor nos ayudan a confeccionar prótesis completas funcionales y estéticas en el flujo de trabajo digital, para devolverles sus dientes a los pacientes y hacerlos felices. Ahora bien, tanto los denturistas como los odontólogos deberían tener siempre presente que el tratamiento de pacientes aún deberá ser y continuará siendo analógico durante mucho tiempo. ●
153 Gaceta Dental · N o 366 | Mayo 2024
ENTREVISTA DE EMPRESA

Dependiendo del caso, se utilizan los dientes preconfeccionados VITA Vionic Vigo o el disco VITA VIONIC® DENT DISC multiColor.

El diente preconfeccionado para la prótesis digital, VITA VIONIC VIGO®, durante el control del ajuste.

La aplicación circular de VITA VIONIC® BOND por basal en el diente preconfeccionado VITA Vionic Vigo.

La base de prótesis confeccionada de forma sustractiva a partir de VITA Vionic Base Disc HI.


El diente preconfeccionado preacondicionado y morfológicamente optimizado VITA VIONIC VIGO® sale del envase listo para su uso.

El adhesivo VITA Vionic Bond se aplica en los alveolos de la base de la prótesis.

El diente 21 tras su colocación con ajuste preciso en la base de la prótesis.

La arcada dentaria correspondiente a partir del VITA VIONIC® DENT DISC multiColor.

El composite prémium policromo tras el acabado y el pulido. La arcada dentaria y la base encajan entre sí con precisión conforme al principio de llave-cerradura.

La prótesis terminada a partir de VITA VIONIC® BASE DISC HI y VITA VIONIC® DENT DISC multiColor.
154 Gaceta Dental · N o 366 | Mayo 2024 ENTREVISTA DE EMPRESA
RECONOCIMIENTO A LA EXCELENCIA EN ODONTOLOGÍA
La Real Fábrica de Tapices, escenario de los 27 Premios Gaceta Dental
Los Premios Gaceta Dental celebran su veintisiete aniversario y una fecha tan señalada para la Odontología merece una ceremonia muy especial con sorpresas e importantes novedades.
Una de ellas es la elección de un nuevo emplazamiento para la entrega de estos galardones: la Real Fábrica de Tapices de Madrid, un edificio lleno de historia situado en un entorno inolvidable para disfrutar, el día 19 de septiembre, de una velada perfecta con compañeros del sector.
Profesionales; estudiantes; representantes de las principales instituciones, universidades y sociedades científicas del sector; además de empresas destacadas en el campo de la Odontología; todo ellos se reunirán en la gala de la 27a edición de los Premios Gaceta Dental, unos galardones que reconocen la excelencia dentro de la Odontología española.
¿QUIERES
ACOMPAÑARNOS EN ESTE DÍA TAN SEÑALADO?
¡PARTICIPA!
Si quieres ser uno de los protagonistas de la próxima edición y hacerte con uno de los galardones, no esperes más y envía tu candidatura a redaccion@gacetadental.com antes del 30 de junio e infórmate de todas las novedades en nuestra web y canales digitales.
LOS PREMIOS, DIVIDIDOS EN CUATRO BLOQUES
Trabajos profesionales, proyectos empresariales, iniciativas de voluntariado de organizaciones solidarias, trabajos de fin de curso… seguro que tu perfil encaja en alguna de estas categorías:

-Premios GD para profesionales: Mejor Artículo Científico y Mejor Caso Clínico.
-Premios GD para estudiantes: Mejor Talento en Odontología, Mejor Talento en Prótesis Dental y Mejor Talento en Higiene Dental.
-Premios GD a la innovación y gestión: Mejor Clínica o Laboratorio Digital, Mejor Avance Tecnológico, Mejor Gestión Clínica y Mejor Trabajo en Comunicación y Marketing.
-Premios GD sociedad y cultura: Proyecto Solidario, Mejor Relato Corto y Mejor Libro del Año ●
CONSULTA LAS BASES AQUÍ
155 NOTICIAS DE ACTUALIDAD
Uno de los espacios de la Real Fábrica de Tapices. Imagen: cedida por la Real Fábrica de Tapices.
Gaceta Dental · N o 366 | Mayo 2024
Éxito de asistencia al Symposium de SCOI-UIC:
Gestión en
la clínica dental
Se celebró el pasado 13 de abril, con más de un centenar de participantes.
El Dr. Lluís Giner, presidente de la Conferencia de Decanos de las Facultades de Odontología de España, y la Dra. Marta Satorres, vicedecana de Investigación Facultad de Odontología de la UIC, fueron los encargados de dar el discurso de inauguración del simposio.
La jornada contó con la participación de destacados profesionales del sector, los cuales abordaron una gran variedad de temas como «El control de calidad y la importancia de recoger datos en la consulta», por parte de Pedro Ahumada; «La implementación de la metodología LEAN», con Patricia Zubeldia; y «La planificación de la cadena de valores», con Leticia Rodríguez.
Después de un descanso, continuaron las ponencias con los consejos de Rosa María Ros sobre «Cómo aprender de las quejas de los pacientes y también de nuestro propio equipo de trabajo»; Juan José Guarro habló sobre «La necesidad de poder disponer de métodos efectivos de financiación», siendo Naroa Lozano con «Las claves del marketing dental» quien puso punto final a la jornada.
Una buena representación de la Junta de la Sociedad Científica de Odontología Implantológica (SCOI) y de la Junta de Facultad de Odontología de la UIC Barcelona estuvieron presentes y disfrutaron de una jornada muy instructiva. Por último, destacar que el evento contó con el patrocinio de Klockner, Nobel Biocare y Megagen.●
Rechazo de los dentistas al traspaso de homologación de títulos al País Vasco
El Consejo de Ministros del pasado 9 de abril aprobó la transferencia al País Vasco de las competencias en materia de homologación de títulos universitarios, entre los que se incluye el título de dentista.
Desde el Consejo General de Dentistas señalan que «la competencia para la homologación de títulos, tal y como se establece en la Constitución y en el Real Decreto 889/2022, de 18 de octubre, es del Estado, con la preceptiva participación de los Consejos Generales, a través de la emisión de informes a las solicitudes de homologación de títulos extranjeros. Por tanto, además de la posible
falta de competencia autonómica, el traspaso al País Vasco de esta competencia supondría un incumplimiento de este reconocimiento expreso a los Consejos Generales ». En este sentido, el Consejo considera que «esta decisión, sin precedentes en la Unión Europea, va en contra del principio de equidad. Y es que el hecho de que una comunidad autónoma disponga de un sistema propio de homologación de títulos puede suponer diferencias que provoquen graves desigualdades en la obtención de la homologación». Por ello, el Consejo quiere mostrar «su total rechazo a que competencias estatales que afecten a asuntos de gran complejidad, como es el caso de las homologaciones de títulos, se utilicen como moneda de cambio por parte de nuestros gobernantes » ●
156 NOTICIAS DE ACTUALIDAD
Gaceta Dental · N o 366 | Mayo 2024
SU USO ESTÁ INDICADO EN CASOS MODERADOS Y SEVEROS
Kiyomi Dental presenta su nuevo blanqueamiento dental K-Bleach 16%

Este blanqueamiento tiene en su fórmula pH neutro para disminuir la probabilidad de hipersensibilidad dental.
La empresa española Kiyomi Dental, dedicada al desarrollo de productos innovadores y de alta calidad para la Odontología estética y restauradora, ha incluido recientemente en su porfolio de productos K-Bleach 16%, un blanqueamiento dental a base de peróxido de carbamida para el tratamiento en casa bajo la supervisión de un odontólogo.
Este blanqueamiento tiene en su fórmula pH neutro para disminuir la probabilidad de hipersensibilidad dental, por lo que se recomienda su aplicación en casos moderados y severos, ya que ofrecen grandes resultados. Cuenta con una jeringa de gran capacidad, 3 ml
de gel de alta viscosidad, que no escurre de la férula. Su punta es de fácil manipulación para el transporte del gel a la cubeta y su tapón de cierre permite el almacenamiento sin pérdidas.
«Con gran variedad de usos en Odontología estética, K-Bleach 16% de Kiyomi es, sin duda, el mejor aliado para prolongar los efectos blanqueadores por más tiempo», cuentan desde la marca, a la vez que añaden: «Nos enorgullece ofrecer a los odontólogos opciones simples y eficaces que les permitan lograr resultados estéticos y funcionales excepcionalmente predecibles sin importar su nivel de formación. Nuestro lema es «Simple and Easy», porque creemos que la Odontología estética debería ser fácil y accesible para todos».
Por este motivo, destacan, «en Kiyomi Dental trabajamos incansablemente para desarrollar productos de alta calidad que estén respaldados por la ciencia y que sean probados rigurosamente para garantizar su eficacia. Contamos con líderes de opinión para ayudarnos a crear productos que sean verdaderamente útiles para los profesionales del sector» ●
MÁS INFORMACIÓN
157
Gaceta Dental · N o 366 | Mayo 2024 NOTICIA DE EMPRESA
SUCEDE EN EL CARGO AL DR. DARKO BOZIC
El profesor Moritz Kebschull, nuevo presidente de la EFP

El profesor Moritz Kebschull, catedrático de Odontología Restauradora en la Universidad de Birmingham y profesor adjunto en la Universidad de Columbia, sucederá en el cargo al Dr. Darko Bozic, de la Universidad de Zagreb (Croacia).
El profesor Kebschull ha formado parte de las juntas directivas de las sociedades nacionales británica y alemana de Periodoncia, además de ser miembro del Comité Ejecutivo de la Federación Europea de Periodoncia (EFP) durante los últimos tres años, lo que le ha permitido impulsar el desarrollo de guías de práctica clínica basadas en la evidencia científica para el tratamiento de enfermedades de las encías en Europa y, especialmente, en Reino Unido y Alemania. En concreto, una de las principales investigaciones del profesor Kebschull se basa en la exploración de los vínculos entre las características clínicas y las bases moleculares de las enfermedades periodontales y periimplantarias, y otras enfermedades sistémicas.
EXPANDIR EL LIDERAZGO DE LA EFP, EL PRINCIPAL OBJETIVO
Como nuevo presidente de la EFP, el profesor Kebschull se plantea, entre sus principales objetivos, «ampliar el impacto global de la EFP como la federación periodontal más grande del mundo, expandiendo su liderazgo en el desarrollo de pautas en el campo de la Odontología, abriendo caminos para la educación clínica en Periodoncia y promoviendo la ciencia periodontal».
«La EFP está a la vanguardia del desarrollo de guías de práctica clínica basadas en la evidencia odontológica a nivel mundial, las cuales han demostrado tener un impacto real y medible en pacientes y profesionales. De esta manera, el Prof. Kebschull y el equipo de la EFP trabajarán para incluir nuevas pautas que cubran todo el campo de la Periodoncia, con el objetivo de implementarlas entre todas sus sociedades nacionales y aumentar, de esta forma, el impacto entre los pacientes», destacan desde la EFP.
Para que estas directrices puedan llevarse a cabo, desde la EFP señalan que, «además de contar con un plan de estudios de pregrado fortalecido y prestigiosos programas especializados, es necesario disponer de una plantilla cualificada de profesionales que puedan tratar a un número significativo de pacientes con enfermedades periodontales».
Por este motivo, el Prof. Kebschull detalla que «para impulsar aún más el impacto clínico, la promoción de la investigación de alta calidad es una necesidad absoluta».
En este sentido, propone «fomentar la movilidad internacional de jóvenes investigadores en Periodoncia de todos los países miembros de la EFP, con el fin de mejorar la colaboración y las interacciones». ●
158 NOTICIAS DE ACTUALIDAD
Gaceta Dental · N o 366 | Mayo 2024
Durante los tres últimos años, Moritz Kebschull ha formado parte del Comité Ejecutivo de la EFP. Imagen: cedida por la EFP.
CON ACCIONES EN TORNO A LA HIGIENE POSTURAL
Víttrea celebra la 2ª edición del mes de la ergonomía

Víttrea ofrecerá contenidos exclusivos en los que hablará de la importancia de la ergonomía.
Tras el éxito de la primera edición, Víttrea consolida el mes de mayo como el mes de la ergonomía, con acciones especiales que giran en torno a la higiene postural.
Ofrecerá contenidos exclusivos en los que hablará de la importancia de la ergonomía y de cómo influye positivamente en la salud de los profesionales de la Odontología y de la cirugía. «Víttrea es pionera en introducir la tecnología Ergo al mercado español, por lo que también celebrará el cuarto aniversario de las lupas Ergo con una oferta muy especial. El objetivo es el de acercar a odontólogos, cirujanos e higienistas una herramienta que evita la inclinación del cuello, liberándolo de tensiones; permite un posicionamiento adecuado de la columna vertebral; elimina dolores de espalda y trastornos musculoesqueléticos; y ofrece
«Nuestro compromiso con la innovación y la excelencia nos ha llevado a la vanguardia de la tecnología ergonómica.
Ofrecemos un servicio de asesoramiento especializado»
máxima ligereza para un confort incomparable durante el trabajo», cuentan desde Víttrea.
Una oportunidad única para probar las lupas Ergo sin compromiso y disfrutar de un descuento muy especial. Siempre con el asesoramiento personalizado y la posibilidad de realizar el estudio ergonómico digital más avanzado en la clínica.
«Nuestro compromiso con la innovación y la excelencia nos ha llevado a la vanguardia de la tecnología ergonómica. Y es que, ofrecemos soluciones personalizadas y un servicio de asesoramiento especializado para ayudarte a elegir las lupas Ergo que se adapten perfectamente a tus requisitos», destacan ●
159
MÁS INFORMACIÓN
NOTICIA DE EMPRESA Gaceta Dental · N o 366 | Mayo 2024
LA UNIVERSIDAD COMPLUTENSE DE MADRID, A LA CABEZA
La Odontología española, destacada en el QS World University Rankings
La vigésima edición del QS World University Rankings incluye más de 1.500 instituciones de más de 100 países. En el campo de la Odontología, entre los centros españoles más destacados figuran la Universidad Complutense de Madrid, la Universidad Internacional de Cataluña y la Universidad de Barcelona.
En la materia de Odontología la participación ha sido de 491 instituciones de todo el mundo, situando, en el Top 20, a la Universidad de Michigan Ann-Arbor en la primera posición como la mejor universidad del mundo en esta disciplina. Le siguen el Centro Académico de Odontología de Ámsterdam (Países Bajos), la Universidad de Hong Kong (China), la Universidad Médica y Dental de Tokio (Japón) y el King’s College de Londres (Reino Unido).
En el puesto número seis encontramos la Universidad de Berna (Suiza), seguida del Instituto Karolinska (Suiza), la Universidad de Zúrich (Suiza), la Universidad de California, San Francisco (Estados Unidos) y la Universidad de Harvard (Estados Unidos).
Siguiendo la tabla, en la posición número once se sitúa la Universidad de Gotemburgo (Suecia) y, a continuación, la Universidad de Sichuan (China), la Universidad de de São Paulo (Brasil), la Universidad Imam Abdulrahman Bin Faisal
(Arabia Saudita), la Universidad de California, Los Ángeles (Estados Unidos), la Universidad Queen Mary de Londres (Reino Unido) y la Universidad Ku de Lovaina (Bélgica).
En el puesto dieciocho (y 1 er puesto a nivel nacional) encontramos representación española con la Universidad Complutense de Madrid, a la que siguen la Universidad de Carolina del Norte en Chapel Hill (Estados Unidos) y la Universidad de Pennsylvania (Estados Unidos).
Asimismo, la Universidad Internacional de Cataluña sube puestos ocupando la posición 46 a de las 100 universidades clasificadas a escala mundial y, a escala nacional, la 2a posición, seguida de la Universidad de Barcelona, que se encuentra entre los puestos 51-100 a nivel mundial.
¿QUÉ SE TIENE EN CUENTA EN EL RANKING
QS WORLD UNIVERSITY?
Las clasificaciones del QS World University Rankings se basan en una metodología que evalúa diversos factores, como la reputación académica, la valoración por parte de empleadores, el impacto de la investigación y el alcance internacional.
Para esta nueva edición, se han incluido tres nuevas métricas: sostenibilidad, resultados de empleo y red internacional de investigación. Cada año se revisa la metodología para garantizar que siga siendo relevante y esté actualizada. ●
160 NOTICIAS DE ACTUALIDAD
SI
LO QUE ACONTECE... ¡MÁS
DEL
EN
Gaceta Dental · N o 366 | Mayo 2024
QUIERES ESTAR AL DÍA DE TODO
NOTICIAS
SECTOR
NUESTRA WEB!
DR. PERI COLINO, DICTANTE DEL «EXPERIENCE DE ORTODONCIA» DE OSTEÓGENOS
Aprendizaje interactivo y participativo en el «Experience» de Osteógenos

Con el objetivo de enseñar a los profesionales las técnicas más avanzadas en Ortodoncia, Osteógenos presenta su «Experience de Ortodoncia Avanzada», impartido por el Dr. Peri Colino, que tendrá lugar en Madrid en distintos módulos durante mayo-junio, septiembre y noviembre.
—¿Cómo se adapta el curso a las necesidades y desafíos específicos que enfrentan los ortodoncistas en la práctica clínica diaria?
—Esta experiencia busca esclarecer de manera directa el funcionamiento de una clínica de Ortodoncia moderna, mostrando todas las herramientas que nos facilitan el día a día y nos permiten centrarnos en lo verdaderamente importante: el diagnóstico y la planificación terapéutica de nuestros pacientes.
—¿Cuál es el nivel de interactividad y participación que los alumnos pueden esperar durante el curso?
—Será muy alto. Cuando decidimos comenzar este proyecto pensamos a lo grande, en una formación única en Ortodoncia avanzada,
biomecánica y anclaje esquelético, con una forma de aprendizaje interactiva y participativa.
—¿Cuál es el perfil ideal de los profesionales que se beneficiarían más de este curso?
—El perfil ideal es un profesional con experiencia en Ortodoncia o que quiera digitalizar su consulta, ya que todas las herramientas con las que trabajamos tienen menos de 2 años de antigüedad.
—¿Qué tecnologías o técnicas innovadoras se incluyen en el programa y cómo pueden ayudar a mejorar los resultados clínicos?
—En primer lugar, y quizás lo más disruptivo, es la Cefalometría 3D, ya que hay poquísimas formaciones en España que enseñan este tipo de diagnóstico integral y completo que facilita la planificación terapéutica.
Los alumnos también conocerán en profundidad la planificación con alineadores, sin centrarnos en ninguna casa comercial, ya que trabajamos con todas las grandes marcas del mercado y conocemos todos sus softwares. Muchos ortodoncistas con experiencia buscan, más que una formación que ayude a diagnosticar y tratar, una experiencia que ayude a mejorar el funcionamiento de su clínica, y es en ello en lo que precisamente profundizaremos, mostrando las mejores herramientas para conseguir eficiencia en el día a día. ●
161
NOTICIA DE EMPRESA Gaceta Dental · N o 366 | Mayo 2024
El Dr. Peri Colino, dictante del «Experience de Ortodoncia Avanzada».
MÁS INFORMACIÓN
El Colegio de Odontólogos y Estomatólogos de la 1ª Región (COEM) y su Fundación (FCOEM) han celebrado la duodécima edición de la Campaña de la Salud Bucodental y Hábitos Saludables – Semana de la Salud Oral, bajo el lema «Cuidando tus dientes ¡tu salud proteges!».
Un año más, la campaña ha contado con el respaldo de las cinco universidades que imparten en la Comunidad de Madrid el Grado de Odontología: Universidad Alfonso X El Sabio, Universidad Complutense de Madrid, Universidad Europea, Universidad Rey Juan Carlos y CEU
El COEM y su Fundación celebran la Semana de la Salud Oral SECIB imparte un monográfico de actualización en Implantología oral
El Museo Picasso de Málaga acogió el monográfico «Actualización en Implantología oral», organizado por la Sociedad Española de Cirugía Bucal en colaboración con BTI Biotechnology Institute. Los Dres. José María Delgado, Gustavo Cabello, Asier Eguía y Eduardo Anitua fueron los ponentes de esta cita científica.
La jornada comenzó con la intervención del Dr. José María Delgado, que habló sobre las nuevas tecnologías para el tratamiento y mantenimiento de las enfermedades periimplantarias. A continuación, el Dr. Gustavo Cabello abordó el tema «Implantes inmediatos con protocolo

San Pablo. También han participado la Consejería de Sanidad de la Comunidad de Madrid, el Grupo HM, el Grupo Educativo Gredos San Diego (GSD), el Ayuntamiento de Villanueva de la Cañada y los colegios profesionales sanitarios pertenecientes a Unión Interprofesional de la Comunidad de Madrid (UICM). Durante la campaña se han llevado a cabo talleres para un correcto cepillado dental, charlas sobre higiene oral en los centros educativos, actividades con pacientes de las clínicas, residencias y en centros de Atención Primaria. ●
Trimodal approach: variaciones tisulares en función del abordaje quirúrgico». Tras un pequeño descanso, el Dr. Asier Eguía realizó una exposición sobre cirugía guiada. Cerró el turno de ponencias el Dr. Eduardo Anitua, con una conferencia centrada en el tratamiento del maxilar mínimamente invasivo. Para terminar, se llevó a cabo una intensa mesa redonda, moderada por los Dres. Daniel Torres y Berta García, durante la cual se pudieron intercambiar comentarios y opiniones a lo largo de más de una hora.

162 NOTICIAS DE ACTUALIDAD
●
Alumnos de la Universidad Alfonso X el Sabio. Imagen: Instagram @dentistas.coem
Gaceta Dental · N o 366 | Mayo 2024
De izda. a dcha.; Asier Eguía, Berta García, José María Delgado, Daniel Torres, Gustavo Cabello y Eduardo Anitua. Imagen: cedida por SECIB.
NUEVO HITO EN EL ABORDAJE DE LA ORTODONCIA
Ortoplus y el Dr. Juan Carlos Pérez
Varela lanzan el nuevo Power Expander

Este dispositivo incorpora una nueva estructura sinterizada.
Ortoplus ha anunciado su colaboración con el Dr. Juan Carlos Pérez Varela para el lanzamiento del nuevo Power Expander. Este dispositivo, resultado de una investigación liderada por el Dr. Pérez Varela, marca un hito significativo en el abordaje de problemas transversales en Ortodoncia al proporcionar un anclaje esquelético y una expansión dental segura y altamente efectiva.
«Fundiendo años de experiencia en diseño y fabricación de aparatología ortodóntica mediante tecnología CAD/CAM con un firme compromiso con la investigación y desarrollo, Ortoplus ha desempeñado un papel importante en el desarrollo del nuevo Power Expander», destacan desde la compañía.
Este dispositivo incorpora una nueva estructura sinterizada, especialmente diseñada para alojar el cuerpo de un tornillo de disyunción PowerScrew, con una planificación precisa a través de la tomografía computarizada de haz cónico (CBCT). «Este enfoque de diseño altamente personalizado, respaldado por
la experiencia técnica del equipo digital de Ortoplus, posiciona al Power Expander como uno de los dispositivos de Expansión Rápida del Paladar Asistida por Microtornillos (MARPE) más avanzados y punteros en Ortodoncia», explican desde Ortoplus.
El Dr. Pérez Varela, reconocido internacionalmente en el campo de la Ortodoncia, ha desempeñado un papel fundamental en el desarrollo de técnicas y dispositivos que han transformado los resultados de los tratamientos ortodónticos. «El Power Expander es testimonio de su dedicación a la excelencia y al progreso continuo en este campo, concebido específicamente para abordar las necesidades de pacientes con insuficiencia de espacio en el maxilar o que requieren modificaciones en la estructura ósea del paladar para lograr una alineación dental óptima», cuentan desde Ortoplus.
Este dispositivo, dotado de un innovador mecanismo de acción, facilita una expansión más uniforme, minimizando las molestias para el paciente y garantizando resultados sobresalientes. «El enfoque del Power Expander en la expansión maxilar marca el comienzo de una nueva era en la Ortodoncia, ofreciendo una alternativa eficiente y controlada para corregir maloclusiones y mejorar la estética facial», concluyen. ●
MÁS INFORMACIÓN
163 NOTICIA DE EMPRESA
Gaceta Dental · N o 366 | Mayo 2024
Multi-Unit mini de Smart Implant Solutions
Kolinsky evo, nuevo pincel para cerámica
Productos

El nuevo pilar Multi-Unit mini ha sido diseñado para combatir la periimplantitis, mejorando el espacio biológico supracrestal. Entre sus características destaca su plataforma reducida de 3,8 mm. Su diseño estrecho mejora la cantidad de fibras de colágeno, aumentando la vascularización del sellado mucoso. Su geometría externa es convergente hacia la coronal, favoreciendo la migración de los miofibroblastos presentes en el tejido conectivo en esa dirección.
https://www.smartimplantsolutions.com/
Ceramir Pediatric Crowns de Directa Dental

Las Ceramir Pediatric Crowns son coronas preformadas para niños y establecen un nuevo estándar en Odontopediatría. La tecnología patentada de sinterización por láser utilizada crea una estructura homogénea similar al vidrio, lo que confiere al material una translucidez natural y un acabado de alto brillo. En concreto, las Ceramir Pediatric Crowns combinan la resistencia de la cerámica a base de disilicato de litio con la estética de la vitrocerámica feldespática.
www.directadental.com
Zirconio multicapa con faldón de encía rosa de Hexa3Dental

Hexa3Dental presenta una rehabilitación dental de zirconio estético multicapa, robusta y con un faldón de encía rosa de composite, todo ello sobre interfases de titanio. Una solución integral para una sonrisa natural, duradera y estéticamente impecable.
www.hexa3dental.com

Con Bionic Hair, Renfert anuncia un cambio de paradigma en el área de los pinceles para cerámica. Además de la versión de pelo natural, el pincel Kolinsky de eficacia probada ahora también está disponible con un nuevo pelo: Kolinsky evo. La finura, la elasticidad y la estabilidad dimensional de su punta garantizan estratificaciones precisas. Gracias a su gran resiliencia y rigidez recoge perfectamente hasta las cantidades más pequeñas de cerámica.
renfert.com/kolinsky-evo
Ortodoncia invisible de QuickSmile

QuickSmile cuenta con un avanzado software propio en el que el doctor tiene el control total de los casos, base de datos de los pacientes y todas las secuencias de los tratamientos. Además, permite visualizarlo en cualquier plataforma y emitir cambios necesarios. Asimismo, cuenta con el LaserGlass de máxima eficacia.
https://doctores.quicksmile.es/
Férula quirúrgica de nylon para cirugía ortognática

Ortoplus presenta su más reciente innovación: la primera férula quirúrgica de nylon diseñada específicamente para la cirugía ortognática. Esta férula pionera representa un avance significativo en la búsqueda de precisión y excelencia en el tratamiento de los pacientes. El nuevo material garantiza no solo la durabilidad y resistencia necesarias, sino también una adaptabilidad excepcional a la anatomía única de cada paciente.
www.ortoplus.es
164 Gaceta Dental · N o 366 | Mayo 2024 PRODUCTOS
Nuevas Ti-Bases de Smart Implant Solutions

Están fabricadas con varias alturas gingivales para adaptarse a las necesidades de cada paciente. Entre sus características destacan varias áreas cementables, área cónica para facilitar la inserción de puentes, 3 caras planas para evitar rotaciones y un ajuste perfecto mejorado. Además, están recubiertas con el revestimiento de superficie Biogold.
https://www.smartimplantsolutions.com/
BEGO presenta la resina VarseoSmile® TriniQ®

Este material polivalente se adapta a la perfección y de forma inteligente a los requisitos de la Odontología moderna y la tecnología dental y demuestra de forma eficiente cómo una sola resina puede cubrir una amplia gama de aplicaciones en la restauración dental. Este nuevo material híbrido con carga cerámica se puede utilizar para la impresión 3D de coronas individuales, inlays, onlays y carillas permanentes.
www.bego.com
Nuevo set de prostodoncia de Ticare

Entre los lanzamientos que Ticare presenta para 2024 se encuentra el nuevo set de prostodoncia, en el que se contempla toda la gama de prótesis, destornilladores organizados por categoría y una guía de torques. Entre las ventajas que se destacan de este set se encuentran la comodidad de tener todo en un mismo lugar, el ahorro de tiempo y reducir el estrés de localizar todo el material.
www.genetic.ticareimplants.com/tienda/
Nuevos conceptos de envasado para CAD/CAM y DISC de VITA

Los bloques CAD/CAM de VITA se empezarán a suministrar gradualmente en cajas plegables estandarizadas. Mediante esta optimización, se reduce de 12 a 6 el número de variantes de envase. En los envases de DISC, las películas de plástico y los insertos de espuma han sido sustituidos por cartones y semicoquillas de celulosa respetuosos con el medio ambiente, lo cual se traduce en una reducción del volumen de residuos.
https://www.vita-zahnfabrik.com/vita_unternehmen_ es.html
Superficie de implantes C-SLA de Dentis

¡Descubre la revolucionaria tecnología de superficie de implantes C-SLA en Dentis Smart Clean Factory! Reconocida por su estabilidad a largo plazo y aumento del contacto óseo, la innovadora CleanTechTM lleva la superficie SLA a un nuevo nivel de limpieza y seguridad. Visita el blog de Dentis para obtener información y conocimientos profundos sobre esta tecnología de vanguardia y otras innovaciones dentales.
https://dentiseurope.com/
Hyadent BG, un ácido hialurónico de grado quirúrgico


Salugraft Dental presenta el Hyadent BG, un ácido hialurónico de grado quirúrgico, de alto peso molecular, y mezcla de natural y cross-link . Esto lo diferencia de los ácidos hialurónicos presentes en el mercado actual, que son de grado cosmético. Las principales indicaciones del Hyadent BG son dos: como parte del tratamiento Clean&Seal y utilizado en las cirugías de regeneración.
https://salugraftdental.com/wp-content/ uploads/2023/02/AH-cross-linked.pdf
165 Gaceta Dental · N o 366 | Mayo 2024 PRODUCTOS
Nueva línea BEGO Semados®
Esthetic Line
PERFECCIÓN



BEGO presenta la nueva línea de aditamentos protésicos Bego Semados® Esthetic Line que, con su diseño cóncavo, ayudarán al implantólogo a tratar el tejido blando y crear un perfil de emergencia estético en el caso de los implantes de colocación subcrestal. Se ha optimizado el diseño de los componentes protésicos según los conocimientos más avanzados y se ha complementado con una codificación por colores intuitiva y sistemas de impresión digital y analógicos mejorados.
www.bego.com
Vulkan Implants lanza un nuevo servicio de cirugía guiada
Está diseñado para ofrecer a los profesionales odontológicos una solución integral. Con dos planes disponibles, la propuesta de tratamiento es 100% personalizada con un servicio 360 o que incluye el elemento diferenciador: la prótesis definitiva.


www.vulkanimplants.com
Analog Pro, el nuevo scan analog de Archimedes

Tiene dos funciones: es la réplica del flujo digital, para modelos de impresión 3D; y es una réplica escaneable para uso clínico, lo que permite realizar la transferencia del perfil de emergencia. A diferencia de otras soluciones, Analog Pro presenta un tratamiento especial en la superficie para un mejor escaneado. Además, cada conexión se identifica mediante marcado láser.
Meyer 3D Pro de P-Ortho

Mayer 3D Pro recoge los datos orales en una sola exploración y reconstruye todos los aspectos de las imágenes en alta resolución, tal como se requiere para un diagnóstico clínico preciso.
https://p-orthodigital.com/meyer/?lang=es
Steam tube, box de vaporización inteligente de Renfert

Como box de vaporización inteligente, Steam tube garantiza un lugar de trabajo limpio. Al limpiar los objetos de trabajo con vapor, el box, gracias a su diseño innovador, captura las impurezas y las partículas de suciedad sueltas. De este modo, los residuos procedentes de la vaporización del objeto ya no se esparcen sin rumbo en las proximidades de la vaporeta. Además, Steam tube no solo protege las piezas pequeñas más delicadas, sino que también mejora la visión del objeto que se está trabajando gracias a la evacuación controlada del vapor.
https://www.renfert.com/es-es/
Clearfil Majesty Es-2 Universal


https://www.archimedespro.com



Un sistema inteligente e indicado para la mayoría de los casos que atiende diariamente. Es fácil de usar, con 1 color posterior y 2 colores anteriores, sin necesidad de bloqueador. También proporciona un brillo natural y duradero después de un pulido sencillo. La estética es excelente y los resultados duraderos.



https://www.kuraraynoritake.eu/es/clearfil-majestyes2-universal
166 Gaceta Dental · N o 366 | Mayo 2024 PRODUCTOS
LA SIMPLIFICACIÓN INTELIGENTE con tejidos naturales circundantes, actuando sobre control de translucidez opacidad. Opciones color para las
Tratamiento del disilicato de litio: estética y eficacia para técnicos dentales
Organiza: GC Ibérica Dental.
Dictante: Dirk Galle.
Fecha y lugar: 17 y 18 de junio de 2024 en Leuven (Bélgica).
Teléfono e e-mail: 916 364 340 - formacion.spain@gc.dental https://www.gc.dental/europe/es-ES



Protocolos de terminación para materiales CAD/CAM
Organiza: VITA.
Imparte: Bárbara Calero.
Fecha y lugar: 14 y 15 de junio de 2024 en Santiago de Compostela. Teléfono e e-mail: 672 067 945 - R.miranda@vita-Zahnfabrik.com https://www.vita-zahnfabrik.com/
Formación Exocad para clínicas dentales
Organiza: BEGO Iberia.
Imparte: Pere Colomina.
Fecha y lugar: consultar fechas para Madrid y Barcelona. Teléfono e e-mail: 933 720 325 - begoiberia@bego.com https://bego-iberia.mailchimpsites.com/


Máster en Dirección y Transformación de clínicas dentales
Organiza: Instituto de Desarrollo Odontológico Digital (IDEOD). Dirigen: Sofía Solano, Pedro de Ahumada y Úrsula Barroso.
Fecha y lugar: de octubre de 2024 a junio de 2025. Doble convocatoria. Sevilla/Madrid. Teléfono e e-mail: 659 862 391 - info@institutoideo.es www.institutoideod.es
Alineadores «in-house»: el siguiente paso en la digitalización de tu clínica
Organiza: Ortocervera - Instituto de Ortodoncia.
Imparten: Dres. Isabel Cervera, Alberto Cervera y Mónica Simón. Fecha: comienza en septiembre de 2024. Teléfono: 915 541 029 www.ortocervera.com

Curso de Ortodoncia avanzada
Organiza: Osteógenos.
Imparte: Dr. Peri Colino.
Fecha y lugar: de mayo a noviembre en Madrid. Teléfono e e-mail: 696 962 892 - formacion@osteogenos.com www.osteogenos.com

167 AGENDA
Agenda Gaceta Dental · N o 366 | Mayo 2024
Curso de incrustaciones
Organiza: GC Ibérica Dental.
Imparte: Dr. Carlos López Suárez.
Fecha y lugar: 14 de junio de 2024 en Madrid. Teléfono e e-mail: 916 364 340 - formacion@spain.gceurope.com https://europe.gc.dental/es-ES/education/courses

Aplicación

clínica del avance mandibular para el tratamiento de la AOS
Organiza: Ortocervera - Instituto de Ortodoncia. Imparte: Dra. Mónica Simón Pardell. Fecha: libre elección de fecha de celebración.
Teléfono: 915 541 029 www.ortocervera.com
Estética anterior con resinas compuestas
Organiza: RTC-CEPI y Ultradent.
Dictante: Rafael Beolchi.
Fecha y lugar: 21 y 22 de junio de 2024 en Oporto (Portugal).
Teléfono e email: +351 962 014 741 - info@rtc-cepi.com https://rtc-cepi.com/formacao-dentista/estetica-anterior-com-resinas-compostas/


Prótesis completas con Vitapan Excell & Lingform
Organiza: VITA.
Imparte: Dr. José Mª Fonollosa. Fecha y lugar: 18 y 29 de junio de 2024 en Oporto. Teléfono e e-mail: +351 966 235 366 - l.pinela@vita-zahnfabrik.com https://www.vita-zahnfabrik.com/
Curso de «Ortodoncia más allá de los límites»
Organiza: Osteógenos.
Imparte: Dra. Patricia Vergara. Fecha y lugar: 12 de junio en Barcelona y 17 de octubre en Madrid. Teléfono e e-mail: 696 962 892 - formacion@osteogenos.com www.osteogenos.com


Formaciones avanzadas en Ortodoncia invisible
Organiza: QuickSmile.
Imparte: Dr. Manuel Poveda e invitados. Fecha y lugar: consultar en web. Teléfono e e-mail: 911 178 128 – formaciones@quicksmile.es https://doctores.quicksmile.es/formaciones/
168 AGENDA Gaceta Dental · N o 366 | Mayo 2024

Curso «Aplicaciones intraorales y extraorales del ácido hialurónico»
Organiza: Osteógenos.
Imparte: Dr. Juan Carrión.
Fecha y lugar: 14 y 15 de junio de 2024 en Madrid. Teléfono e e-mail: 696 962 892 - formacion@osteogenos.com www.osteogenos.com


Conceptos actuales en el tratamiento rápido de implantes, injertos óseos y manejo de tejidos blandos
Organiza: Beide.
Imparte: Dr. Khoury.
Fecha y lugar: 24 y 25 de mayo de 2024 en Madrid. https://bedentalexpert.com/cursos/conceptos-actuales-en-el-tratamiento-rapidocon-implantes-injertos-oseos-y-manejo-de-tejidos-blandos/
VITA Vionic Dent Disc y el arte gingival
Organiza: VITA/Dentival.
Imparte: Jorge Reyes. Fecha y lugar: 14 y 15 de junio en Alboraia (Valencia).
Teléfonos: 963 911 597 - 687 953 389 https://www.vita-zahnfabrik.com/


Máster en Ortodoncia y Ortopedia Dentofacial
Organiza: Instituto de Desarrollo Odontológico Digital (IDEOD) - Universidad Antonio de Nebrija Formación (NFC). Dirige: Dr. Enrique Solano. Fecha y lugar: 3 años a tiempo parcial. Inicio en septiembre de 2024. Sevilla. Acreditaciones: 180 ECTS. Certificación Invisalign incluida. Teléfono e e-mail: 659 862 391 - info@institutoideo.es www.institutoideod.es
Taller «Impresión 3D: de la cirugía guiada a la prótesis»
Organiza: SEPA.
Imparte: Pere Colomina y el Dr. Carlos León. Fecha y lugar: 30 de mayo de 2024 en SEPA Bilbao. https://go.sepa.es/3THIdyD


¿Te gustaría aprender o mejorar tu nivel de FOTOgrafía Dental?

Organiza: Fernando Rey FOTOgrafía Dental. Cursos personalizados grupales o individuales. Cursos tanto de nivel clínico como avanzado. Ofrecen diseño de presentaciones, conferencias y comunicaciones modernas, elegantes y dinámicas. www.fotografiadentalfr.com/
170 AGENDA Gaceta Dental · N o 366 | Mayo 2024
Congreso Internacional de Odontología de Intervención Mínima
Organiza: Sociedad Internacional de Odontología de Intervención Mínima. Fecha y lugar: 29 de junio de 2024 en Madrid. E-mail: info@misociety.dental www.miscongress2024.com

VITA Lumex AC Alta Estética Avanzada
Organiza: VITA.
Imparte: Ignasi Rosello.
Fecha y lugar: 24 y 25 de mayo de 2024 en Manresa (Barcelona). Teléfono e e-mail: 678 774 481 - p.hurtado@vita-zahnfabrik.com https://www.vita-zahnfabrik.com/
Diploma de Experto en Odontopediatría Clínica
Organiza: Instituto de Desarrollo Odontológico Digital (IDEOD) - Universidad Antonio de Nebrija Formación (NFC).
Dirige: Dra. Asunción Mendoza.
Acreditaciones: 20 ECTS.
Fecha y lugar: 9 meses a tiempo parcial. Inicio en septiembre de 2024. Sevilla. Teléfono e e-mail: 659 862 391 - info@institutoideo.es www.institutoideod.es

Programa modular médico-quirúrgico
Organiza: Doceo Dental Executive Education.


Imparten: Profesores Darcio Fonseca, Miguel Murúa, Andrés Blanco, Ángel MartínezSahuquillo, Isabel Gallardo, Pablo Gutiérrez, Pedro Lázaro y Emilio Rodríguez. Fecha y lugar: 24 y 25 de mayo y 7 y 8 de junio de 2024 en Madrid. Teléfono e e-mail: 681 273 415 - secretaria@doceodental.com www.doceodental.com
Cirugía plástica reconstructiva alrededor de dientes e implantes con una matriz dérmica acelular Novomatrix™
Organiza: SEPA y BioHorizons Camlog.
Fecha y lugar: 31 de mayo de 2024 en SEPA Bilbao. Teléfono: 917 131 084 https://www.biohorizonscamlog.es/es/formacion

Curso de alineadores
Organiza: Ortocervera - Instituto de Ortodoncia.

Imparten: Dra. Isabel Cervera, Dr. Alberto Cervera y Dra. Mónica Simón.
Fechas: 13, 14 y 16 de junio de 2024 (primer módulo) y del 4 al 6 de julio de 2024 (segundo módulo).
Teléfono: 915 541 029 www.ortocervera.com
AGENDA
Gaceta Dental · N o 366 | Mayo 2024 171
Curso de alineadores para higienistas dentales
Organiza: Instituto de Desarrollo Odontológico Digital (IDEOD) - CEU Fundación San Pablo Andalucía.
Dirige: Dra. Beatriz Solano.
Acreditaciones: 4 ECTS.
Fecha y lugar: del 9 al 11 de mayo de 2024. Sevilla.
Teléfono e e-mail: 659 862 391 - info@institutoideo.es www.institutoideod.es


Curso de armonización orofacial en el tercio facial inferior
Organiza: Osteógenos.
Imparte: Dra. Cristina Marín.
Fecha y lugar: 21 de junio de 2024 en Granada.
Teléfono e e-mail: 696 962 892 - formacion@osteogenos.com www.osteogenos.com
Ciclo formativo patrocinado por Ticare
Organiza: Ticare.
Imparten: distintos profesionales y líderes de opinión del sector.
Fecha y lugar: durante todo el año por puntos de la geografía española. Consultar en la web.
www.ticareimplants.com/formacion


Prevención y tratamiento de las complicaciones estéticas alrededor de implantes dentales
Organiza: SEPA y BioHorizons Camlog. Fecha y lugar: 31 de mayo de 2024 en SEPA Bilbao. Teléfono: 917 131 084 https://www.biohorizonscamlog.es/es/formacion
VIII Jornadas Multidisciplinares de Salud Oral
Organiza: Colegio Profesional de Higienistas Dentales de Madrid. Profesorado: Francisco J. López, Francisco M. Rodríguez, Óscar Camejo, Sonia Miranda, María Regla Carro y Gerardo Gómez-Moreno. Fecha y lugar: 22 de junio de 2024 en Madrid. https://colegiohigienistasmadrid.org/masinfo.asp?idcurso=557



Máster Propio en Cirugía Bucal, Implantología Bucofacial y Periodoncia
Organiza: Universidad CEU Cardenal Herrera. Fecha y lugar: de septiembre de 2024 a julio de 2026 en Alfara. Teléfono e e-mail: 961 369 009 - postgrados@uchceu.es https://www.uchceu.es/estudios/posgrado/master-propio-cirugia-bucalimplantologia-bucofacial
172
AGENDA Gaceta Dental · N o 366 | Mayo 2024
CURSOS / POSTGRADOS / MÁSTERES



Consulta condiciones y contrata:

Anuncia tu curso, máster o postgrado en la guía que batió récords de audiencia en 2023
Una herramienta clave para que odontólogos, higienistas y protésicos definan su futuro gacetadental.com/formacion

Ayuda a los profesionales del sector a triunfar en su carrera
ANA SANTAMARÍA ana@gacetadental.com
MARTA PÉREZ marta@gacetadental.com
Impulsa:
648 234 766
630 369 535 MANUELA BINOTTI mbinotti@gacetadental.com 650 587 681
Curso práctico de estratificación con composite
Organiza: GC Ibérica Dental.
Dictante: Dra. Simone Moretto.
Fecha y lugar: 30 y 31 de mayo de 2024 en Leuven (Bélgica).
Teléfono e e-mail: 916 364 340 - formacion.spain@gc.dental https://europe.gc.dental/es-ES/education/courses


Curso de Periodoncia para higienistas dentales
Organiza: Instituto de Desarrollo Odontológico Digital (IDEOD) - CEU Fundación San Pablo Andalucía.
Dirigen: Dra. Patricia Solano, Dra. Estefanía Laguna y Dra. María Mínguez. Acreditaciones: 5 ECTS.
Fecha y lugar: 10 de mayo de 2024. Sevilla.
Teléfono e e-mail: 659 862 391 - info@institutoideo.es www.institutoideod.es
Implantes inmediatos. Reduciendo los tiempos de tratamiento de una manera predecible
Organiza: BioHorizons Camlog.
Fecha y lugar: 7 de junio de 2024 en Madrid.
Teléfono: 917 131 084
https://form.jotform.com/biohorizons/The-Spot-Study-Club-Madrid-3



Elevación de seno transcrestal atraumática. Nuevas técnicas, rápidas y sencillas
Organiza: Salugraft.
Ponente: Dr. Javier Barberá.
Fecha y lugar: 30 de mayo de 2024 en SEPA Bilbao. https://salugraftdental.com/curso/taller-sepa-elevacion-seno-transcrestalatraumatica-barbera/
Curso de armonización orofacial y estética del tercio facial inferior
Organiza: Osteógenos.
Imparten: Dras. Carmen Martín y Mariví Álvarez.
Fecha y lugar: 7 y 8 de junio en Barcelona. Teléfono e e-mail: 696 962 892 - formacion@osteogenos.com www.osteogenos.com


Máster Universitario en Ortodoncia y Ortopedia Dentofacial
Organiza: Universidad CEU Cardenal Herrera. Fecha y lugar: de septiembre de 2024 a julio de 2026 en Alfara. Teléfono e e-mail: 961 369 009 - postgrados@uchceu.es https://www.uchceu.es/estudios/posgrado/master-universitario-ortodonciaortopedia-dentofacial
AGENDA
Gaceta Dental · N o 366 | Mayo 2024 174
Cubrimiento de recesiones sobre dientes e implantes con aplicación de la Técnica VISTA
Organiza: Advanced Esthetic Seminars y BioHorizons Camlog. Fecha y lugar: 15 de junio de 2024 en Bilbao.
Teléfono: 917 131 084 https://www.biohorizonscamlog.es/es/formacion


Técnico de Ortodoncia para higienistas dentales
Organiza: Instituto de Desarrollo Odontológico Digital (IDEOD) - CEU Fundación San Pablo Andalucía.
Dirige: Dr. Enrique Solano. Fecha y lugar: Comienza en noviembre de 2024 en Sevilla. 14 ECTS. Teléfono e e-mail: 659 862 391 - info@institutoideo.es www.institutoideod.es
Open Day de Osteógenos
Organiza: Osteógenos.
Imparte: Dr. Abdelsalam Elaskary. Fecha y lugar: 29 de junio de 2024 en Madrid. Teléfono e e-mail: 914 133 714 - info@osteogenos.com www.osteogenos.com


Experto en Ortodoncia Funcional, Aparatología Fija y Alineadores
Organiza: Ortocervera - Instituto de Ortodoncia.
Imparten: Dr. Alberto Cervera, Dra. Isabel Cervera y Dra. Mónica Simón. Fecha: comienza el 26 de septiembre de 2024. Teléfono: 915 541 029 www.ortocervera.com
Máster de Formación Permanente en Cirugía Bucal
Organiza: Universidad CEU Cardenal Herrera.
Fecha y lugar: de septiembre 2024 a julio de 2025 en Alfara. Teléfono e e-mail: 961 369 009 - postgrados@uchceu.es https://www.uchceu.es/estudios/posgrado/master-formacion-permanente-cirugiabucal


Cursos de introducción al Método Bioclear
Organiza: Akura. En el mundo actual de implantes y restauraciones, los composites directos pueden ofrecer una alternativa mínimamente invasiva convincente que satisfará las necesidades de los pacientes y superará sus expectativas. El Método Bioclear permite crear resultados predecibles, repetibles y naturales utilizando composite. https://akura-medical.com/bioclear/
175 AGENDA
Gaceta Dental · N o 366 | Mayo 2024
Cursos de formación CAD/CAM
Organiza: CNC Dental.
Fecha y lugar: a consultar en la web.
Teléfono: 925 264 427
https://cncdental.es/




Postgrado de Especialización en Endodoncia
4ª Edición
Organiza: Fundació Lluís Alcanyís – Universitat de València. Dirigen: Dr. Leopoldo Forner Navarro y Dr. Adrián Lozano Alcañiz. Fecha y lugar: comienza el 17 de octubre de 2024 y finaliza el 22 de octubre de 2027 en Valencia.
Teléfono e e-mail: 963 395 037 - formaciofla@uv.es
https://go.uv.es/32cP3xL
Agenda de cursos de Salugraft
Organiza: Salugraft.
Imparten: Dr. Javier Barberá, Dr. Xavi Costa, Dr. Pablo García y Dr. Pier Gallo. Fechas y lugares: 17 de mayo (Zaragoza), 24 de mayo (Barcelona), 25 de Mayo (A Coruña) y 30 de mayo (Bilbao).
https://salugraftdental.com/cursos/

Curso

MZM edición 2024: Reconstrucción vertical de tejidos blandos, papilas y periimplantitis
Organiza: Dentariel con la colaboración de BioHorizons Camlog.
Fecha y lugar: 12 de septiembre de 2024 en Madrid.
Teléfono: 917 131 084
https://www.biohorizonscamlog.es/es/formacion
9ª edición del Curso de gestión de clínica dental
Organiza: Colegio Profesional de Higienistas Dentales de Madrid.
Profesorado: José Luis Gómez, Almudena Rodríguez, Antonio Gosálvez, Lola Sánchez, Luis Miguel Sacristán, Sol Archanco, Javier López y César Díaz.
Fecha y lugar: desde el 21 de septiembre al 14 de diciembre de 2024 en Madrid. https://colegiohigienistasmadrid.org/masinfo.asp?idcurso=563



Curso intensivo de férulas de descargas
Organiza: Ortoplus.
Ponente: Dr. Eduardo Vázquez.
Fecha y lugar: 8 de junio de 2024 en Málaga. www.ortoplus.es/cursos
176176 AGENDA
Gaceta Dental · N o 366 | Mayo 2024
Manejo de tejidos blandos para la regeneración ósea
horizontal y vertical
Organiza: BioHorizons Camlog.
Fecha y lugar: 27 de septiembre de 2024 en Madrid. Teléfono: 917 131 084 https://www.biohorizonscamlog.es/es/formacion


I Simposio Salugraft

Organiza: Salugraft. Fecha y lugar: 23 de noviembre de 2024 en Madrid. Este evento científico-benéfico contará con los mejores expertos en regeneración del país.
https://salugraftdental.com/curso/simposio-salugraft/
Postgrado en Implantología
Organiza: CEPUME - Universidad de Alcalá. Dirige: Dr. José Vicente Sanz. Fecha y lugar: comienza el 4 de octubre de 2024 y finaliza el 22 de junio de 2025 en Madrid.
Teléfono e e-mail: 648 418 072 - info@cepume.com https://cepume.com/


DWS Simposio Internacional de Implantología
Organiza: Dentis y GDIA.
Fecha y lugar: del 24 al 28 de mayo en Bangkok. Teléfono: 910 726 227 www.dentiseurope.com
Curso «Estética blanca y rosa»
Organiza: Kuraray Noritake.
Imparte: Ainhoa Fernández Cid.
Fecha y lugar: 11 de mayo de 2024 en Madrid. Teléfono e e-mail: 634 453 983 - dental-iberia@kuraray.com https://www.kuraraynoritake.eu/es/newsroom/curso-practico-estetica-blanca-y-rosa




Estancias Monje-Ticare



Organiza: Ticare y el Dr. Alberto Monje. Fechas y lugar: del 1 al 3 de julio de 2024 en CICOM Monje (Badajoz). Durante la formación se abordan temas como Implantología inmediata y diferida, regeneración ósea simultánea o diferida, implantes en zona estética con injerto óseo y de tejido conectivo o manejo de la periimplantitis. www.ticareimplants.com/formacion
177 AGENDA
Gaceta Dental · N o 366 | Mayo 2024
Calendario de congresos
MAYO 2024
SEOP Girona del 9 a l 11
SEGER Barcelona del 9 a l 11
SEDCYDO
SECOM
SEPA
JUNIO 2024
SEDO
SEPTIEMBRE 2024
OCTUBRE 2024 HIDES
SEPES
V Congreso Internacional de Prótesis Dental Val encia día s 18 y 19
AEDE
NOVIEMBRE 2024
178 Gaceta Dental · N o 366 | Mayo 2024
CALENDARIO DE CONGRESOS
Sev illa del 1 6 al 18
CyC Sal amanca del 1 6 al 18
Bil bao del 29 al 1
Gra
del 5 a l 8
n Canaria
FDI Estambul del 1 2 al 15
A Cor uña día s 13
14 SEI Vig o
26
28
Jornadas del Club Tecnológico Dental
y
del
al
Ovi
edo día s 4 y 5
Sev illa del 1 0 al 12
Sev illa del 31 al 2
SECIB Girona del 14 al 16 SEOE Val encia día 1 6 ACADEN Gra nada del 1 5 al 17 SEMDES Barcelona
21
23
del
al
Cementación de óxido de circonio fácil y económica.
ZirCAD ®
Cement
- Fácil manejo y rápida limpieza con opción de polimerizado adhesivo.
- Resultados de cementación fiables caso tras caso
- Cementación rentable de la marca de primera calidad en la que confía

ivoclar.com Making People Smile

Ofertas Especiales
HASTA EL 31 DE AGOSTO DE 2024



Clean Head System (Anti-Retorno) • Portafresas Push Button • Rodamientos de Cerámica

MODELO M25 REF. C1027 • Sin Luz • Velocidad Directa 1:1
Spray Simple
Velocidad Máxima: 40.000 min -1
• Para fresas CA (ø2,35)
Clean Head System (Anti-Retorno) • Portafresas Push Button

MODELO M95 REF. C1026
• Sin Luz
• Multiplicador 1:5
• Spray Quattro
• Velocidad Máxima: 200.000 min -1
• Para fresas FG (ø1,6)
POTENCIA 26W




• Con Luz
• Velocidad Directa 1:1
• Spray Simple

• Velocidad Máxima: 40.000 min -1
• Para fresas CA (ø2,35)


MODELO M95L REF. C1023
• Con Luz
• Multiplicador 1:5
• Spray Quattro
• Velocidad Máxima: 200.000 min -1
• Para fresas FG (ø1,6)


• Clean Head System (Anti-Retorno) • Torque: 26W • Tamaño del Cabezal: ø12,1 x Al 13,3 mm • Velocidad: 325.000~430.000 min -1 • Cuerpo de Acero Inoxidable • Spray de Agua Quattro • Porta-fresas Push Botton • Rodamientos de cerámica • Fácil cambio del cartucho por el propio usuario

M900L REF. P1254 MODELO M25L REF. C1024

Conexión KaVo® MULTIflex® MODELO M900KL REF. P1258







NSK Dental Spain S.A. www.nsk-spain.es C/ Rozabella, 8. Europa Empresarial Edificio Roma | Planta baja, Oficina A 28290 - Las Rozas de Madrid, España - tel: +34 91 626 61 28 · fax: +34 91 626 61 32 · e-mail: info@nsk-spain.es
S-Max M S-Max M CONTRA-ÁNGULOS DE ACERO INOXIDABLE TURBINAS DE ACERO INOXIDABLE CON LUZ
•
•
• Rodamientos de Cerámica
•
•
MODELO
Conexión NSK
2
garantía 2 años de garantía OFERTA 1 + 1 OFERTA 1 + 1 OFERTA 1 + 1 2 CONTRA-ÁNGULOS DEL MISMO MODELO 2 CONTRA-ÁNGULOS DEL MISMO MODELO 2 TURBINAS DEL MISMO MODELO M25 M95 M900L M900KL M900L M900KL M25 M95 M25L M95L M25L M95L 649€* 849€* 849€* 1.398€* 1.862€* 1.906€* 849€* 1.049€* 849€* 1.856€* 2.466€* 2.136€*
años de

Ofertas Especiales
HASTA EL 31DE AGOSTO DE 2024
Varios Combi Pro

2 SISTEMAS EN 1
El equipo se compone de:
• Prophy-System Incluye pieza de mano con boquilla de 60º para profilaxis supragingival
• Polvo FLASHpearl (5 sobres de 15 g)
• Ultrasonidos Incluye pieza de ultrasonidos Varios2 LUX con luz LED
• Tres puntas: G4, G8 y G16
• Pe dal de control multifuncional para regular la presión de agua y polvo
•Unidad de control



Motor Ultrasónico de Última Generación Exclusivo de
Escanee el código QR para más información
Dispositivo para Tratamiento Periodontal
MODELO Varios Combi Pro REF. Y1002843

Tratamiento Periodontal Subgingival MODELO Kit Perio REF. Y1003042
2ª Pieza de Mano · Escarificador Ultrasónico MODELO Varios2 Lux REF. E351050
4.999€*
8.841€*



DISPOSITIVO PARA TRATAMIENTO PERIODONTAL





* Los precios no incluyen iva. Ofertas limitadas hasta el 31 de agosto de 2024


o hasta fin de existencias.
¡Síguenos! NSK Dental Spain NSK Dental Spain NSK Dental Spain
Prótesis Digital VITA: Alcanza el siguiente nivel

Disco de composite para la confección de prótesis removibles parciales y totales.
• Resistente a la abrasión, para garantizar la durabilidad de los dientes protésicos
• Manipulación sencilla y fácil pulido
• Estética multicolor natural


VITA VIONIC® DENT DISC multiColor








¡Descubre más! Línea de atención al cliente: +34 722 368 128





















































































































































 Figuras 4-8.
Figuras 4-8.













































 Organiza:
Impulsa:
Organiza:
Impulsa:









 Figura 3. Visión intraoral oclusal mandibular.
Figura 4. Visión intraoral frontal.
Figura 1. Visión intraoral oclusal maxilar.
Figura 2. Visión lateral izquierda intraoral.
Figura 7. Escaneado intraoral maxilar con Dexis IS3700.
Figura 8. Escaneado intraoral mandibular con Dexis IS3700.
Figura 5. Visión extraoral lateral sonrisa.
Figura 3. Visión intraoral oclusal mandibular.
Figura 4. Visión intraoral frontal.
Figura 1. Visión intraoral oclusal maxilar.
Figura 2. Visión lateral izquierda intraoral.
Figura 7. Escaneado intraoral maxilar con Dexis IS3700.
Figura 8. Escaneado intraoral mandibular con Dexis IS3700.
Figura 5. Visión extraoral lateral sonrisa.





















 Figura 23. Férula quirúrgica inferior.
Figura 24. Fresado guiado con férula y cucharilla.
Figura 20. Extracciones dentales.
21. Conservación
Figura 22. Férula quirúrgica superior.
Figura 25. Inserción de implante RSX de Bego a través de férula quirúrgica.
Figura 27. Conexión de pilar angulado multiplus sobre implante.
Figura 26. Implante insertado en lecho a través de férula quirúrgica.
Figura 28. Muestra del perfecto paralelismo tras la colocación de pilares angulados multiplus.
Figura 29. ScanBody sobre pilares transepiteliales.
Figura 23. Férula quirúrgica inferior.
Figura 24. Fresado guiado con férula y cucharilla.
Figura 20. Extracciones dentales.
21. Conservación
Figura 22. Férula quirúrgica superior.
Figura 25. Inserción de implante RSX de Bego a través de férula quirúrgica.
Figura 27. Conexión de pilar angulado multiplus sobre implante.
Figura 26. Implante insertado en lecho a través de férula quirúrgica.
Figura 28. Muestra del perfecto paralelismo tras la colocación de pilares angulados multiplus.
Figura 29. ScanBody sobre pilares transepiteliales.




 Figura 34. Rehabilitación superior impresa en resina
Bego VarseoSmile TriniQ® lista para atornillar. Se han anulado de la oclusión aquellos implantes que no obtuvieron una estabilidad primaria superior a 35 N/cm2
Figura 31. Escaneado intraoral postcirugía. Figura 32. Rehabilitación recién impresa a través de impresora Varseo XS con resina Bego VarseoSmile TriniQ®.
Figura 33. Ajuste pasivo entre aditamentos protésicos y la rehabilitación impresa.
Figura 34. Rehabilitación superior impresa en resina
Bego VarseoSmile TriniQ® lista para atornillar. Se han anulado de la oclusión aquellos implantes que no obtuvieron una estabilidad primaria superior a 35 N/cm2
Figura 31. Escaneado intraoral postcirugía. Figura 32. Rehabilitación recién impresa a través de impresora Varseo XS con resina Bego VarseoSmile TriniQ®.
Figura 33. Ajuste pasivo entre aditamentos protésicos y la rehabilitación impresa.

































































































































 Figura 3. Filtro de fluorescencia.
Figura 4. Filtro antiglare (antibrillo).
Figura 5. Filtro naranja.
Figura 3. Filtro de fluorescencia.
Figura 4. Filtro antiglare (antibrillo).
Figura 5. Filtro naranja.














































 Figura 2. Intraoral preoperatoria.
Figura 3. Preoperatoria sin la prótesis completa.
Figura 4. Intraoperatoria yuxtaósea Custom Implants.
Figura 2. Intraoral preoperatoria.
Figura 3. Preoperatoria sin la prótesis completa.
Figura 4. Intraoperatoria yuxtaósea Custom Implants.

























































 Figura 6. Prótesis realizada preoperatoriamente.
Figura 7. Resultado intraoperatorio con la prótesis provisional.
Figura 8. Ajuste provisional prefabricado.
Figura 9. Revisión al mes.
Figura 10. Escaneado del Trios para la parte inferior.
Figura 11. Escaneado con Trios parte inferior. Carga inmediata.
Figura 12. Detalle escaneado. Carga inmediata inferior.
Figura 6. Prótesis realizada preoperatoriamente.
Figura 7. Resultado intraoperatorio con la prótesis provisional.
Figura 8. Ajuste provisional prefabricado.
Figura 9. Revisión al mes.
Figura 10. Escaneado del Trios para la parte inferior.
Figura 11. Escaneado con Trios parte inferior. Carga inmediata.
Figura 12. Detalle escaneado. Carga inmediata inferior.























































 Figura 14. Conexiones MU carga inmediata inferior.
Figura 15. Prótesis inmediata tres horas después.
Figura 16. Colocación.
Figura 17. Colocación.
Figura 18. Tornillo MU.
Figura 19. Prótesis inmediata colocada.
Figura 20. Detalle.
Figura 14. Conexiones MU carga inmediata inferior.
Figura 15. Prótesis inmediata tres horas después.
Figura 16. Colocación.
Figura 17. Colocación.
Figura 18. Tornillo MU.
Figura 19. Prótesis inmediata colocada.
Figura 20. Detalle.























































 Figura 22. Vista lateral.
Figura 23. Vista lateral.
Figura 24. Sonrisa inmediata.
Figura 25. Rx postoperatoria.
Figura 26. Control gingival yuxtaóseo.
Figura 27. Control inferior.
Figura 28. Control inferior tres meses.
Figura 22. Vista lateral.
Figura 23. Vista lateral.
Figura 24. Sonrisa inmediata.
Figura 25. Rx postoperatoria.
Figura 26. Control gingival yuxtaóseo.
Figura 27. Control inferior.
Figura 28. Control inferior tres meses.























































 Figura 30. Prótesis definitiva superior.
Figura 31. Vista interna de la prótesis definitiva superior.
Figura 32. Colocación.
Figura 33. Colocación.
Figura 34. Prótesis colocada.
Figura 35. Vista oclusal.
Figura 36. Situacion inferior en la colocación definitiva.
Figura 30. Prótesis definitiva superior.
Figura 31. Vista interna de la prótesis definitiva superior.
Figura 32. Colocación.
Figura 33. Colocación.
Figura 34. Prótesis colocada.
Figura 35. Vista oclusal.
Figura 36. Situacion inferior en la colocación definitiva.

Figura 1. Etiología de la caries.
Figura 1. Etiología de la caries.